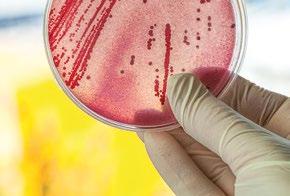
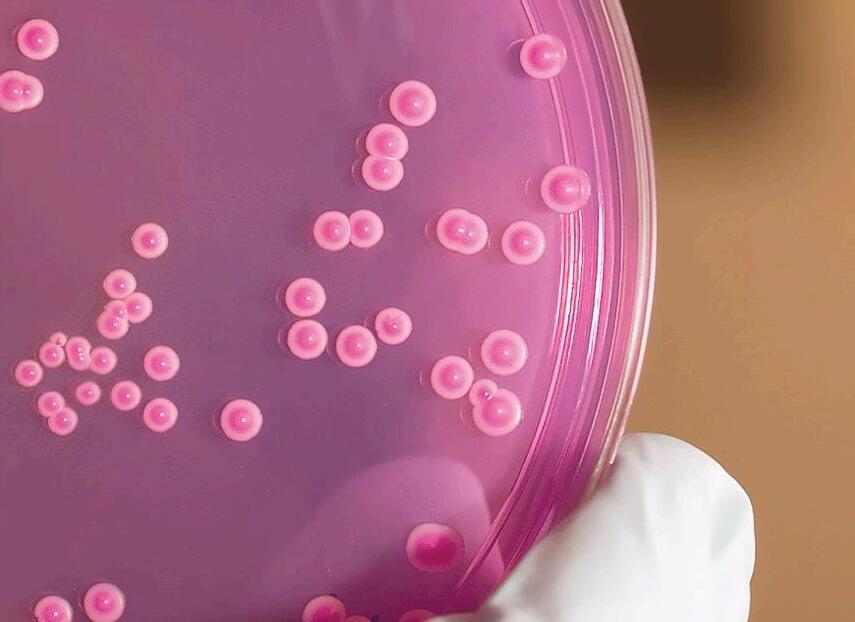

ANÁLISIS DE LA
EVOLU CIÓN DE LAS
RECOMENDACIONES
NUTRICIONALES PARA REPRODUCTORAS PESADAS




![]()







Por su demostrada eficacia y seguridad, LIDERFEED es el ÚNICO GENUINO PROMOTOR DE CRECIMIENTO español aprobado por EFSA para la UE

(Register of Feed Additives pursuant to Regulation (EC) Nª 1831/2003 – Annex I.List of Additives https://ec.europa.eu/food/sites/food/files/safety/docs/ animal-feed_additives_eu-register_1831-03.pdf) Plaza García Lorca, 15 Bajos Tfno: (+34) 977 552316 43006 Tarragona (Spain) email: lidervet@lidervet.com
El 2024 ha sido un año de desafíos para el sector ganadero, tanto en España como en Europa. A lo largo de estos meses, los productores han tenido que adaptarse a cambios importantes que han puesto a prueba su capacidad para encontrar soluciones rápidas y efectivas.
La mejora de las prácticas de manejo sigue siendo una de las tareas pendientes para mejorar los rendimientos productivos. En este sentido, la amenaza constante de patologías que se han extendido durante los últimos años ha supuesto un esfuerzo adicional al sector.
La sostenibilidad ha sido otra protagonista este año. Las exigencias para reducir la huella de carbono y la deforestación, tanto a nivel legislativo como por parte de los consumidores, se presentan como un reto que el sector debe considerar de cara al futuro.
Limitar los efectos provocados por la volatilidad de los mercados de materias primas, así como la incertidumbre generada por diferentes conflictos internacionales, deben ser una prioridad para evitar que la espada de Damocles ponga en jaque a nuestra producción.


Para 2025, más que nunca, la tecnología, la innovación y la búsqueda de alternativas deberán ser nuestras aliadas para encontrar la receta más adecuada que permita equilibrar la productividad y la calidad en la fabricación de piensos con la responsabilidad medioambiental.
A pesar de todos estos retos, el sector ganadero ha demostrado una gran capacidad de adaptación y un espíritu de superación constante. De cara a 2025, seguiremos trabajando en mejoras en materia de nutrición, genética y digitalización de las granjas para ser más eficientes y sostenibles, siempre mirando al futuro con optimismo y con la voluntad de seguir creciendo juntos.
EDITOR
GRUPO DE COMUNICACIÓN AGRINEWS S.L.
PUBLICIDAD
Laura Muñoz +34 629 422 552 laura@mediatarsis.com
Luis Carrasco +34 605 09 05 13
lc@agrinews.es
DIRECCIÓN TÉCNICA
José Ignacio Barragán (aves)
Guillermo Fondevila (porcinos)
Lourdes Cámara (porcinos)
Fernando Bacha (rumiantes)
COORDINACIÓN TÉCNICA
Facundo Apecetche
REDACCIÓN
Osmayra Cabrera
Daniela Morales
Amanda Abalo
COLABORADORES
Juan Acedo-Rico (Consultor)

Dra. Lourdes Cámara y Dr. Guillermo Fondevila
Directores técnicos nutriNews España. Sección porcina.
Joaquim Brufau (IRTA)
Lorena Castillejos (SNiBA)
Carlos De Blas (UPM)
Gonzalo Glez. Mateos (UPM)
Xavier Mora (Consultor)
Edgar O. Oviedo-Rondón
Alba Cerisuelo (CITA-IVIA)
Carlos Fernández (UPV)
ADMINISTRACIÓN
Mercè Soler
Tel: +34 93 115 44 15 info@grupoagrinews.com www.nutrinews.com
Precio de suscripción anual: España 30 €
Extranjero 90 €
GRATUITA PARA FABRICANTES DE PIENSO, EMPRESAS DE CORRECTORES Y NUTRÓLOGOS
Depósito Legal Nutrinews B-17990-2015
Impreso - ISSN 2696-8053
Digital - ISSN 2696-8045
EDICIÓN TRIMESTRAL
Alba Cerisuelo
Investigadora en Alimentación
Animal (IVIA)
Grupo PH-Albio: 35 años de innovación en salud y nutrición animal 14
Complejos enzimáticos de origen fúngico: Una revolución constante
Meryem El Kissi
Product Manager, Departamento
Marketing Técnico de Andrés Pintaluba
Ficha de materia prima: Melazas 20
Efectos nocivos de los alfagalactósidos de la soja en alimentación animal, y cómo revertirlos
P. Martín Atance, J. Estévez & S. Carné
ITPSA, Departamento Técnico y de Innovación
Tecnología Jefo Matrix
Marine Dewez
Ph.D. Poultry ReproductionDevelopment & Deployment Manager, Jefo
Dietas isoproteicas con diferente concentración energética: efectos sobre los rendimientos productivos y calidad de la canal en cerdos en cebo
Dra. Lourdes Cámara Universidad Politécnica de Madrid
Gerente técnico de porcino para el sur de Europa en Novus International 36
El uso de grasas oxidadas en la alimentación porcina: riesgos y consideraciones (Parte 2/3)
Gerardo Ordaz Ochoa, María
Alejandra Pérez Alvarado, Luis Humberto López Hernández
Centro Nacional de Investigación Disciplinaria en Fisiología y Mejoramiento Animal, INIFAP
Manejo de lechones pequeños: ¿Cómo evitar llegar al sacrificio?
Dr. Yron Manaig I+D de Animine
Impacto del destete y el estrés en el lechón
Departamento Técnico Biocidas ZIX®

El ajuste de la proporción ideal de aminoácidos y lisina mejora el estado inmunológico y el rendimiento de los cerdos en crecimiento ante problemas de salud
John K. Htoo1 , Graziela Alves da Cunha Valini2 , Luciano Hauschild2 1Evonik Operations GmbH, Alemania, 2Universidad Estadual Paulista (Unesp), Brasil
Modulación de la microbiota intestinal en lechones
Roberto Barea
80
Suplementación nutricional de precisión con probióticos de levadura para mejorar la calidad de los lechones
Olivier Merdy1 y Laia Batet 2
1Global Program Manager Swine Phileo by Lesaffre.
2Técnico Comercial Porcino España y Portugal Phileo by Lesaffre
86
Estrés y calidad de carne en producción porcina: ¿cómo funciona?
Phodé Animal Care
92
Análisis de la evolución de las recomendaciones nutricionales para reproductoras pesadas
Dr. Luis Tavares
Director de Nutrición de Racentro (Portugal)
104
Natupulse TS: máxima estabilidad y eficiencia para el éxito
Elena Moreno En representación del equipo técnico de enzimas de BASF Nutrición Animal
108
Mejoras en la sinergia de la eficiencia energética en aves
Equipo técnico IFF
114
LECIFEED®, una fuente de energía para ahorrar costes en fórmula, ya disponible en España y Portugal
Equipo técnico Marvesa Oils and Fats
120
L-metionina: una fuente de metionina altamente bioeficiente en pollos
Adaptado de Lotte Stokvis et al., 2024, Departamento Técnico de Quimidroga SA.
126
Procesos fisiológicos alrededor del destete de los rumiantes (Parte II)
Fernando Bacha Nacoop, S.A.
132
Dietas ricas en almidón: clave para optimizar la calidad de la carne bovina
Equipo técnico AMBiotec
138
Mascotas y Vitamina A: conocimientos esenciales para el bienestar de los animales de compañía
Dr. Yauheni Shastak, Bruno Wernick, Rafael Crouzet y Dr. Álvaro Gordillo
Equipo Técnico BASF
146
Informe MMPP ASFAC

Alba Cerisuelo, Investigadora Alimentación Animal en el IVIA

Las melazas son el subproducto que se obtiene de la industria azucarera a partir de la cristalización final del azúcar, momento en el cual ya no se puede obtener más azúcar por métodos físicos. Las más habituales en alimentación animal son las melazas de remolacha y caña azucarera.
La mayor parte de la melaza de remolacha presente en el mercado es de origen nacional, mientras que la melaza de caña y la de soja son de importación.

En el mercado de materias primas para alimentación animal es posible también encontrar melaza de soja, que se obtiene en el proceso de obtención de concentrados de proteína de soja y cuya composición y sabor es algo diferente a las anteriores.

En general las melazas tienen un aspecto viscoso y oscuro, y consisten en una mezcla compleja que contiene sacarosa, azúcar invertido, sales y otros compuestos solubles en álcali, algunos naturalmente presentes en la materia prima original y otros que se forman durante el proceso de obtención del azúcar, que le confieren un sabor dulce o agridulce en el caso de la melaza de soja.
En piensos, éstas suelen añadirse a dosis bajas como fuente de energía, y para aumentar la consistencia del gránulo y su palatabilidad. Un exceso de este ingrediente puede provocar problemas digestivos, por su desequilibrio electrolítico, y metabólicos, como cetosis en rumiantes.
En el caso de la melaza de soja, esta se ha utilizado principalmente para la fermentación en la producción de bioetanol y ácido láctico, entre otros. Su uso en alimentación animal es menos frecuente, pero sí existen estudios que indican que su uso en rumiantes tiene un elevado potencial.
En la Tabla 1 se muestran las materias primas clasificadas como melazas que se recogen en el Catálogo de materias primas (Reglamento UE 68/2013). Estas materias primas se clasifican dentro de los grupos 2, 4 y 7 referentes a “Semillas de oleaginosas, frutos oleaginosos y sus productos derivados”, “Tubérculos, raíces y sus productos derivados”, “Otras plantas, algas y sus productos derivados”, respectivamente.

Número Denominación
2.18.9. Melaza de habas de soja
4.1.4. Melazas de remolacha (azucarera)
4.1.5. Melaza de remolacha (azucarera) parcialmente desazucarada o desbetainizada
4.4.7. Melaza de achicoria
7.6.1. Melaza de caña (de azúcar)
7.6.2
Melaza de caña (de azúcar) parcialmente desazucarada
Descripción Declaraciones obligatorias
Producto obtenido durante la transformación de habas de soja.
Jarabe obtenido durante la elaboración o el refinado de azúcar procedente de remolachas azucareras. Además, puede contener hasta un 0,5 % de antiespumantes, un 0,5 % de desincrustantes, un 2 % de sulfato y un 0,25 % de sulfito.
Producto obtenido por nueva extracción, utilizando agua, de la sacarosa o de la betaína, a partir de melaza de remolacha azucarera. Puede contener hasta un 2 % de sulfato y hasta un 0,25 % de sulfito.
Producto de la transformación de la achicoria, obtenido durante la producción de inulina y oligofructosa. La melaza de achicoria está constituida por materiales vegetales orgánicos y minerales. Puede contener hasta un 0,5 % de antiespumantes.
Jarabe obtenido durante la fabricación o el refinado de azúcar procedente de Saccharum L. May que puede contener hasta un 0,5 % de antiespumantes, un 0,5 % de desincrustantes, un 3,5 % de sulfato y un 0,25 % de sulfito.
Producto obtenido por nueva extracción de la sacarosa, utilizando agua, a partir de melaza de caña de azúcar.
Proteína bruta, Grasa bruta
Azúcares totales, expresados en sacarosa
Contenido de humedad, cuando sea > 28 %.
Azúcares totales, expresados en sacarosa
Contenido de humedad, cuando sea > 28 %.
Proteína bruta, ceniza bruta Humedad, cuando sea < 20 % o > 30 %
Azúcares totales, expresados en sacarosa
Contenido de humedad, cuando sea > 30 %.

Azúcares totales, expresados en sacarosa
Contenido de humedad, cuando sea > 28 %.
Tabla 1. Melazas más habituales en alimentación animal y sus características según el Catálogo de Materias Primas (Reglamento UE 68/2013).
De entre los nutrientes que es necesario declarar de estos ingredientes destacan los azúcares totales (expresados en sacarosa) y el contenido en humedad.




Técnicamente, las melazas son un subproducto que se genera durante la producción de azúcar, cuando a la remolacha o la caña se la someten a un proceso de trituración y prensado. El jugo que se obtiene de ese proceso se procesa para eliminar impurezas. Este procesado consiste en una clarificación vía calentamiento y filtrado.
El jugo clarificado sufre un proceso de evaporación que resulta en un sirope donde se encuentra el azúcar. El sirope se cristaliza y centrifuga varias veces hasta obtener por un lado el azúcar puro y, por otro, las melazas.

Caña de azúcar
Molienda y difusión en tándem
Caldera
Excedente de bagazo
Bagazo Zumo crudo
Ceniza volátil
Residuos de hojas del campo
Las Figuras 1 y 2 muestran el proceso de obtención de las melazas de remolacha y caña de azúcar, respectivamente (Lima y Beacorn, 2022). Las diferencias más importantes entre los dos procesos se centran en la primera parte (recolección y preparado de las materias primas), debido a la diferente naturaleza de la remolacha (tubérculo) con respecto a la caña (monocotiledónea).

Clari cador
Zumo clari cado
Azúcar sin re nar Melaza Lodo de ltro de prensa
Cristalizador evaporador
Figura 1. Esquema de obtención de subproductos a partir de la producción de azúcar de caña (Lima y Beacorn, 2022)

Pulpa de remolacha
Secadora
Pulpa seca
Peletizadora
Remolacha azucarera
Limpieza / Corte
Prensado de remolacha
Clari cador
Zumo uido
Zumo Clari cado
Pellets Lodo de ltro de prensa
Cristalizador evaporador
Azúcar sin re nar Melaza
Figura 2. Esquema de obtención de subproductos a partir de la producción de azúcar de remolacha (Lima y Beacorn, 2022)
En cuanto a la melaza de soja, ésta se obtiene a partir de la harina de soja en el proceso de obtención de concentrado de proteína de soja (Rakita et al., 2021).
Después de eliminar el aceite de las semillas de soja trituradas, en el proceso de obtención de concentrados de proteína de soja, para concentrar la proteína los carbohidratos se eliminan utilizando etanol diluido tibio (60-70%) o isopropanol.
El subproducto que contiene carbohidratos, lípidos, algo de proteína y alcohol se somete a un proceso de evaporación que elimina prácticamente todo el alcohol, dando lugar a la melaza de soja.
En la Tabla 2 se muestra la composición (en materia seca, MS) de las melazas de remolacha, caña y soja según diferentes fuentes (FEDNA, CVB e INRAE). El contenido en MS de las melazas oscila alrededor de un 75% de media, exceptuando las melazas de soja que presentan un contenido en MS menor (50-60%).

Estos azúcares son fácilmente degradables en el rumen y pueden agravar los posibles problemas de cetosis en raciones ricas en fibra para vacas al inicio de lactación y ovejas al final de gestación, si no se controla el nivel de inclusión en las raciones.
Su componente mayoritario son los azúcares, que representan en torno a un 60-70% de su MS en el caso de las de remolacha y caña y algo menor en el caso de las de soja (50%). El azúcar mayoritario que contienen al menos la melaza de remolacha y la de caña es la sacarosa.
Estos azúcares hacen que sean ingredientes muy palatables y su contenido energético sea apreciable en todas las especies.
En general, a la melaza de remolacha se le asigna un valor nutritivo algo superior al de la de caña y la de soja, probablemente por contener más sacarosa y menos oligosacáridos (rafinosa) y ácidos orgánicos (málico, oxálico, láctico, acotínico y cítrico), excepto en el caso de las melazas de caña altas en azúcares que presentan valores similares a los de remolacha.
En cuanto al contenido en proteína, la melaza de remolacha tiene un contenido en proteína bruta superior a la de caña y la de soja (12-14 vs 6-7%). En general, la fracción nitrogenada de las melazas de remolacha y caña es totalmente soluble, estando constituida en un 50% por aminoácidos y en un 50% por nitrógeno no proteico (FEDNA, 2012).
La proporción de aminoácidos esenciales es muy baja y muy variable entre fuentes, siendo los más abundantes la isoleucina y la leucina. En cuanto a la melaza de soja, la concentración de aminoácidos sigue siendo baja, pero es superior a la de las melazas de remolacha y caña lo que indica que la proporción de nitrógeno no proteico es inferior en este ingrediente.

Es importante mencionar que la melaza de remolacha es particularmente rica en betaína, lo que puede compensar parte de las necesidades de colina de los animales. las melazas presentan altos contenidos en cenizas (11-20%). Las de caña son ricas en calcio y cloro, las de remolacha en sodio y las de soja en fósforo. Todas contienen un elevado contenido en potasio (4-7%), especialmente las de soja.
Ingredientes

Esenciales

Una 1,4-beta glucanasa
MAX
Una altamente eficiente 1,4-betaxilanasa
Un xiloglucano específico 1,4-betaglucanasa
ACE
JUNTOS, NOSOTROS SOMOS
Y nos aseguramos de que los animales aprovechen al máximo la fibra, asegurando un rendimiento optimizado y un intestino saludable.
1 http://www.fundacionfedna.org/ingrediente; valores expresados en materia seca
2 https://www.cvbdiervoeding.nl/pagina/10021/home.aspx. CVB Feed Table 2023. Chemical composition and nutritional values of feedstuffs; valores expresados en materia seca
3 https://feedtables.com/content/table-dry-matter; valores expresados en materia seca
El uso de melazas de remolacha y caña está muy extendido en la industria de la fabricación de piensos, y también son ingredientes que se ofrecen a menudo en raciones de rumiantes.
Estos ingredientes se incluyen en las fórmulas como fuente de energía (generalmente sustituyen cereales en las raciones) y para aumentar la calidad del gránulo y su palatabilidad. El nivel de inclusión generalmente utilizado en piensos y raciones es superior en los rumiantes que en los monogástricos.
En rumiantes se considera que en raciones muy concentradas en energía el porcentaje de inclusión no debería superar el 10% de la MS ingerida, pero en raciones más diluidas y con una elevada proporción de forraje las melazas pueden incluirse hasta niveles del 15-20% de la MS ingerida (CNC, 2002).
Tabla 2. Composición química (en materia seca) de los tipos de melaza más utilizados en alimentación animal.
En estudios de campo se ha observado que la inclusión de melazas en raciones/ bloques de rumiantes puede incrementar el consumo de materia seca y estimular la actividad de la microbiota ruminal, mejorando la digestibilidad del forraje (Wanapat, 2000).
Además, a niveles óptimos el aumento de la proporción de carbohidratos solubles, cuya degradación proporciona energía para el desarrollo de microorganismos ruminales y del huésped, implica una mayor síntesis de proteínas microbianas a partir del nitrógeno no proteico disponible en estos ingredientes y un menor contenido de amoniaco en el rumen (Broderick and Radloff, 2004).

Sin embargo, niveles muy elevados (50% de la MS ingerida) pueden ser problemáticos porque pueden dar sabor a la leche y, debido a su fermentación hacia propionato, pueden causar cetosis y una reducción de la producción de leche (Bernard et al., 1991).
En el caso de los animales monogástricos (porcino y aves), aunque se han testado con resultados positivos niveles de inclusión de hasta un 10-20%, no se recomienda superar la inclusión del 10% (Mavrovichalis, 2013; Sureshkumar et al., 2016), debido a su potencial efecto laxante debido a su elevado contenido en minerales, sobre todo potasio.
Además, su consistencia viscosa y su contenido en humedad puede suponer un problema a la hora de incorporar melazas a niveles altos en piensos. Algunos autores consideran la posibilidad de sustituir parcial o totalmente la lactosa de las dietas de lechones destetados con melazas con el objetivo de abaratar las raciones y utilizar ingredientes alternativos.
Esta estrategia se basa en el hecho de que la sacarosa y sus componentes (glucosa y fructosa) pueden digerirse y ser absorbidos con la misma eficiencia que la lactosa (Mavromichalis et al., 2001). Incorporada a niveles moderados-bajos la melaza estimula el consumo, algo fundamental en estas primeras fases post-destete.
En el caso de la melaza de soja, su uso en alimentación animal está menos extendido y se centra, sobre todo, en rumiantes. La melaza de soja posee también un elevado contenido en energía y un bajo contenido en proteína.

Además, y a diferencia de las otras melazas, esta posee una elevada cantidad de componentes fitoquímicos, como las isoflavonas, saponinas, ácidos fenólicos, fosfolípidos, fitoesteroles, entre otros.
Algunos de ellos poseen efectos antimicrobianos, antifúngicos o antioxidantes, por lo que pueden considerarse positivos, pero en algunas especies, como las aves o las cerdas reproductoras, algunos de estos fitoquímicos pueden producir efectos adversos. Por su composición, es posible que los niveles de inclusión óptimos en rumiantes sean superiores a los de las otras melazas (Arruda et al., 2021).
No existe información acerca de los efectos de la melaza de soja en dietas para monogástricos. Sin embargo, por su composición, este ingrediente alternativo tiene un potencial prometedor para ser incluido en la dieta de los cerdos como fuente de energía, ya que los cerdos pueden digerir los oligosacáridos presentes en la melaza de soja (Rakita et al., 2021).
Por otro lado, las melazas pueden utilizarse para hacer ensilaje para rumiantes, mejorando su valor nutricional.
Las melazas son subproductos con un elevado potencial en alimentación animal cuando se utilizan los niveles óptimos de inclusión.
Las de remolacha y caña son ampliamente utilizadas, sin embargo, las melazas de soja son menos conocidas y la información disponible acerca de su composición y nivel de inclusión óptimo en las diferentes especies es escasa.
Este es un ejemplo más de ingrediente alternativo que, utilizado en piensos, contribuye a la economía circular de la ganadería.
Bibliografía disponible en la versión web del artículo en nutrinews.com
Product Manager, Departamento Marketing Técnico de Andrés Pintaluba
La optimización de los procesos digestivos a través del uso de enzimas exógenas sigue siendo un elemento clave en la industria de la nutrición animal. Estas enzimas actúan como catalizadores en reacciones bioquímicas vitales, facilitando la degradación de componentes de baja digestibilidad, como los polisacáridos no amiláceos (PNA), galactosacáridos y mananos.
No obstante, seleccionar la enzima adecuada es crucial, ya que debe ajustarse a las condiciones fisiológicas específicas del animal para maximizar el rendimiento nutricional. Es una forma de fomentar la producción sostenible al contribuir en una utilización más eficiente de los nutrientes.



La clasificación de las enzimas exógenas disponibles hoy en día ha dado lugar a tres categorías principales:
Se trata de una enzima específica, diseñada para actuar sobre un componente concreto de difícil digestión presente en las materias primas. Estas enzimas, producidas mediante fermentación por organismos genéticamente modificados (OGM), están optimizadas para mejorar la eficiencia de dicha fermentación, maximizando así la capacidad productiva de estas industrias.


Representa una combinación de diversas enzimas con actividad única, que han sido producidas de manera independiente en diferentes procesos de fermentación llevados a cabo por OGMs. Estas enzimas son extraídas, purificadas y posteriormente combinadas en una formulación única.
Es un conjunto de enzimas que son producidas simultáneamente en un único proceso, generalmente a través de una única fermentación en la que un organismo no modificado genéticamente (No OGM) genera una variedad de enzimas que actúan de manera coordinada y sinérgica para facilitar la digestión de los ingredientes complejos.
En procesos de biocatálisis de los nutrientes, muchas reacciones no pueden ser llevadas a cabo por una sola enzima y requieren la acción conjunta de dos o más enzimas para desencadenar reacciones en cascada.
En el caso de los complejos multienzimáticos, las moléculas enzimáticas están físicamente cercanas.
De esta manera, se facilita la formación de canales de sustrato, mejorando así la sinergia y la eficiencia catalítica de las enzimas en cascada (Yin et al., 2018), mientras se reduce la disipación de energía.
Estos complejos enzimáticos son especialmente relevantes en procesos como la degradación de celulosa, que necesita múltiples enzimas para lograr una descomposición efectiva (Bayer et al., 1998). Según Coughlan y Hazlewood (1993), la hidrólisis eficiente y completa de xilanos depende de la acción sinérgica de enzimas que rompen tanto la cadena principal como las ramificaciones laterales.

En cambio, la producción de las mezclas combinadas de enzimas, implica la reorganización artificial de múltiples enzimas en sistemas microbianos, con el objetivo de crear rutas metabólicas novedosas. Sin embargo, estos sistemas suelen carecer de la sinergia y estabilidad que los complejos enzimáticos han perfeccionado.
Por lo tanto, a pesar de los esfuerzos realizados, replicar de manera precisa las interacciones y el entorno de los complejos enzimáticos sigue siendo un reto.
VERSATILIDAD Y EFICACIA EN LA DEGRADACIÓN DE SUSTRATOS
La producción de enzimas a través de tecnología con organismos genéticamente modificados (OGMs) ha facilitado la obtención de grandes concentraciones de enzimas puras y altamente específicas, enfocándose en un solo gen para una actividad enzimática unifuncional. Sin embargo, las enzimas No OGM ofrecen ventajas notables que las hacen sobresalir.
Las enzimas de origen No OGM, ofrecen un espectro más amplio de actividades enzimáticas por su capacidad de aprovecharse de todos los componentes del soporte del cuál se alimentan.
Esto se traduce en una mayor versatilidad y capacidad para descomponer los sustratos complejos presentes en las materias primas de los piensos.
Un ejemplo destacado es el microorganismo Aspergillus no modificado genéticamente, que ha demostrado producir no solo enzimas eficaces como las betaglucanasas, xilanasas y amilasas, sino también una variedad de actividades enzimáticas complementarias, como alfagalactosidasas, betamananasas y proteasas.
Esta diversidad hace que la degradación de los complejos antinutricionales sea completa y eficiente.
Las enzimas digestivas pueden ser extraídas de diversos microorganismos, como hongos, levaduras y bacterias, y su origen tiene un impacto significativo en su mecanismo de acción y en su eficacia para descomponer compuestos de baja digestibilidad.
Para optimizar su eficiencia, las enzimas digestivas necesitan condiciones de pH específicas, ya que su estructura y actividad dependen del entorno en el que operan. Cada enzima posee un rango óptimo de pH en el que su conformación tridimensional se mantiene estable, permitiéndole catalizar reacciones de manera efectiva.
Además, el pH influye en la ionización de los grupos funcionales en el sitio activo de la enzima, lo que puede afectar su capacidad para interactuar con el sustrato.

La variación del pH a lo largo del tracto digestivo representa un desafío fundamental para garantizar la funcionalidad óptima de las enzimas.
En el entorno ácido del estómago en el caso de los cerdos, o del buche, la molleja y el proventrículo en el caso de las aves, cuyo pH puede oscilar entre 2,5 y 5, las enzimas deben resistir las condiciones extremas antes de llegar al intestino, donde el pH es más neutro (alrededor de 6 a 7) y además soportar estos cambios drásticos de pH al atravesar el tracto digestivo.

Este aspecto cobra particular relevancia con el aumento del uso de ácidos orgánicos en las dietas de iniciación, los cuales contribuyen a reducir el pH del tracto digestivo.
Las enzimas exógenas de origen bacteriano, debido a la acidez gástrica, suelen inactivarse o desnaturalizarse en el estómago, y solo se activan en un rango de pH neutro. En contraste, las enzimas de origen fúngico destacan por su capacidad de mantener una actividad óptima en condiciones más ácidas, resistiendo la acidez estomacal sin sufrir alteraciones significativas.
Un estudio in vitro que evaluó la actividad de diversas enzimas en condiciones simuladas, reveló que las carbohidrasas producidas por Aspergillus pueden conservar más del 60% de su actividad en un rango de pH de 3 acercándose a 6 (Gráfica 1).
Esto permite que las carbohidrasas comiencen a actuar en el estómago, promoviendo la predigestión de nutrientes antes de que los alimentos lleguen al intestino delgado, mejorando así la digestión y absorción de carbohidratos y proteínas a nivel intestinal.
La capacidad de las enzimas fúngicas para adaptarse a distintos niveles de pH les permite ofrecer un rendimiento sostenido a lo largo de todo el tracto digestivo, consolidándolas como una opción eficiente para mejorar la digestibilidad y el aprovechamiento de nutrientes en animales sometidos a dietas diversas.

Gráfica 1. Evolución de la actividad enzimática de diferentes microorganismos a varios niveles de pH. Enzyme Services & Consultancy Ltd, Unit A1, Britannia Enterprise Centre.
Talaromyces funiculosus
Thermomyces lanuginosus
Aspergillus niger
Bacillus subtilis
En otro estudio in vitro, que quería simular unas condiciones más parecidas a una situación real in vivo, se evaluó la capacidad de diferentes preparados enzimáticos para degradar Oligosacáridos de la serie de Rafinosa (OSR) de sustratos naturales, a diferentes niveles de pH (Gráfica 2).
De acuerdo con los datos de la gráfica, las enzimas de Aspergillus niger y Aspegillus oryzae mostraron una mayor eficacia en la disminución de oligosacáridos (OSR) contribuyendo a una reducción significativa en la concentración final de OSR.
Estas enzimas han demostrado alcanzar su máximo rendimiento a un pH de 4,0 confirmando así su capacidad para degradar eficientemente los oligosacáridos en ambientes ácidos y favoreciendo la liberación y absorción de glucosa y sacarosa en el intestino.
Complejos enzimáticos de origen fúngico: Una revolución constante
DESCÁRGALO EN PDF
Gráfica 2. residuales de OSR en soja después de la incubación durante una noche con cinco enzimas diferentes a pH 5.0, 4.0 y 3.0; Enzyme Services & Consultancy Ltd, Britannia Enterprise Centre.
En un entorno social actual donde la sostenibilidad del planeta cada vez toma mayor importancia, la optimización de los procesos digestivos mediante enzimas exógenas es esencial en la nutrición animal, mejorando la degradación de sustratos de baja digestibilidad y maximizando el rendimiento nutricional de la dieta.
La selección adecuada de estas enzimas es crucial para asegurar su efectividad en el tracto digestivo, considerando factores determinantes como el pH.
Las enzimas de origen no OGM, en particular las fúngicas, destacan por su versatilidad de actuación sobre ingredientes complejos y capacidad para funcionar en entorno ácido, lo que las convierte en una opción eficiente para mejorar la digestibilidad y el aprovechamiento de nutrientes en diversos tipos de dieta.


Aumenta el rendimiento productivo
Optimiza la formulación de la dieta
Mejora la salud intestinal
Reduce costes


P. Martín Atance, J. Estévez & S. Carné ITPSA. Departamento Técnico y de Innovación; scarne@itpsa.com

Los alfa-galactósidos, también llamados oligosacáridos de la familia de la rafinosa (OR), suponen aproximadamente el 5-6% del contenido seco de la soja y otras leguminosas, así como la harina de colza.

Estos oligosacáridos son osmóticamente muy activos, por lo que incrementan el agua en la luz intestinal de los animales, lo que afecta a la digestibilidad y absorción de nutrientes y tienen un gran impacto en la consistencia de las heces. Además, la rafinosa y la estaquiosa causan molestias abdominales (retortijones, flatulencia y diarrea) en humanos y animales, los cuales carecen de actividad α-galactosidasa.


α-Galactósidos en sojas de distintas procedencias








Si los enlaces α-1,6 de estos alfa-galactósidos no se hidrolizan antes de que alcancen el intestino grueso, sirven de sustrato para fermentaciones microbianas anaeróbicas que producen gas en exceso (Smits y Annison, 1996).

Al introducir la harina de soja en la dieta de animales monogástricos se asume un aporte de alfa-galactósidos, que condicionan la estructura de las comunidades bacterianas del intestino grueso.
Figura 1. Contenido de estaquiosa, rafinosa y sacarosa en harina de soja de distintas procedencias (%MS) (adaptado de González y col., 2009).
En especies terrestres también se describen estos fenómenos adaptativos a los OR. Se ha estudiado ampliamente la respuesta de los lechones, asociada a procesos de disbiosis en los que se comprueban alteraciones morfológicas del epitelio intestinal, por su importancia como limitante del desempeño al destete (Zhang y cols 2003).

Así, cuando se emplean proporciones crecientes de este ingrediente en piensos para peces, por ejemplo, se puede comprobar que limita su desarrollo y provoca alteraciones histológicas asociadas al síndrome de malabsorción (como una menor integridad de los enterocitos y densidad de microvellosidades), y fisiopatológicas (como infiltración celular de la submucosa y de la lámina propia) en las que se ve afectada la expresión génica del sistema inmunitario del intestino y la respuesta inflamatoria del animal (Marjara y col., 2012).

También en pollos, que responden con una reducción de la energía metabolizable, complicaciones de la retención de agua a nivel digestivo, alteración de la composición de las comunidades microbianas, reducción de la asimilación de nutrientes (como proteínas o aminoácidos) y pérdida de consistencia de la gallinaza (Zhu y col., 2020).
No obstante, estos efectos no están bien caracterizados, y pueden limitarse a ligeras modificaciones del pH cecal, a los recuentos microbianos o la producción de ácidos grasos volátiles, por lo que algunos investigadores sostienen que la principal causa de depresión del crecimiento en esta especie también tiene una base inflamatoria.
En cualquier caso, estudios recientes indican que la presencia de más de un 1,2% de alfa-galactósidos en la dieta ya tiene un impacto negativo en el crecimiento de los pollos.
Para evitar los trastornos gastrointestinales derivados de los OR, se puede adicionar la enzima α-galactosidasa (E.C. 3.2.1.22) a los piensos, con lo que, además, se consigue aprovechar mejor los nutrientes de la soja y mejorar su valor energético: a diferencia de lo que ocurre con los sustratos de otras carbohidrasas, al hidrolizar estos oligosacáridos se liberan azúcares monosacáridos (glucosa, fructosa y galactosa) que los animales asimilan fácilmente.

En un ensayo realizado a principios de 2024, en una explotación de ponedoras ubicada en Badajoz, se añadieron (on top) 350 g/TM de este producto en el pienso y se confirmó una mejora del índice de conversión de las gallinas del 1,7% (de 2,059 a 2.024).
alfa-galactosidasa
α-1,6 α-1,6 β-1,2 alfa-galactosidasa invertasa
sacarosa
ra nosa estaquiosa
Numerosos estudios evalúan dietas suplementadas con esta enzima, que demuestran mejoras de la adaptación a la soja de peces (Dan y col., 2022), cerdos (Baucells y col., 2000) y pollos (Viñado y col., 2024).
Sin embargo, las investigaciones realizadas en animales más maduros no son tan abundantes, y los beneficios del uso de la enzima en otras fases productivas, como la lactación y la finalización de cerdos, o la puesta de aves han sido menos divulgados en publicaciones científicas.
CAPSOZYME® SB PLUS es un complejo enzimático de ITPSA con actividad α-galactosidasa y xilanasa, cuyos beneficios se han evaluado en numerosas pruebas.
Efectos nocivos de los alfa-galactósidos de la soja en alimentación animal, y cómo revertirlos DESCÁRGALO EN PDF
Los resultados comparativos más significativos se obtuvieron en parámetros de calidad, con una reducción de la proporción de huevos sin valor comercial (sucios, rotos y sin cáscara) del 48% (de 1,88% a 0,97%), mayormente debida a una disminución del 82% de huevos sucios (del 1,13% al 0,20%).
Peso de huevo, g 61,3 61,5
Tasa de puesta, % 94,6 95,0
Masa de huevo, g/d 58,0 58,4
Consumo diario de pienso, g/d 119,3 118,2
Índice de conversión, g/g 2,059 2,024
Peso vivo de la gallina, g 1,965 1,967
Rotos, % 0,17 0,13
Sin cáscara, % 0,58 0,64
Sucios, % 1,13a 0,20b
Sin valor comercial, % 1,88 0,97
Tabla 1. Resultados de producción en gallinas de 26 a 36 semanas de edad.
En consonancia con otras experiencias en aves de renta, estos resultados se interpretan como consecuencia de la reducción del contenido en agua de la excreta, que puede resultar especialmente relevante para explotaciones con problemas de humedad en las camas, especialmente podo-dermatitis (Nagaraj y col., 2007), cuya solución nunca es fácil.
Referencias disponibles en la versión web del artículo en nutrinews.com
Único preparado registrado en la UE que combina alfa-galactosidasa y xilanasa, con actividad complementaria invertasa, que incrementa el valor energético y proteico de la soja, otras leguminosas y la colza
Combinación específica de α-galactosidasa y xilanasa

10% la EM y un 8% la absorción de AA en las leguminosas y la colza
Ahorra costes y aumenta la productividad
Polvo y Líquido




Marine Dewez, doctora en fisiología reproductiva avícola por el INRA y la Universidad de Tours (Francia), llevó a cabo su investigación en el sector de selección avícola.




Multilingüe y con una gran experiencia en nutrición de monogástricos se fue orientando poco a poco hacia la nutrición de precisión, centrándose en aditivos para diversas especies animales. Su trayectoria en grupos internacionales en Europa y Latinoamérica le ha permitido perfeccionar sus habilidades en este campo.
Con su visión estratégica y experiencia científica, Marine Dewez es un activo valioso para respaldar el desarrollo y la implementación de la tecnología de microencapsulación de vanguardia de Jefo, líder mundial en soluciones nutricionales no farmacológicas de alta precisión.
Las soluciones de Jefo, adaptadas a la fisiología intestinal única de cada especie, están diseñadas para mejorar el rendimiento y el bienestar animal, apoyando la producción sostenible, segura y rentable de proteína animal.
¿En
qué consiste el proceso de
microencapsulación en nutrición animal?
La microencapsulación consiste en envolver ingredientes activos (como vitaminas, aminoácidos, ácidos orgánicos, extractos de plantas, etc.) en una capa protectora.
Esto limita la destrucción de moléculas, en el almacenamiento, durante la fabricación del alimento y en el tracto digestivo.
También permite una liberación controlada de ingredientes activos, asegurando que actúen en el momento adecuado, por ejemplo, en el intestino, mejorando la eficiencia de los nutrientes y la salud de los animales.
Una buena protección proporciona un equilibrio entre la estabilidad del ingrediente activo, y la biodisponibilidad para el animal.


Hace 20 años, Jefo lanzó su Tecnología

Jefo Matrix®, una tecnología pionera de microencapsulación que se ha perfeccionado a lo largo de los años para garantizar una liberación específica y gradual de los ingredientes clave en su forma activa de manera precisa para una absorción óptima y los máximos resultados.
Por lo tanto, esta tecnología de vanguardia permite llevar las moléculas adecuadas, al lugar correcto, en el momento correcto, en la dosis correcta y en la especie correcta , de acuerdo con las necesidades fisiológicas de cada una.

Las moléculas activas se integran en una matriz de triglicéridos, protegiéndolas de las interacciones y la degradación hasta que llegan al intestino, donde bajo la acción enzimática, estas moléculas son liberadas para su absorción y valorización directa por parte del animal.
¿Cuáles
Las moléculas activas valiosas y frágiles, como las vitaminas o los aceites esenciales, pueden degradarse durante el almacenamiento, durante el proceso de fabricación de alimentos o incluso dentro del propio animal, y requieren estrategias de protección para poder actuar de manera precisa y específica.
Gracias a la microencapsulación, las moléculas activas se beneficiarán de la protección a varios niveles.
En primer lugar, las moléculas se protegen de las condiciones externas (temperatura, humedad, luz, etc.). Además, la microencapsulación de Tecnología Jefo Matrix® ofrece la ventaja de prevenir reacciones químicas (reacción oxidante, acidez, etc.) entre los componentes, integrados en la matriz o en forma libre, hasta su liberación.
Esto permite, en particular, ofrecer a la industria productos protegidos con una gran estabilidad en el tiempo.
Desde la producción de la premezcla hasta el alimento final entregado a la granja, las moléculas activas se conservan durante todo el proceso de fabricación, incluso durante los tratamientos térmicos y mecánicos (como granulación, extrusión, etc.).

Tecnología Jefo Matrix



La Tecnología Jefo Matrix® permite reducir al mínimo la pérdida del principio activo “puro” en la barrera intestinal, luego un máximo de biodisponibilidad una vez en el intestino, respetando una protección específica para cada especie.
Nuestra microencapsulación evita la degradación en el estómago y el rumen, transportando directamente las moléculas activas a su sitio de absorción: el intestino, donde se liberan
A continuación, la matriz protectora se degrada por la acción de las lipasas y
El uso de la Tecnología Jefo Matrix® protege moléculas específicas para maximizar su recuperación durante el proceso de fabricación de alimentos y su biodisponibilidad para el animal.
Los ingredientes activos no protegidos pueden degradarse durante el almacenamiento, durante la mezcla, debido a las interacciones con otros compuestos y, finalmente, bajo las tensiones térmicas y mecánicas de la producción de pellets.
Bajo la acción del calor, nuestra matriz se deforma, sin liberar las moléculas activas, y retrasa la acción de la temperatura sobre los ingredientes sensibles. Del mismo modo, bajo estrés mecánico, los principios activos no se liberan, sino que la matriz se fragmenta, manteniendo su acción protectora.
Por lo tanto, la Jefo Matrix® ayuda a proteger estas moléculas contra estos desafíos, asegurando una liberación óptima de nutrientes en el cuerpo del animal.
Estabilidad de la vitamina A en la premezcla
120.000 Ul/g
Ul/g de Vitamina A
100.000 Ul/g
80.000 Ul/g
60.000 Ul/g
40.000 Ul/g
20.000 Ul/g
0 Ul/g ±20% ±70%
0 4 Meses
Vitaminas Jefo Matrix Vitamina A libre

Figura 1. Estabilidad durante 4 meses de almacenamiento de la vitamina A libre o de vitamina A protegida por Jefo Matrix, ambos en presencia de sulfato de cobre.
¿Por qué los gerentes de planta prefieren usar productos protegidos?
En la planta de premezclas y piensos, el uso de productos protegidos, como los basados en la Jefo Matrix®, ofrece muchas ventajas operativas.
Esta tecnología reduce significativamente la formación de polvo, mejorando la comodidad y la seguridad de los empleados, al tiempo que minimiza la corrosión de los equipos.
También garantiza una mejor fluidez del polvo, lo que facilita la manipulación de los productos en la fábrica y evita el riesgo de contaminación cruzada. Además, estos productos son seguros de manipular, protegiendo tanto al personal como al equipo.
Por último, la ausencia de interacciones con otros componentes del pienso garantiza una mejor estabilidad de la formulación y una producción más fiable.
Caracterización de Pulverulencia
Área de polvo
0 1 10
Velocidad de Asestamiento
Selenito de sodio
Selenio protegido Jefo
Óxido de zinc
Jefo (ZnO)
Ácido málico
Ácido cítrico
Ácido sórbico
Ácido fumárico
Sorbato de potasio
Jefo (AO+AE)

Figura 2. Resultados de los parámetros de emisión de polvo en comparación con la base de datos de aditivos alimenticios de TecalimanNantes, Francia (los ejes X e Y están en escala logarítmica)
Gracias a la Jefo Matrix®, los componentes activos se liberan gradualmente en la zona intestinal para una eficacia específica y máxima. Cada matriz ha sido desarrollada específicamente en función del tránsito intestinal de cada especie, por ejemplo, en cuanto a densidad y tamaño de partícula.


La matriz de triglicéridos protege las moléculas activas de la degradación en el estómago y se degrada gradualmente una vez en el intestino bajo la acción de lipasas y jugos pancreáticos, liberando así gradual y completamente las moléculas activas a lo largo del tracto.
Yeyuno medio

Figura 3. Perfil de liberación in vivo del timol a lo largo del TGI de lechones destetados alimentados con una dieta suplementada con timol de la solución Jefo Matrix.
Figura 4. Actividad bacteriana en el tracto digestivo
esta tecnología ayuda a mejorar la salud y el rendimiento intestinal al dirigirse directamente a las áreas afectadas por los desafíos bacterianos. (Figura 4)
Dado que las pérdidas antes de la llegada al intestino son limitadas y la biodisponibilidad maximizada gracias a la Tecnología Jefo Matrix®, se pueden optimizar las cantidades de moléculas activas y dirigir su acción, como en el caso del uso de óxido de zinc. (Figura 5)
En esta prueba, el alimento testigo contenía 125 g/T de óxido de zinc libre, mientras que la solución de Jefo a 250 g/T, equivalente a 125 g/T de óxido de zinc protegido.
El rendimiento zootécnico de los lechones de 26 kg hasta el sacrificio mejoró gracias a la Tecnología® Jefo Matrix (+2,6% de ganancia media diaria) y la mortalidad se redujo en casi 2 puntos (2,88% frente a 0,96%).
Figura 5. Diferencial de GMD de un alimento con solución de JEFO frente a alimento testigo. (15,5%)

¿Cuál es el interés de la protección en la nutrición de rumiantes?
El rumiante fermentará su ración antes de la digestión intestinal, en el rumen. Esta fermentación tiene la ventaja de aprovechar alimentos y nutrientes de baja calidad (nitrógeno, no proteínas).
Por otro lado, esta fermentación degrada moléculas de interés (vitaminas, aminoácidos, etc.).
Como se ha mencionado, la diferenciación de la protección de la Tecnología Jefo Matrix® permite limitar la pérdida de ingredientes activos, que a veces son muy frágiles y costosos.
Este es un punto decisivo en el contexto de la nutrición de rumiantes, donde muchos ingredientes son sensibles al deterioro, o incluso desaparecen cuando pasan por el rumen.
En el mercado español, las soluciones de JEFO han demostrado su eficacia durante más de 25 años. Gracias a la nutrición de precisión, se pueden satisfacer de forma específica las necesidades nutricionales específicas de cada animal, al tiempo que se optimiza la biodisponibilidad de los nutrientes en el intestino.
Además, este enfoque permite la integración de soluciones de prevención para el mantenimiento de la salud intestinal, asegurando una liberación controlada de activos exactamente donde se necesitan.
La Tecnología Jefo Matrix® desempeña un papel clave en la protección de las moléculas activas durante el almacenamiento, el procesamiento y hasta que llegan al intestino, ofreciendo así beneficios tanto para el bienestar animal como para los procesos industriales.
1. Ejemplo de degradacion de vitaminas del grupo B en el rumen.
Para obtener la misma cantidad de vitaminas del grupo B en el intestino, se deben añadir a la ración 5,7 veces más vitaminas libres, en comparación con las vitaminas protegidas por la Tecnología® Jefo Matrix, ya que estas últimas son un 72% más biodisponibles tras el paso del rumen.

Publicación y resultados de pruebas disponibles bajo pedido: contact.europe@jefo.ca
Fiel a su compromiso, “Life, made easier”, Jefo ha desarrollado soluciones y herramientas innovadoras para hacer frente a los desafíos tecnológicos y de calidad que suelen encontrar en las fábricas de piensos.
Al integrar a nuestros especialistas, tecnólogos y químicos, Jefo apoya a los gerentes de planta en la optimización de los procesos de fabricación a través de auditorías personalizadas de herramientas industriales.
Desempeñan un papel clave en la mejora de los pasos de producción, la gestión de equipos industriales, la reducción de las pérdidas de materias primas y la garantía de la seguridad de los empleados, garantizando un rendimiento industrial óptimo.
Además, Jefo lleva a cabo estudios sobre el impacto de la protección de la Tecnología Jefo Matrix®, en relación con los problemas tecnológicos observados durante estas auditorías.
Con el fin de satisfacer las necesidades de los responsables de fábrica y garantizar la seguridad de los trabajadores, el Departamento de Calidad ha desarrollado herramientas específicas.
El “Pasaporte de Producto Jefo” es un fichero completo y único para cada producto, que reúne no solo los documentos de calidad tradicionales (ficha técnica, plan de control, etc.), sino también documentos innovadores, como la ficha tecnológica.
Esto incluye todos los análisis fisicoquímicos realizados por Jefo, así como un resumen visual del comportamiento del producto y los datos de su análisis de ciclo de vida.
Tecnología Jefo Matrix DESCÁRGALO EN PDF




Desde su fundación en 1989, Grupo PH-Albio se ha consolidado como un referente en el desarrollo y comercialización de aditivos, piensos complementarios y soluciones terapéuticas para garantizar la salud y el rendimiento óptimo de los animales de producción.
A lo largo de estos 35 años, la compañía ha mantenido una misión clara: ofrecer soluciones eficaces, competitivas y prácticas a los desafíos que enfrenta el sector de la producción animal.
“Nuestro compromiso, hoy como siempre, es mejorar los resultados productivos y sanitarios de nuestros clientes ofreciendo soluciones que no solo garanticen la salud animal, sino que también optimicen el uso de los recursos, promuevan el bienestar animal y minimicen el impacto ambiental de la producción.
Creemos firmemente en un enfoque integral que equilibre productividad, sostenibilidad y respeto por el entorno”.
Jordi Gomà, director general de Grupo PH-Albio.


FUNDACIÓN PH IBERICA
Comercialización a nivel nacional de aditivos nutricionales y fármacos para animales de abasto

FUNDACIÓN
MPA Veterinary Medicines and Additives nace con el fin de distribuir los aditivos de PH-Albio a nivel internacional Actualmente, está presente a más de 50 países de todo el mundo

INCORPORACIÓN
División enfocada a la comercialización de minerales para diversos usos Industriales

FUNDACIÓN MPA
Apertura de una nueva filial en México: MPA México-North Tradium Global Technology



FUNDACIÓN ALBIO FERM
Fabricación y comercialización de soluciones nutricionales y terapéuticas para animales

El Grupo PH-Albio integra todas las empresas de la compañía

PLANTA FABRICACIÓN
Adquisición de una nueva planta de producción en la provincia de Barcelona, con más de 3 500m2

ADQUISICIÓN CFMEX
CFMEX Minerales, empresa de distribución que trabaja la línea de productos de Eurotradium en Mexico
En Grupo PH-Albio, nuestros valores fundamentales son el motor que impulsa nuestra evolución y crecimiento:
Innovación: Desarrollamos soluciones con valor añadido que optimicen la eficiencia, la seguridad y la rentabilidad de la producción animal.
Cercanía con el Cliente: Escuchamos y comprendemos las necesidades de nuestros clientes, colaborando estrechamente con ellos para brindar soluciones personalizadas, asesoramiento experto y un servicio ágil.
Sostenibilidad: Nuestros productos mejoran la salud y el bienestar animal a la vez que minimizan el impacto ambiental, en consonancia con nuestro compromiso con la producción responsable.
El éxito de Grupo PH-Albio no solo reside en nuestros productos, sino también en el equipo humano que los hace posibles. Nuestro equipo está formado por profesionales altamente capacitados y con una extensa experiencia en el sector.
“Siempre he creído que el verdadero motor de nuestra empresa es el equipo humano que la compone. No solo contamos con profesionales altamente capacitados, sino con personas comprometidas que comparten los valores y la visión de la compañía. El éxito que hemos logrado en estos 35 años es fruto del esfuerzo colectivo, de la dedicación y del afán de mejora continua. Para mí, es un orgullo liderar un equipo tan talentoso y cohesionado, y estoy convencido de que juntos seguiremos avanzando hacia nuevos retos y oportunidades.”
Jordi Gomà
Nuestro catálogo incluye productos para apoyar a fabricantes de pienso, veterinarios y ganaderos:
Optimizan la producción y reducen el desperdicio de materias primas, mejorando la eficiencia general del proceso productivo.
Soluciones basadas en compuestos bioactivos derivados de plantas y herramientas flexibles que mejoran la calidad microbiológica del agua de bebida.
Productos diseñados específicamente para garantizar la salud de los animales de granja.

Ser parte de la cadena alimentaria conlleva una gran responsabilidad, tanto con la sanidad animal como con la salud pública. Trabajamos bajo los más altos estándares de calidad, utilizando las mejores materias primas y colaborando con proveedores comprometidos.
Nuestras certificaciones avalan nuestro esfuerzo continuo por ofrecer productos seguros y de alta calidad.



REMODELACIÓN Y SOSTENIBILIDAD
En 2024, Grupo PH-Albio ha dado un gran paso adelante con la remodelación de la planta de producción de Sant Salvador de Guardiola (Barcelona).
“Esta remodelación no solo nos ha permitido aumentar la capacidad y eficiencia de nuestra producción, sino que también ha elevado nuestros estándares de calidad y nos ha permitido alinearnos con un enfoque más sostenible en nuestro proceso productivo”.
Jordi Gomà
Sus instalaciones de más de 3.500 m2 y la optimización de espacios para el almacenamiento permiten gestionar mayores volúmenes de producción, manteniendo un flujo más eficiente en toda la cadena de producción.
Además, las mejoras en la maquinaria han permitido acelerar ciertos procesos clave sin comprometer la calidad, lo que se traduce en una mayor rapidez de respuesta hacia los clientes.
La calidad también ha dado un salto cualitativo gracias a la renovación de las instalaciones y los sistemas de climatización.
Además, la instalación de placas fotovoltaicas refleja el compromiso de Grupo PH-Albio con la sostenibilidad.
Esto no solo reduce la huella de carbono, sino que también permite operar de manera más eficiente y responsable desde el punto de vista energético, cada vez más demandado por la industria.
“Tras 35 años de trayectoria, en Grupo PH-Albio no solo miramos con orgullo todo lo que hemos logrado, sino que también mantenemos la vista puesta en el futuro. Seguiremos apostando por la innovación, el compromiso con la sostenibilidad y la cercanía con nuestros clientes como pilares fundamentales para enfrentar los nuevos retos del sector.
Estamos convencidos de que la combinación de experiencia, equipo humano y constante inversión en calidad nos permitirá continuar ofreciendo soluciones de vanguardia que contribuyan al éxito de nuestros clientes y al bienestar de los animales, siempre respetando el medio ambiente”.

Jordi Gomà
Grupo PH-ALBIO: 35 años de innovación en salud y nutrición animal DESCÁRGALO EN PDF



35 años después, nuestra misión sigue siendo la de proporcionar soluciones eficaces y competitivas para resolver los desafíos a los que se enfrenta el sector ganadero, con total garantía de calidad, seguridad y respeto por el medio ambiente.
L. Cámara Universidad Politécnica de Madrid

Uno de los principales objetivos de la industria porcina en España es aumentar la ganancia magra de los cerdos, manteniendo niveles adecuados de grasa dorsal y grasa intramuscular en la canal.
Factores como la genética y la relación entre energía neta (EN)/proteína bruta (PB) del pienso afectan al rendimiento productivo y a la calidad de la canal y de la carne (Quiniou et al., 1999; Latorre et al., 2003).



En este sentido, un aumento en el contenido de EN del pienso a menudo resulta en una mayor ingesta de energía y una mayor acumulación de grasa en la canal (Cámara et al., 2014)
Por otro lado, los piensos altos en PB se utilizan a menudo para garantizar un suministro adecuado de aminoácidos (AA) indispensables, lo que puede aumentar la excreción de N y las emisiones de gases al medio ambiente (Møller et al., 2004; Dinuccio et al., 2008), limitando su aplicabilidad práctica (Cerisuelo et al., 2012).

Sin embargo, los cerdos alimentados con piensos bajos en PB presentan frecuentemente canales con mayor contenido en grasa, independientemente de la suplementación de cantidades adicionales de AA (Kerr et al., 1995)
La mayoría de los estudios publicados muestran una disminución en el consumo medio diario (CMD) y una mejora en la eficiencia alimentaria con aumentos en el contenido energético del pienso (Quiniou y Noblet, 2012; Serrano et al., 2013).
Sin embargo, los beneficios potenciales de incrementar el contenido energético del pienso sobre la ganancia media diaria (GMD) de los cerdos en crecimiento/cebo son objeto de debate.
En este sentido, Cámara et al. (2014) observaron que un incremento del contenido energético del pienso aumentó linealmente la GMD de los cerdos, mientras que otros autores (Cerisuelo et al., 2012) no detectaron diferencias significativas.

Estas discrepancias pueden deberse a variaciones en la genética de los animales y de las materias primas utilizadas, así como en los niveles de energía y AA suministrados, lo que podría explicar las diferencias en los resultados observados.
Los efectos del contenido de EN en la dieta sobre la calidad de la canal y la carne de los cerdos no están claros.
Paiano et al. (2008) y Cámara et al. (2014) observaron que el aumento en la concentración de EN en la dieta aumentó la deposición de grasa en la canal en cerdos sacrificados con 120 kg de peso vivo.
Por el contrario, Kerr et al. (2003) y Apple et al. (2004) no detectaron diferencias en la calidad de la canal y de la carne en cerdos sacrificados a 110 y 106 kg de peso vivo, respectivamente.

El objetivo de este trabajo fue estudiar la influencia del contenido de EN de piensos con niveles similares de PB sobre los rendimientos productivos y la calidad de la canal en cerdos Pietrain sacrificados a los 160 días de edad.
En total, se utilizaron 480 cerdos (67 ± 2,8 d de edad y 25,6 ± 2,9 kg de peso vivo) que fueron distribuidos en grupos de 10 cerdos por corral, en un total de 48 corrales (2,48 m x 4,13 m) en una granja comercial.
Los cerdos tuvieron libre acceso a pienso y agua fresca durante todo el experimento.

Desde los 67 a los 95 días de edad (25,6 a 48,0 kg de peso vivo, de media), los cerdos fueron alimentados con una dieta común a base de cebada, trigo y harina de soja, que contenía 2.460 kcal EN/kg y 1,07% de Lys digestible.
A los 95 días de edad, los cerdos se pesaron individualmente y cada corral fue asignado al azar a uno de los cuatro tratamientos experimentales (n = 12), en base a la EN del pienso.

El programa de alimentación consistió en dos periodos experimentales (95 a 133 días y 134 a 160 días de edad), con variaciones en el contenido de EN (2.340, 2.390,2.450, 2.500 kcal/kg) del pienso, manteniendo constante la relación AA:EN (Tabla 1).





Ingredientes (%)

1Incluye cloruro sódico, carbonato cálcico, fosfato monocálcico y corrector
2 Según FEDNA (2019)
3 Fibra neutro detergente
Tabla 1. Ingredientes y composición química de los piensos experimentales.
A medida que aumentó la concentración de EN de los piensos, se incrementó el nivel de inclusión de grasa a expensas del trigo, principalmente.
Para mantener un nivel similar de excreción de N, los piensos dentro de cada periodo fueron formulados con un contenido similar de PB (16,0% de 95 a 133 días y 15,4% de 133 a 160 días de edad), por lo que el nivel de inclusión de los AA cristalinos varió entre tratamientos.
La relación Lys:EN (g/Mcal) fue de 4,34 y 4,05 para los piensos suministrados de 95 a 133 días y de 133 a 160 días de edad, respectivamente.
Todos los demás AA indispensables se formularon según el concepto de proteína ideal (FEDNA, 2019) y todos los piensos experimentales se presentaron en forma de gránulo.

Al finalizar el periodo experimental, los cerdos fueron trasladados al matadero para evaluar el efecto del tratamiento sobre la calidad de la canal.


Levadura viva para monogástricos

PARA SU USO EN TODO EL CICLO PRODUCTIVO DEL CERDO
LEVUCELL SB es una levadura viva probiótica especialmente seleccionada para su uso en monogástricos.
LEVUCELL SB tiene una gran base científica y resultados comprobados en granjas que demuestran su capacidad para apoyar una microbiota intestinal equilibrada y mejorar el rendimiento de los cerdos a lo largo de su ciclo de producción.
LEVUCELL SB TITAN se beneficia de una tecnología patentada de microencapsulación con un proceso de recubrimiento específico que garantiza una protección óptima de las células de levadura vivas durante la granulación.
No todos los productos están disponibles en todos los mercados, ni todas las alegaciones asociadas están permitidas en todas las regiones.
El aumento de la EN del pienso no tuvo efecto sobre el peso de los cerdos a los 133 días o a los 160 días de edad, con promedios de 81,3 y 103,8 kg de peso vivo, respectivamente (Tabla 2).
Sin embargo, durante ambos periodos experimentales, el aumento en el contenido energético de la dieta redujo el CMD (P < 0,001) y mejoró el índice de conversión (P < 0,001) linealmente, sin que la GMD o el consumo energético se vieran afectados.
Rendimientos productivos (95 a 160 d de edad)
El contenido en EN del pienso tuvo un efecto limitado sobre la calidad de la canal (Tabla 3). El único efecto observado fue en el rendimiento de paleta fresca, que varió cuadráticamente con valores superiores en los cerdos alimentados con 2.450 kcal EN/kg (P < 0,01).
En resumen, un aumento del 6,8% en la concentración de EN del pienso (de 2.340 a 2.500 kcal/kg) manteniendo constante la relación AA:EN mejoró el índice de conversión un 9,1%, pero no afectó a la GMD ni a la calidad de la canal de los cerdos.

Consumo medio diario, 4Ganancia media diaria
Efecto de la concentración energética del pienso sobre los rendimientos productivos de 95 a 160 días de edad.

fresco
Paleta fresca

Dietas isoproteicas con diferente concentración energética: efectos sobre los rendimientos productivos y calidad de la canal en cerdos en cebo DESCÁRGALO EN PDF
Referencias disponibles en la versión web del artículo en nutrinews.com
Por lo tanto, los resultados de este estudio sugieren que el incremento en el contenido de EN del pienso con el objetivo de mejorar el crecimiento y la calidad de la canal de los cerdos podría no estar justificado en todas las circunstancias.
Es importante tener en cuenta que los resultados obtenidos pueden variar en función de los ingredientes utilizados y el rango de EN considerado, ya que ambos factores pueden afectar directamente a los resultados productivos.
Gerardo Ordaz Ochoa, María Alejandra Pérez Alvarado, Luis Humberto López Hernández Centro Nacional de Investigación Disciplinaria en Fisiología y Mejoramiento Animal, INIFAP, México
La alimentación adecuada tanto de las cerdas que integran el hato reproductor como de los verracos es fundamental para garantizar la salud y el rendimiento reproductivo en la producción porcina. Sin embargo, el creciente uso de grasas oxidadas en la dieta del hato reproductor con el supuesto objetivo de reducir costos en la alimentación genera incertidumbre por sus repercusiones en la salud y la reproducción.
En el procesamiento y almacenamiento de los alimentos, especialmente aquellos ricos en lípidos, se puede inducir reacciones de oxidación en las grasas (Factores que ya fueron abordados en ediciones anteriores de porciNews Latam). Estudios han demostrado que el consumo de grasas oxidadas puede tener efectos adversos en la salud reproductiva de los animales.
Por ejemplo, la oxidación de lípidos puede provocar estrés oxidativo en los tejidos, lo que se asocia con daño celular y disfunción reproductiva (Yang et al., 2023).


El estrés oxidativo en los tejidos de cerdas reproductoras, asociado al consumo de grasas oxidadas, se debe a la producción excesiva de especies reactivas de oxígeno (ROS, por sus siglas en inglés) y a la disminución de los niveles de antioxidantes endógenos (Figura 1; Su et al., 2017).
no oxidado
no oxidado + antioxidante
Vitamina E en suero Vitamina C en suero
Los lípidos oxidados en la dieta pueden aumentar los niveles de peroxidación lipídica en los tejidos de las cerdas, lo que conduce a la acumulación de productos de oxidación y daño en las membranas celulares (Luo et al., 2018), repercutiendo directamente en:

1 2 3 4
Reducir la calidad de los óvulos
Reducir la tasa de concepción
Aumentar la incidencia de abortos
Trastornos del ciclo estral

Figura 1. Niveles de Vitaminas E y C, glutatión peroxidasa (GPx) y superóxido dismutasa (SOD) total en cerdas reproductoras de acuerdo con el tipo de aceite y adición de antioxidantes. Modificado de Su et al., 2017.
Además, el estrés oxidativo puede afectar la función endocrina de las cerdas, alterando la producción y liberación de hormonas reproductivas.
La exposición a grasas oxidadas puede alterar la expresión génica relacionada con la síntesis hormonal y función metabólica en las cerdas, lo que puede comprometer más su salud reproductiva (Valle et al., 2009).
Estos hallazgos resaltan la importancia de evitar el uso de grasas oxidadas en la alimentación de cerdas reproductoras para preservar su salud reproductiva.
En el proceso de oxidación de las grasas se producen compuestos tóxicos, como aldehídos y peróxidos, que pueden interferir con varios procesos fisiológicos, incluida la reproducción. Para tal caso, existe una asociación entre el consumo de grasas oxidadas y una disminución en la tasa de concepción en cerdas (Zeng et al., 2023).

Las cerdas alimentadas con dietas ricas en grasas oxidadas tienen una tasa de concepción significativamente menor en comparación con aquellas alimentadas con dietas elaboradas con grasas de buena calidad (no oxidadas).
Varios mecanismos pueden explicar cómo los compuestos tóxicos generados por la oxidación de las grasas afectan la fertilidad de las cerdas, entre ellos se destacan:
1
Afectación negativa de la homeostasis hormonal de los animales, alterando la producción y la liberación de hormonas clave involucradas en la reproducción, por ejemplo, estradiol y progesterona.
2 3
Reducción del consumo de alimento en lactancia demeritando la condición corporal de la hembra, ello a su vez propicia baja viabilidad de los óvulos y, por lo tanto, menor fertilidad en el siguiente ciclo reproductivo (Figura 2).
Respuestas inflamatorias en el organismo, lo que a su vez puede afectar la salud del tracto reproductivo y la viabilidad de los óvulos y espermatozoides.


Consumo de alimento/día en lactancia, kg pérdida de grasa dorsal en lactancia, mm
Consumo de alimento Pérdida de grasa dorsal

Porcentaje de los componentes nutricionales de la leche
6,0 5,0 4,0 3,0 2,0 1,0 0,0 Peso del lechón, kg
Peso del lechón al nacimiento
Peso del lechón al destete
Figura 2. Desempeño productivo de la cerda y el lechón durante la lactancia y calidad de la leche de las cerdas de acuerdo con el tipo de aceite y adición de antioxidantes. Modificado de Su et al., 2017.
Rendimiento optimizado


Mayor resistencia a los desafíos
Asociación única de extractos de macroalgas biológicamente activos (MSP ® )

La calidad de la descendencia es crucial para el éxito de la producción porcina, y la alimentación materna juega un papel fundamental en su desarrollo.
El consumo de grasas oxidadas por parte de las cerdas reproductoras tiene repercusiones en la calidad de la descendencia, tanto en términos de viabilidad como de rendimiento productivo.
Se ha reportado (Xu et al., 2021) que la exposición prenatal a grasas oxidadas puede afectar el desarrollo fetal y la viabilidad neonatal en cerdos, por:
El aumento en la incidencia de malformaciones congénitas y disminución en el peso al nacer en las camadas de cerdas expuestas a dietas con grasas oxidadas (Gao al., 2023).
Alterar la expresión génica y la función metabólica en la descendencia, lo que puede tener efectos a largo plazo en su salud y rendimiento productivo (Zeng et al., 2023).

Dichas afectaciones de la calidad de la descendencia de cerdas que consumieron dietas ricas en grasas oxidadas se pueden asociar en parte a:

Los compuestos tóxicos que pueden tener efectos negativos en el desarrollo fetal, interfiriendo con la formación de órganos y sistemas importantes.
El consumo de grasas oxidadas puede tener varios efectos adversos en la salud reproductiva de los verracos, afectando la calidad del semen y la función testicular (Zeng et al., 2023).
Aumentar la susceptibilidad de los lechones a enfermedades y trastornos metabólicos en la etapa postnatal.
Reducción de la motilidad espermática

Disminución de la concentración espermática

Mayor incidencia de anomalías espermáticas
Los mecanismos detrás del efecto negativo del consumo de grasas oxidadas en verracos aún no se comprenden completamente, pero se han reportados sus efectos debido a:
El estrés oxidativo en el organismo afecta la salud celular y la función de los órganos reproductivos.
Afectación de la síntesis

El estrés oxidativo en el organismo afecta la salud celular y la función de los órganos reproductivos.
Afectación de la síntesis hormonal y la función testicular, lo que resulta en una reducción en la producción y la calidad del semen. La oxidación de las grasas puede afectar la síntesis de lípidos esenciales para la integridad de las membranas celulares, lo que afecta la función espermática.

La oxidación de las grasas


En AuxiTech Feed Additives desarrollamos aditivos tecnológicos con el fin de optimizar el rendimiento en el proceso de fabricación de pellet de pienso y aumentar la bioseguridad.
Aditivo diseñado para mejorar el acondicionamiento y la humedad final del pienso con el fin de obtener un pellet seguro y de calidad, y a la vez reducir el consumo de energía durante el proceso de pelletización.
Potente bactericida de amplio espectro diseñado para uso en materias primas y en piensos.
Aditivo para el control fúngico en materias primas y piensos durante el almacenamiento.
El estrés oxidativo inducido por el consumo de grasas oxidadas en la dieta de las reproductoras y los verracos induce una menor eficiencia reproductiva y productiva para la industria porcina.
Por lo que, se destaca la necesidad de una mayor atención a:
La calidad de la grasa implementada en las dietas.
Almacenamiento adecuado de la materia prima.
Adecuada formulación de los alimentos para reproductores.

Es crucial implementar la suplementación de antioxidantes más allá de reducir la oxidación en el alimento, sino en aminorar reacciones oxidativas en el animal producidas por otros factores estresantes.
Por lo que, se requieren más investigaciones que aumenten la comprensión de los mecanismos detrás de los efectos adversos de las grasas oxidadas sobre indicadores reproductivos de las cerdas y verracos, así como el desarrollar estrategias efectivas para mitigar estos efectos.

Referencias disponibles en la versión web del artículo en nutrinews.com
El uso de grasas oxidadas en la alimentación de cerdas reproductoras y verracos puede tener importantes repercusiones en la salud y comportamiento reproductivo, así como en la calidad de la descendencia en la producción porcina.

El uso de grasas oxidadas en la alimentación porcina: el hato reproductor. Parte 2
DESCÁRGALO EN PDF
Los efectos adversos incluyen la disminución de la tasa de concepción, mayor incidencia de abortos y trastornos reproductivos, así como el impacto negativo en la viabilidad y el rendimiento de la descendencia.
Por lo tanto, es crucial adoptar prácticas alimentarias que minimicen la exposición de los reproductores a grasas oxidadas, garantizando así la salud y el éxito reproductivo.
Dr. Yron MANAIG
I+D de Animine
El manejo de lechones ligeros se ha convertido en una habilidad crucial en las operaciones porcinas modernas. Teniendo en cuenta su mayor mortalidad y su lenta tasa de crecimiento, las prácticas de manejo adecuadas deben ir acompañadas de una estrategia nutricional correcta.
Dado que estos lechones consumen una cantidad muy baja de alimento, cualquier gramo ingerido debería proporcionar el perfil y la densidad de nutrientes óptimos.
Entre estos nutrientes, los oligoelementos son esenciales para el desarrollo de tejidos y órganos, así como para la función inmunológica, la integridad intestinal y la mitigación de la inflamación. Hoy en día, la fuente potenciada de zinc de última generación puede desempeñar perfectamente ese papel.


La intensa presión por una selección genética de hiperprolificidad, basada en el rendimiento reproductivo de las cerdas, ha llevado a un aumento constante en el tamaño de la camada en las últimas tres décadas.
Hemos dado un nuevo paso con el auge de la última generación de cerdas hiperprolíficas en el mercado procedentes del norte de Europa, como las razas Topigs Norsvin 70 o Danbred.

Hoy en día, se pueden ver camadas de hasta 20 lechones por cerda en granjas porcinas comerciales, algo cada vez más común en todo el mundo.

El primer inconveniente de seleccionar por tamaño de camada grande es la reducción del peso promedio al nacer de los lechones, así como un aumento en la variabilidad de los pesos al nacer dentro de la camada.
Esto ha resultado en un aumento notable de la proporción de lechones pequeños en camadas grandes, así como en la frecuencia de lechones con restricción del crecimiento intrauterino (RCIU).
Estos retrasos pueden implicar dificultades de manejo y mayores costos de mano de obra y equipos durante las fases posteriores al destete.
Desafortunadamente, las consecuencias negativas también pueden ser duraderas, ya que pueden resultar en sanciones financieras al sacrificio si los individuos continúan presentando especificaciones de clasificación deficientes.

¿Es la rentabilidad de los lechones ligeros un desafío?
Algunos estudios recientes han registrado una mayor tasa de mortalidad en lechones de bajo peso al nacer.
Por ejemplo, en dos estudios que participaron un total de 4.000 lechones en granjas europeas, con un peso medio al nacer de 1,5 kg, el 15 % de los lechones tenían un peso al nacer inferior a 1,1 kg, y el 34 % de estos lechones murieron antes del destete.
En comparación, la tasa de mortalidad de los lechones más pesados fue de alrededor del 8%.
A nivel mundial, el 40-50 % de la mortalidad total antes del destete puede estar asociada con los lechones de BPN, aunque estos representan solo el 15 % de los lechones nacidos.
Durante las fases posteriores al destete, la mortalidad en el grupo de BPN también tiende a ser mayor que en el grupo de peso normal al nacer (PNN).
Además, el rendimiento de crecimiento de los lechones de BPN es generalmente pobre. En un estudio realizado en la Universidad de Bolonia, el 84 % de los lechones de BPN (< 1 kg al nacer) pesaban menos de 7 kg al destete, en comparación con el 12,5 % de los lechones de PNN (> 1 kg al nacer).
De manera similar, Schothorst Feed Research realizó un análisis en 34.500 lechones entre 2016 y 2021: el 13 % de los lechones tuvo un peso al nacer inferior a 1 kg, y el 40 % de estos lechones murió durante el período previo al destete.

Figura 1: Distribución de los lechones al destete, según su categoría de peso al nacer.
El retraso en el crecimiento no fue totalmente compensado durante la fase post-destete. Este resultado ha sido confirmado en la literatura:
en los estudios realizados hasta el sacrificio, la ganancia diaria promedio es significativamente menor en los grupos de BPN en comparación con los grupos de PNN.

Estas citocinas pueden inducir la interrupción de las uniones estrechas y disminuir la integridad del epitelio intestinal.
La mayor tasa de mortalidad y la menor ganancia de peso pueden explicarse en parte por los daños inflamatorios causados a la mucosa intestinal.
El proceso de destete siempre se asocia comúnmente con un estado de inflamación elevado

la inducción de genes de señalización de NF-κB
Este viene acompañado de una mayor producción de citocinas proinflamatorias (como TNF-α, IFN-γ y IL-6)
Algunos ensayos han mostrado que la expresión génica de las citocinas proinflamatorias es mayor en los lechones de BPN en comparación con los lechones de PNN, tanto durante la fase de lactancia como después del destete.
A pesar de los avances tecnológicos en la producción porcina intensiva, el bajo peso corporal al nacer y la alta variación dentro de la camada siguen siendo dos de los factores más importantes que afectan la rentabilidad en la cadena de producción porcina.
Esta es la razón por la cual las granjas comerciales modernas a menudo deciden sacrificar lechones con RCIU, ya que no existe un apoyo nutricional o de manejo efectivo que garantice su crecimiento o supervivencia durante los períodos de lactancia y post-destete.
Por lo tanto, se debe reconsiderar un manejo nutricional específico y prestar especial atención a la alimentación nutricional de los neonatos alrededor del destete.

Algunas fuentes de Zn también han mostrado resultados positivos a nivel nutricional.
Para evaluar una fuente potenciada de Zn (HiZox®), se realizó un ensayo con 64 lechones destetados, divididos en dos grupos:
Lechones de BPN (< 1 kg al nacer) y lechones de PNN (> 1 kg al nacer).
Se comparó la fuente de Zn potenciado con una fuente de Zn estándar (ZnSO 4) a la misma dosis, la dosis máxima autorizada en la Unión Europea (120 ppm de Zn suplementado) durante la fase post-destete.
El peso corporal de los lechones PNN fue significativamente mayor hasta el final del experimento.
El Zn potenciado tendió a aumentar la ganancia de peso 2 semanas después del destete, tanto en el grupo BPN (+8%) como en el grupo PNN (+6%).
Además, disminuyó significativamente la expresión génica de NF-κB, mostrando un efecto positivo en el estado inflamatorio de los lechones, especialmente en lechones de BPN.
El manejo de lechones ligeros se está convirtiendo en una práctica común en todo el mundo. Actualmente, se estima que al nacer, el 15% de los lechones pesan menos de 1 kg. Su tasa de supervivencia y su aumento de peso representan un verdadero desafío.
Sin embargo, las empresas nutricionales modernas están investigando nuevas estrategias para mejorar el manejo de estos individuos.
La suplementación con una fuente de Zn de alta biodisponibilidad puede disminuir la inflamación intestinal y aumentar el rendimiento de crecimiento de los lechones de bajo peso al nacer después del destete.
Manejo de lechones pequeños: ¿Cómo evitar llegar al sacrificio?
DESCÁRGALO EN PDF

MANGANESO

MANGANESO





Para cualquier mamífero el momento del destete supone una de las situaciones de estrés más importantes de su ciclo vital. El porcino no es una excepción y los lechones sufren un gran nivel de estrés en el momento del destete.
Por ello, conocer qué genera estrés en los lechones y qué consecuencias tiene resulta muy útil para poder solucionar los problemas que puedan aparecer a posteriori.
Departamento Técnico Biocidas ZIX®
En el momento del destete, el lechón se enfrenta a muchos y notables cambios que condicionan su salud, bienestar y rendimiento productivo posterior.
Desde el punto de vista del grado de estrés, el factor más importante posiblemente sea la caída de consumo de pienso en el momento del destete, lo que conlleva las siguientes consecuencias:
Reducción de la altura de las vellosidades intestinales (Figura 1)
Cambios enzimáticos
Cambios en la microbiota
La Figura 1 ilustra el cambio que se produce en la estructura del intestino delgado del lechón cinco días después del destete en comparación con antes del destete (Pluske, 1995).

Figura 1. Cambios en la longitud de las vellosidades intestinales del lechón antes y después del destete.
Antes del destete: Vellosidades intestinales largas
5 días después del destete: Vellosidades intestinales cortas
El agua tiene una importancia vital en el momento del destete, no solo su cantidad, sino también su calidad, ya que es el principal sustituto de la leche en el momento del destete y además es un estimulante de consumo.

Siempre se debe aportar agua de calidad, correctamente higienizada, pero en la fase de destete este punto cobra especial importancia, ya que nos encontramos ante animales jóvenes con un sistema digestivo poco desarrollado y muy sensible a los patógenos potenciales.
En los últimos años se ha concedido mucha importancia a la salud intestinal, con un creciente interés por determinar la composición ideal de la microbiota intestinal, habiéndose observado que el aumento del estrés postdestete aumenta el porcentaje de E. coli en relación al de Lactobacillus.
Este hecho implica una posible colonización de otros patógenos y la absorción de toxinas que generan. Por tanto, asegurar el consumo de pienso lo antes posible es una de las normas más importantes en la fase de postdestete.
Los lechones deben tener un acceso fácil al pienso. Por ello, se recomienda usar los mismos comederos
El alimento que se ofrece en maternidades debe ser el mismo que se ofrece en el postdestete. De esta forma reducimos la cantidad de novedades a las que se enfrenta el lechón. 1 2
GMD: Ganancia Media Diaria
CMD: Consumo Medio Diario
Gráfica 1. Correlación entre el consumo de pienso la primera semana postdestete y la ganancia de peso durante las 5 primeras semanas postdestete (Adaptado de Bruininx, E.M. y col., 2002).
El agua es un factor predisponente, cuantitativa y cualitativamente, de una serie de patologías de diversas etiologías (bacteriana, vírica, parasitaria y química), por lo que es un elemento clave en todo programa de bioseguridad y un punto crítico que debe formar parte de todo APPCC
El control de la calidad del agua de bebida es importante por rentabilidad y seguridad. Además, es uno de los parámetros básicos de certificación de una granja, por lo que se debe normalizar, protocolizar y realizar la trazabilidad de la misma.

AQUAZIX® PLUS Ag es un producto basado en peróxido de hidrógeno, plata y núcleo Enterozix®.
Permite obtener agua de gran calidad microbiológica por la gran eficacia biocida del peróxido de hidrógeno potenciado además por la plata.
Contribuye a fortalecer el sistema inmunitario de los cerdos, potenciando la sanidad intestinal e impidiendo la colonización digestiva de cualquier tipo de microorganismo patógeno.
Contribuye a mantener los sistemas de distribución de agua en condiciones óptimas.
El impacto que conllevan los cambios sociales es el más evidente pero el más difícil de gestionar.
La separación de la madre es básica para el ritmo lógico en producción porcina y no se puede entender una granja sin un ritmo reproductivo de, como mínimo, 2,4 partos/ cerda y año.
Para ello, es necesario destetar al lechón de forma precoz, con 21 a 28 días es lo más común, pero en ambos casos es precoz.
En condiciones naturales, un lechón se desteta progresivamente y va ingiriendo alimentos sólidos junto con la leche materna.
De hecho, tenemos experiencias en explotaciones de cerdos criados en condiciones más naturales de lactaciones de 70 días, pero el momento del destete sigue siendo, aún en esas condiciones, un estrés.
Conocer cómo influyen los factores implicados y cómo prevenirlos en el momento de separación de la cerda ayudará a minimizar el estrés social.
PROMOVER EL CONSUMO GRADUAL DE PIENSO
En primer lugar, se debe conseguir que la ingesta sea varias veces al día, tomando pequeñas cantidades de alimento como si la cerda los llamara a tetar. Es algo natural y no es fácil de reproducir, pero es importante.
EVITAR LA COMPETENCIA POR EL ALIMENTO
Evitar la mezcla de lechones y respetar el grupo sería muy deseable, pero es prácticamente imposible en las condiciones de producción que se plantean.
De hecho, las condiciones de hiperprolificidad ya nos obligan a mezclar desde el día del nacimiento y eso poco o nada tiene que ver con las condiciones naturales en las que la camada se conserva intacta hasta el destete a los 70 días.
Todas las medidas que se adopten para minimizar los movimientos y mezclas reducirán el estrés derivado de la competencia por el recurso del alimento.
Los corrales deben contar con comederos y bebederos suficientes y adecuados, ya que ello contribuirá a minimizar las luchas jerárquicas que se producen al mezclar animales.
Recordemos que los lechones están acostumbrados a comer y beber al mismo tiempo en las maternidades, por lo que no deben faltar tolvas, platos y bebederos o puntos de agua para esos primeros días.
Las condiciones ambientales también son clave para que el lechón se encuentre confortable en el momento del destete, siendo la temperatura, humedad y calidad del aire en relación a la presencia de gases nocivos (NH3 , CO2, CO, etc.). parámetros fundamentales que se deben monitorizar y controlar.
En el momento postdestete la temperatura crítica superior e inferior (temperaturas óptimas de confort climático del lechón fuera de las cuales hay una afectación de los parámetros productivos del animal) se aproximan y el margen permitido es muy escaso.
Evitar las corrientes de aire es clave para lograr una buena sensación térmica y garantizar el confort del lechón.
Es importante tener en cuenta que alcanzar la temperatura correcta no es sinónimo de una calidad ambiental óptima, ya que, si los diseños no son correctos, se pueden producir corrientes que generen unas condiciones desfavorables para el lechón.
Los reguladores de temperatura de las salas y las mantas deben funcionar correctamente y de acuerdo con la curva de temperaturas propuesta para cada sistema productivo y para cada momento del crecimiento del lechón.
A continuación, se recomiendan unas condiciones ambientales óptimas para el lechón en función de su edad y si nos encontramos en verano o invierno en una explotación con ventilación forzada (Tabla 1).
Tabla 1. Recomendaciones de temperatura y ventilación a lo largo de la fase de postdestete en función del día de destete y la estación del año (Adaptado de Quiles y Hevia, 2006).
Para garantizar unas buenas condiciones ambientales es fundamental tener en cuenta la concentración de gases nocivos, pudiendo usar como referencia los valores que se muestran en la Tabla 2.
Tabla 2. Concentración máxima de gases en alojamientos para animales (norma CIGR, recomendación internacional medida como concentración en volumen) (Fuente: 3tres3).
Hoy en día, se recomienda que las explotaciones cuenten con sistemas de control basados en reguladores que controlen de forma automática todos estos parámetros, así como sistemas de alarmas que avisen de cualquier desviación.
Los lechones cambian de instalaciones en el proceso del destete, teniendo las parideras unas estructuras que en la granja de destete serán diferentes.
Es de suma importancia que las naves donde se reciben los lechones hayan pasado previamente por una buena limpieza y desinfección que permita una higiene óptima de la explotación.
Una vez realizada la limpieza, es el momento de combatir los microorganismos mediante la aplicación de productos desinfectantes:
De amplio espectro.
Con un mecanismo de acción inespecífico que evite la aparición de resistencias.
Que sean respetuosos con los animales, el personal y el medioambiente.
Para ello, Biocidas ZIX® cuenta con los productos desinfectantes Virox® (monopersulfato en forma de polvo) y Zix® Virox (combinación sinérgica de peróxidos y ácido peracético en forma líquida).
Recomendaciones de Biocidas ZIX® para maximizar una limpieza y desinfección óptima
Limpieza con detergente alcalino
Como primer paso, es necesario llevar a cabo una correcta limpieza con un detergente alcalino capaz de arrastrar la materia orgánica que cubre y alberga microorganismos.
Recomendamos el uso del detergente de Biocidas ZIX® (Clean Zix® Espumante) para realizar una correcta desincrustación de la materia orgánica y así exponer todas las partes de la granja para que los desinfectantes puedan actuar sobre el mayor número de microorganismos posible.
Estos productos cuentan con un mecanismo de acción por oxidación que es inespecífico y, por tanto, de amplio espectro y totalmente biodegradable.
La minimización y/o eliminación de estos momentos de estrés ayudará a que los animales afronten sus nuevas etapas en perfectas condiciones de salud.
En cambio, si los momentos de estrés no se controlan y no se trabaja en la prevención, la capacidad de defensa de los animales disminuirá, provocando problemas sanitarios mayores.
Impacto del destete y el estrés en el lechón
DESCÁRGALO EN PDF



• Favorece el equilibrio de la microbiota intestinal
• Mantiene la sanidad del sistema digestivo
• Mejora la fisiología digestiva
• Mejora los parámetros productivos
• Disminuye el uso de antibióticos
John K. Htoo 1, Graziela Alves da Cunha Valini 2, Luciano Hauschild 2 1Evonik Operations GmbH, Alemania, 2Universidad Estadual Paulista (Unesp), Brasil

IMPACTO DEL ESTADO SANITARIO EN EL RENDIMIENTO DE LOS CERDOS
En la producción porcina comercial, los cerdos en crecimiento a menudo están expuestos a niveles crónicos subclínicos de enfermedades que producen una bajada en la ingesta de alimento y un rendimiento por debajo del potencial genético.
Las diferencias en el estado de salud son una de las principales razones de las grandes variaciones en los niveles de rendimiento porcino entre las granjas comerciales (Pastorelli et al., 2012).


El sistema inmunológico se activa cuando los cerdos están expuestos a patógenos como E. coli, Salmonella sp., o se crían en malas condiciones sanitarias. Después de la eliminación de APC (antibióticos promotores de crecimiento) en el alimento, los cerdos muestran más signos de problemas de salud, como diarrea y crecimiento subóptimo.
En estas condiciones de salud, los requerimientos de algunos aminoácidos funcionales (AA) se incrementan porque se utilizan cada vez más para las funciones metabólicas involucradas en la respuesta inmune en lugar del crecimiento (Reeds y Jahoor, 2001).
Algunos aminoácidos funcionales como la treonina (Thr), la metionina (Met) y el triptófano (Trp) no solo se utilizan para la síntesis de proteínas, sino que también participan en las funciones inmunitarias.

La treonina desempeña un papel clave en la función inmunitaria a través de su incorporación a la producción de inmunoglobulinas y mucinas.
La metionina sirve como donante de grupos metilo para procesos importantes como la metilación del ADN, la síntesis de poliaminas y es un precursor de la cisteína (Cys), que es necesaria para la síntesis de un importante antioxidante, el glutatión.
El triptófano está implicado en la función inmunitaria y en la producción de serotonina.

En la actualidad, los piensos comerciales para cerdos se producen sobre la base de proporciones ideales constantes de AA para optimizar el crecimiento, pero no tienen en cuenta el aumento de la utilización de algunos AA para la función inmunitaria inducida por un desafío.
Investigaciones recientes han demostrado que el aumento de las proporciones de Thr, Met + Cys y Trp, con respecto a Lys, puede aliviar los efectos adversos de los problemas de salud en el rendimiento de los cerdos destetados (Rodrigues et al., 2021).
Los efectos de un mayor suministro de aminoácidos en condiciones adversas para el sistema inmunitario de cerdos en crecimiento siguen siendo poco conocidos. Por ello, llevamos a cabo un estudio de desafío inmunológico de 28 días con cerdos en crecimiento, con un peso vivo de entre 25 y 50 kg.
Se asignaron 120 cerdas [Pietrain × (Large White × Landrace)] con un peso corporal inicial de 25,4 kg en un diseño factorial 2×2, compuesto por dos condiciones sanitarias (Bueno o Pobre) y dos niveles de AA.
Se elaboraron dos dietas a base de maíz, harina de soya y aminoácidos cristalinos.
La dieta control (CON) fue equilibrada para el perfil de AA según NRC (2012), mientras que la dieta aumentada de AA (AA+) se complementó con AA para contener un 20% más de proporciones estandarizadas de Trp:Lys, Thr:Lys y Met+Cys:Lys que la dieta CON. +20%
En la Tabla 1 se muestran las proporciones PB, SID Lys, Trp:Lys, Thr:Lys y Met + Cys:Lys.
PB, % 16,5 16,7
Energía neta, MJ/kg 10,7 10,7
SID Lys, % 0,98 0,98
SID Thr:Lys, % 60 71
SID Met+Cys:Lys, % 56 67
SID Trp:Lys, % 17 20
Tabla 1. Energía, contenido de proteína bruta (PB) y proporciones de AA en las dietas de los cerdos de engorde
Los cerdos se alojaron en dos salas (60 cerdos/sala) en el Centro de Investigación Porcina de la Universidad Estatal de Sao Paulo, Brasil. Cada sala estaba equipada con cuatro alimentadores automáticos de precisión.
Los cerdos disponían de un crotal individual de radiofrecuencia para acceder a los comederos. El comedero identifica al cerdo cuando este introduce su cabeza, y a continuación suministra la dieta experimental asignada (CON o AA+).

Para asegurarse de que los cerdos se encuentran en condiciones de inmunodesafío, los cerdos en condiciones sanitarias pobres fueron desafiados con Salmonella Typhimurium (ST, 2×10 9 UFC) en el día 0 para inducir una respuesta inmunitaria. Además, se esparció en el suelo el estiércol fresco de una granja porcina comercial y se mantuvo sin limpiar durante los 28 días que duró la prueba.
Por el contrario, los cerdos en buenas condiciones sanitarias no se enfrentaron a Salmonella Typhimurium, y la sala se limpió dos veces al día.
El peso corporal individual de los cerdos se registró semanalmente y la ingesta diaria individual de alimento (kg/d) fue medida por los alimentadores. Se midió la masa corporal total, magra y grasa un día antes del desafío (día -1) y a los 28 días después del desafío (dpc) mediante densitometría (dual-energy X-ray absorptiometry). La excreción de nitrógeno (g/d) se obtuvo para cada cerdo escaneado restando la retención de nitrógeno (N) de la ingesta de N.
En este estudio, los cerdos criados en condiciones sanitarias pobres presentaron un aumento de la temperatura rectal (datos no mostrados) y una peor puntuación fecal, presentando diarrea transitoria.
Se observó una puntuación fecal más alta a 5 dpc en comparación con 7, 14 y 21 dpc. Sin embargo, el aumento de las proporciones de AA mejoró la puntuación fecal en comparación con la dieta CON a 14 dpc en condiciones sanitarias deficientes (Figura 1).
7 14 Días post-desafío
*Puntuaciones fecales: 0 = Normal, 1 = semisólida, 2 = semisólida-acuosa y 3 = heces acuosas.
Figura 1. Efecto del aumento de las proporciones de aminoácidos en las puntuaciones fecales medias de cerdos en crecimiento en condiciones de desafío sanitario deficientes en los días 5, 7, 14 y 21 después del desafío*


En los cerdos expuestos a las malas condiciones higiénicas, los parámetros inmunes séricos se vieron afectados.
A 7 dpc, las concentraciones séricas de haptoglobina (proteína de fase aguda positiva) y urea fueron mayores, mientras que las concentraciones de albúmina (proteína de fase aguda negativa) y proteína total fueron menores en comparación con los cerdos no desafiados (Figura 2).
Los cerdos alimentados con dieta AA+ tenían una mayor concentración de albúmina sérica (P < 0,05) y tendían a tener niveles más bajos de urea (P < 0,10) comparados con los alimentados con la dieta CON, lo que indica los efectos de mejora inmunológica de AA.
Durante todo el período experimental de 28 días, los cerdos criados en condiciones sanitarias deficientes tuvieron una ganancia diaria promedio (GMD), una ingesta diaria promedio de alimento (ADFI), un ratio ganancia:alimento (G:F), y un peso corporal más bajo, así como una menor deposición diaria de proteínas corporales y lípidos en comparación con los cerdos no desafiados (Tabla 2).
Cuando los cerdos están sometidos a un desafío inmunológico, el aumento de la relación SID
Thr:Lys, Met+Cys:Lys y Trp:Lys al 120% de NRC (2012) aumentó la GMD (+ 17%) y mostró una tendencia a una mayor G:F (+ 15%), mayor peso corporal final (+ 7%) y mayor deposición de proteínas (+ 17%) en comparación con los alimentados con dieta CON. En condiciones de no-desafío (buenas), el aumento de AA solo tendió a aumentar el parámetro G:F (+ 5%).
Sanitation: P<0.01
P=0.05
Sanitation: P<0.03
P=0.08
Sanitation: P<0.01 AA: P=0.48
Sanitation: P<0.05
Figura 2. Efecto del aumento de las proporciones de aminoácidos en los biomarcadores inmunes en sangre de cerdos en crecimiento en condiciones sanitarias óptimas o pobres en el día 7 después del desafío
Buen Estado Mal Estado

*SD residual.
a,b Diferentes letras minúsculas indican la diferencia entre tratamientos mediante la prueba de Tukey (P ≤ 0,05).
x,y Diferentes letras minúsculas indican la tendencia entre tratamientos por la prueba de Tukey (0,05 < P < 0,10).
Tabla 2. Efecto del aumento de las proporciones de aminoácidos sobre el rendimiento y la deposición corporal de proteínas y lípidos en cerdos en crecimiento en condiciones sanitarias buenas o pobres durante 28 días.
En cuanto al balance de nitrógeno, los cerdos desafiados mostraron una menor ingesta de N y una menor eficiencia de retención de N (%) en comparación con los cerdos no desafiados (Figura 2).
Sin embargo, el aumento del suministro de AA mejoró la eficiencia de retención de N (+7%) de los cerdos criados en malas condiciones sanitarias, sin afectar la eficiencia del N en los cerdos no desafiados. Las mejoras en el rendimiento y la retención de proteínas corporales indican que los AA funcionales Thr, Met y Trp deben aumentarse para que no se vuelvan limitantes para la función del sistema inmunológico.
Figura 3. Efecto del aumento de las proporciones de aminoácidos sobre la retención de N de cerdos en crecimiento en condiciones sanitarias buenas o malas durante 28 días.
En conclusión, los cerdos en crecimiento criados bajo desafío inmunológico tienen una menor ingesta de alimento, rendimiento de crecimiento y eficiencia de nitrógeno.
Sin embargo, estos problemas en el rendimiento del crecimiento y el estado inmunológico pueden mitigarse en parte mediante el aumento de las proporciones dietéticas de Trp, Thr y Met + Cys a Lys en un 120% de las recomendaciones de NRC (2012).
Referencias disponibles en la versión web del artículo en nutriNews.com
El ajuste de la proporción ideal de aminoácidos y lisina mejora el estado inmunológico y el rendimiento de los cerdos en crecimiento ante problemas de salud DESCÁRGALO























EGerente técnico de porcino para el sur de Europa en Novus International
l destete va generalmente acompañado de una reducción en la ingestión de alimento, además de cambios en la morfología del intestino y de su ecosistema microbiano.
Este período es un momento decisivo para los lechones; los que no pueden superarlo satisfactoriamente, a menudo sufren procesos diarreicos, mueren, son sacrificados, o no alcanzan el peso comercial.





Este desafío se debe, en gran parte, a la incapacidad del lechón para digerir y absorber los nutrientes de su nueva fuente de alimento sólido. La inmadurez de su sistema inmunológico durante esta parte de su vida tampoco ayuda.
Desde un punto de vista práctico, el período de post-destete está relacionado con una reducción en los rendimientos productivos y económicos.
Por tanto, es esencial limitar la gravedad de los problemas relacionados con el destete, con el fin de mejorar la capacidad de supervivencia, el bienestar y el crecimiento del lechón más allá de este período productivo.
Los ácidos orgánicos son uno de los ingredientes más utilizados en nutrición porcina.
Gracias a sus propiedades acidificantes, ayudan a controlar microorganismos patógenos, además de influir en la capacidad tampón del pienso, reduciendo eficazmente el pH gástrico y asegurando una digestión adecuada de la proteína de la dieta.
Estudios científicos muestran que los ácidos orgánicos con un pKa bajo, como los ácidos fórmico o fumárico, cubren estas necesidades en los lechones recién destetados.
Los ácidos con un pKa más alto, como el benzoico o el sórbico, liberan menos protones en ambientes de pH ácido como el estómago.
En un estudio in vitro realizado por Novus International, Inc. simulando las condiciones fisiológicas del tracto intestinal (a pH neutro), se observó que los ácidos benzoico y sórbico mostraron mayores efectos antibacterianos sobre E. coli y Salmonella en comparación con otros ácidos orgánicos (Figura 1).
E.COLI
Ab600 (% del control)
0,00% 0,50% 1,00% 1,50% 2,00%
Concentración de ácidos orgánicos
SALMONELLA
Ab600 (% del control)
0,50% 1,00% 1,50% 2,00%
Concentración de ácidos orgánicos
Ácidos sórbico y benzoico
Ácido fórmico
Ácido butírico
Ácido fumárico
Ácido cítrico Ácido málico Ácido láctico
Figura 1. Inhibición del crecimiento de E. coli y Salmonella por diferentes ácidos orgánicos en un modelo in vitro a pH neutro
Estos resultados pueden atribuirse en parte al grado de disociación de los distintos ácidos en estas condiciones: el ácido benzoico aporta más moléculas de ácido no disociadas en un ambiente con pH neutro que, por ejemplo, el ácido fórmico o fumárico.
Solo la molécula de ácido no disociada puede penetrar la membrana bacteriana, liberando su protón en el citoplasma y contribuyendo a una disminución del pH interno.
Las bacterias patógenas deberán bombear los protones al exterior de la célula para mantener la homeostasis interna. Los procesos enzimáticos se detendrán o se ralentizarán, lo que provocará una alteración del metabolismo de las bacterias o la muerte.
Bacterias beneficiosas para el huésped como las de las familias Lactobacillaceae, Ruminococcaceae y Lachnospiraceae, descomponen azúcares simples y polisacáridos complejos de la dieta, produciendo ácidos de distintos tipos, (láctico o ácidos grasos de cadena corta, AGCC)
por lo que una reducción del pH en su citoplasma no les supone el más mínimo desafío.
Por tanto, si se liberan adecuadamente, ciertos ácidos orgánicos como el benzoico podrán crear una modulación más efectiva en las partes posteriores del intestino del lechón. En su forma libre, el ácido benzoico se absorbe y metaboliza mayoritariamente en el estómago, y en menor medida, en regiones muy proximales del tracto gastrointestinal.
Ciertos procesos tecnológicos, como la protección de principios activos en una matriz lipídica, pueden modificar el sitio de acción de los ácidos orgánicos y mejorar su actividad en partes más distales del intestino.
Protegiendo el ácido benzoico en una matriz lipídica, se producirá una liberación progresiva del mismo a lo largo del tracto intestinal, lo que le facilitará su acción sobre un mayor número de poblaciones bacterianas.
Una fuente única y protegida de ácido benzoico
PROVENIA® Feed Solution de Novus es una fuente de ácido benzoico protegida que ofrece un exclusivo modo de acción.
La tecnología de protección desarrollada desde hace décadas en la fábrica de Gudensberg (Alemania), incorpora el ácido benzoico de manera homogénea en una matriz de grasa vegetal, generándose un producto granulado y uniforme que garantiza la protección del ingrediente activo en el pienso y en el estómago del animal.

A partir del duodeno, tras la acción de las lipasas sobre la matriz lipídica, el ácido benzoico se libera progresivamente en el intestino del lechón.
Otras ventajas que aporta esta tecnología de protección son:

Mayor estabilidad y menor interacción con otros componentes del pienso (p. ej., colina) o agentes ambientales (luz, calor, oxidación, humedad, etc.).
Reducción del olor y mejor palatabilidad.

del lechón pensando en su productividad futura
Reducción de la formación de partículas de polvo.
Al contrario del ácido benzoico libre, este producto no es corrosivo ni irritante, lo que mejora la seguridad de los trabajadores de las fábricas de piensos.
Permite una menor tasa de inclusión en el pienso.
En un estudio realizado en la Universidad de Belgrado (Serbia), lechones alimentados con PROVENIA® Feed Solution mostraron una mejora del 5% en la eficiencia alimentaria en comparación a un control negativo.
El aumento de la relación vellosidades-criptas en todos los tramos del intestino delgado y la mayor relación lactobacilos- E. coli en yeyuno, íleon y ciego demostraron una mayor integridad intestinal en los lechones que recibieron PROVENIA® Feed Solution (Figura 2).
Yeyuno Íleon
Duodeno
Yeyuno Íleon Ciego
2. Relacione de vellosidades/criptas y Lactobacilos-E. coli en lechones suplementados con PROVENIA® Feed Solution
Estos resultados son consistentes con los observados en un estudio realizado en colaboración con la Universidad Complutense de Madrid y la Universidad de Bolonia (Italia), donde se estudiaron, mediante técnicas de metagenómica, los efectos de PROVENIA® Feed Solution sobre el perfil microbiano de heces de lechones en comparación con dosis farmacológicas de ZnO.

PROVENIA® Feed Solution mejoró la diversidad alfa (parámetro asociado con una microbiota más equilibrada, sana y madura), y aumentó ciertos géneros bacterianos como Ruminococcus, Prevotella y Fibrobacter, involucrados en la fermentación de polisacáridos dietéticos, produciendo AGCC, los cuales representan una fuente directa de energía (comparable a la glucosa y la lactosa) y ayudan a mantener la homeostasis de la mucosa intestinal.
La etapa post-destete puede contribuir a problemas gastrointestinales y de crecimiento en el lechón que pueden ocasionar pérdidas económicas significativas.
A diferencia del ácido benzoico libre, el ácido benzoico protegido no se degrada o se absorbe en el estómago.
Modulación de la microbiota intestinal en lechones
DESCÁRGALO EN PDF
Además, los AGCC contribuyen a una reducción de la inflamación intestinal al inhibir la liberación de algunas citoquinas, disminuyendo la permeabilidad intestinal y el consiguiente riesgo de translocación bacteriana.
Finalmente, el efecto positivo sobre la integridad de la mucosa intestinal favorece la capacidad de absorción del intestino, con efectos positivos sobre la eficiencia de utilización del pienso.
La matriz lipídica que protege el ácido benzoico en PROVENIA® Feed Solution ofrece una liberación gradual del benzoico en todos los tramos del tracto intestinal.
Diversos estudios indican que este producto ayuda a aumentar la eficiencia alimentaria de los lechones, promoviendo una modulación adecuada de la microbiota intestinal y una menor incidencia de diarrea, lo que resulta en una mayor rentabilidad y sostenibilidad de la industria porcina.


PROVENIA® Feed Solution fomenta el crecimiento de la microbiota intestinal beneficiosa. Los ingredientes activos de PROVENIA® están protegidos para una liberación controlada en el tracto gastrointestinal, proporcionando un impacto positivo en la salud del lechón, respaldando el crecimiento, el rendimiento y el retorno económico de la granja. novusint.com.

® y PROVENIA® son marcas comerciales de Novus International, Inc., y están registradas en los Estados Unidos y en otros países.
TM Made of More es una marca de Novus International, Inc.
©2024 Novus International, Inc. Todos los derechos reservados

Olivier Merdy 1 y Laia Batet 2
1 Global Program Manager Swine Phyleo by Lesaffre
2 Técnico Comercial Porcino España y Portugal Phileo by Lesaffre
Con el fin de satisfacer la demanda mundial de carne de cerdo frente a los actuales requisitos económicos, regulatorios y de sostenibilidad, la industria porcina necesita aumentar constantemente su productividad.
Para maximizar el rendimiento, manteniendo los estándares de bienestar y salud animal, las empresas de producción porcina deben adoptar soluciones avanzadas de gestión sanitaria y nutricional.

La modulación de la microbiota con la levadura probiótica Sc47 puede ser un factor clave de éxito dentro de la nutrición de precisión, ya que permite obtener mayor número de lechones por camada y mayor peso de las camadas al destete.

¿Por qué suplementar las dietas de las cerdas con probióticos de levadura?
Se ha demostrado que suplementar las dietas con probióticos de levadura aumenta el rendimiento de los cerdos al mejorar la composición de la microbiota intestinal. El probiótico de levadura coloniza el intestino y modula las poblaciones bacterianas dentro de él.
La suplementación de las cerdas desde el último mes de gestación hasta la lactancia se traduce en diversos beneficios para la nutrición y la salud de las cerdas, contribuyendo a una mejora en el crecimiento y la salud de los lechones.

Desde el punto de vista nutricional, este efecto de modulación promueve la abundancia de bacterias capaces de digerir la fibra , dando lugar a una mayor producción de ácidos grasos de cadena corta (AGCC) en el intestino posterior.

La suplementación con levadura probiótica Sc47 puede aumentar la producción de AGCC hasta en un 28% de los ingredientes comunes de los piensos utilizados en las dietas de las cerdas (Nakatani, M. et al., 2018).
Estos AGCC proporcionan más energía disponible para soportar la alta demanda energética de la gestación, el parto y la lactancia.

Además, los AGCC contribuyen a mejorar la salud y el funcionamiento intestinal de la cerda, lo que favorece una mejor absorción de nutrientes del alimento.
De hecho, varios estudios mostraron una mejor digestión de la fracción de proteína bruta, lo que ayuda a aumentar la disponibilidad de nutrientes.
Apoyar el desarrollo de la glándula mamaria durante el final de la gestación puede conducir a un aumento de la producción de leche y a una mejora del crecimiento y la salud de los lechones después del destete. En el último mes de gestación, el crecimiento fetal se acelera rápidamente. Una nutrición adecuada es esencial para maximizar el peso al nacimiento de los lechones, factor clave para la supervivencia y el éxito del destete.
Si la energía y los nutrientes de la dieta son insuficientes, las cerdas, especialmente las primíparas, pueden priorizar el crecimiento fetal utilizando sus propias reservas corporales.
Además, mantener una condición corporal saludable también es crucial para el desarrollo de la glándula mamaria, especialmente en las primerizas.

Con frecuencia, las cerdas carecen de suficientes reservas energéticas para satisfacer las demandas para la construcción del nido, las contracciones uterinas y la producción de calostro, lo que puede prolongar el proceso de parto.
Estimular la mayor transferencia materna posible de inmunoglobulinas a los lechones es importante para su supervivencia , ya que los recién nacidos inicialmente no pueden producir su propia inmunidad con la suficiente rapidez y dependen temporalmente de los anticuerpos de la madre.
Proporcionar energía adicional puede ayudar a disminuir la duración del parto y reducir el riesgo de mortinatos.
La energía y los nutrientes necesarios para la producción de calostro y leche a menudo superan lo que las cerdas son capaces de obtener a través de su dieta.
La lactancia de camadas grandes requiere una movilización significativa de las reservas corporales, lo que conduce a un estado catabólico en las cerdas.
Este estado catabólico es más pronunciado en las cerdas jóvenes, especialmente en las primíparas, debido a una menor ingesta de alimento y reservas corporales en comparación con las cerdas multíparas.
El suministro de energía adicional a través de la dieta puede contribuir a aumentar la producción de energía destinada a la producción de calostro y leche, reduciendo así la pérdida de peso corporal. En este sentido, varios estudios han reportado la mejora de la calidad nutricional del calostro y la leche con un mayor contenido en proteínas, grasas o lactosa.
Se ha demostrado que la suplementación con el probiótico de levadura Sc47 tiene un efecto inmunomodulador, aumentando la concentración de inmunoglobulinas (IgG e IgA) en las secreciones de las cerdas.
Es importante destacar que el contenido de inmunoglobulinas depende de la dosis administrada y del momento:
se puede contener más IgG en el calostro y transferirla a los lechones cuando comienza la suplementación durante la gestación.
Esta mejora de la calidad inmunitaria del calostro puede mejorar la inmunidad pasiva de los lechones. El aumento de la concentración de IgA en el calostro y en la leche contribuye a establecer una barrera de defensa de la mucosa frente a los patógenos.
Todas estas mejoras en la transferencia de inmunidad ayudan a proteger a los lechones de posibles enfermedades.


El desarrollo de la microbiota intestinal durante la etapa neonatal desempeña un papel importante en la funcionalidad del sistema inmunitario intestinal y en la absorción de nutrientes en los lechones, lo que garantiza su buen estado de salud. La microbiota de las cerdas desempeña un papel importante para los lechones en el parto, incluso antes de que se produzca la transferencia. El cambio de la dieta de gestación a la dieta de lactancia puede provocar disbiosis intestinal.
Desde el parto, el intestino de los lechones es rápidamente colonizado por bacterias con las que entran en contacto durante la fase neonatal. La microbiota vaginal y fecal de la cerda desempeña un papel importante en la colonización temprana del intestino del lechón.
Además, algunas bacterias presentes en la microbiota intestinal de la cerda pueden transferirse a la descendencia a través del calostro y la leche debido a su translocación del intestino a las glándulas mamarias.

El microbioma intestinal de la cerda es, por lo tanto, un determinante esencial para los lechones. Cualquier intervención sobre la microbiota de las cerdas puede afectar a la microbiota de los lechones.
Se ha demostrado que la suplementación con la levadura probiótica Sc47 en cerdas modula la microbiota del lechón hasta el destete.
Esta modulación favorece el desarrollo de una microbiota sana con más bacterias beneficiosas y menos cepas patógenas. Incluso, después del destete, aun puede producirse un efecto positivo a largo plazo en los lechones procedentes de cerdas suplementadas con probióticos de levadura.
La introducción de un pienso de transición para ayudar a la microbiota a adaptarse a una dieta con menos fibra y más energía a menudo no es factible debido al equipamiento técnico de las granjas.
Se cree que esta disbiosis intestinal favorece a la aparición de estreñimiento, una afección asociada con una mayor muerte fetal y una menor vitalidad de los lechones al nacer, lo que reduce su capacidad para succionar una buena cantidad de calostro.
El estreñimiento puede considerarse un factor de riesgo para la salud y el rendimiento de los lechones.
Además, presenta un alto riesgo de problemas de salud de las cerdas, como el síndrome de disgalactia posparto (SDP), que afecta la producción de calostro y leche, especialmente dentro de las 12 y 48 horas posteriores al parto, lo que lleva a la inanición de los lechones.
Las experiencias de campo han demostrado que la suplementación con probióticos de levadura puede ayudar a aliviar el estreñimiento en la sala de partos.
¿Cómo se traducen estos beneficios en el rendimiento reproductivo en la era de las razas
Recientemente, se llevó a cabo un meta-análisis, para comprobar la eficacia de la levadura probiótica Sc47 en relación con la mejora de los parámetros reproductivos de cerdas modernas bajo condiciones comerciales de campo. Se utilizaron siete estudios, realizados entre 2012 y 2023, para evaluar el rendimiento de más de 3.000 camadas destetadas de cerdas que recibieron la levadura probiótica Sc47 durante el último mes de gestación y lactancia.
La mayoría de los estudios se realizaron en razas hiperprolíficas. En concreto, se realizaron 3 estudios en España con cerdas que producían en promedio entre 19 y 22 lechones totales nacidos por camada en ausencia de suplementación.
España (SP1) Large White x Landrace (DanBred) 21,5 2022
España (SP3) Danbred x Pietrain 20,2 2022
España (SP2) DanBred x Duroc Topigs 19 2018
China (CN) Large white x Landrace 15,6 2023
Grecia (GR) Topigs genetics 14,3 2015
Italia (IT) No conocido 13 2012
Vietnam (VN) No conocido 11,3 2013
El enfoque nutricional de la suplementación con la levadura probiótica Sc47, destinada a modular la microbiota de las cerdas durante el último mes de gestación y lactancia, puede mejorar el rendimiento en la producción porcina moderna.
Suplementación nutricional de precisión con probióticos de levadura para mejorar la calidad de los lechones
DESCÁRGALO EN PDF
Sobre la base de modelos estadísticos, el metaanálisis mostró que la levadura probiótica Sc47 mejoró el número de lechones nacidos vivos por camada en 0,56 (p = 0,009). El número de lechones nacidos total fue superior en 0,20 (p = 0,56), lo que sugiere una mejora del rendimiento del parto en las cerdas suplementadas.
El metaanálisis mostró que la levadura probiótica Sc47: Mejoró el número de lechones destetados en 0,3 lechones.
Logró un extra de 230 g por lechón al destete.
Camadas 4,12 kg más pesadas al destete.
+ 0,30 lechones destetados/camada
Ciclo2 Ciclo1 Ciclo2 GR(28días)SP1(24días)SP1(28días)CN(21días)SP2(19días)SP3(21días)
el tamaño de la camada al destete.
Al reforzar el estado nutricional y la salud intestinal de las cerdas, mejorar la calidad del calostro y la leche, y promover la transferencia de una microbiota saludable a los lechones, la levadura probiótica Sc47 contribuye significativamente a mejorar el rendimiento de los lechones desde el nacimiento hasta el destete, obteniendo así lechones de calidad en el destete.

Controlando la microbiota y la transferencia de inmunidad, Phileo diseña soluciones y programas para que los lechones tengan un mejor comienzo a través del soporte nutricional de la cerda. Nuestros probióticos mejoran la viabilidad y salud intestinal de los lechones desde el nacimiento hasta el destete y también aumentan el tamaño y la homogeneidad de la camada.
Actúa con la naturaleza para el cuidado animal.
Para más información:
e-mail: info@phileo.lesaffre.com
Website: https://phileo-lesaffre.com/es/ Telf. Atención Cliente: 983 23 29 07
Phodé Animal Care

La calidad de la carne depende de varios criterios.
Uno de los factores más subestimados son las diversas situaciones de estrés a las que se enfrentan los animales durante el ciclo de producción y que repercuten, en última instancia, en la calidad de la carne.





El principal indicador para determinar la calidad de la carne de cerdo es el pH. De hecho, esta medida define la calidad y la vida útil de la carne, que son datos esenciales para el procesado.
El pH también está fuertemente correlacionado con otros parámetros tecnológicos como el color o la pérdida por goteo, pero también con criterios organolépticos como la terneza, la jugosidad o el sabor.
Hay dos categorías de carne que deben evitarse por su mala calidad:
Las carnes con un pH <5,6 denominadas carnes PSE: Pálidas, Blandas y Exudativas (de sus siglas en inglés, palid, soft and exudative). Muy ácidas y claras, tienen poca capacidad de retención de agua. Se rechazan para su transformación en productos elaborados como el jamón.
Carnes con un pH mucho más elevado > 5,8 también denominadas DFD: Oscuras, Firmes y Secas (de sus siglas en inglés, dark, firm and dry). Las carnes DFD tienen una vida útil corta.
Por ello, los mataderos y los fabricantes de alimentos prefieren las carnes con un pH entre 5,6 y 5,8, lo que garantiza una buena predisposición a una buena calidad de la carne.
Para comprender el impacto del estrés sobre el pH, hay que distinguir entre estrés a corto y largo plazo.

Estrés de corta duración
El estrés a corto plazo se refiere a los acontecimientos estresantes que se producen antes del sangrado. Cuando el animal percibe una situación estresante, el organismo entra en estado de alerta.
Es necesaria una rápida movilización de energía para garantizar la respuesta natural al estrés: luchar o huir.
El consumo de glucógeno como fuente de energía producirá una cantidad significativa de ácido láctico.
Si el sangrado se produce poco después del acontecimiento estresante, el ácido láctico no se eliminará, lo que dará lugar a una carne con un pH bajo (carne PSE).
Estrés de larga duración
Los cerdos también pueden estar expuestos a estrés a largo plazo, como la larga duración del transporte, las peleas en grupo en el matadero y los largos tiempos de espera antes del sacrificio.
Como los cerdos llegan en ayunas al matadero, el estrés prolongado agotará sus reservas de glucógeno. Por tanto, el proceso de acidificación post mortem será ineficaz y la carne permanecerá con un pH elevado, lo que dará lugar a carne DFD.

En general, todos estos elementos son bien conocidos y están controlados. Pero queda una variable no controlada: el propio animal. En efecto, el estrés es una respuesta individual que depende de un factor principal: la capacidad del animal para manejar el estrés.
Para garantizar que la carne tenga un pH óptimo, el nivel de glucógeno muscular debe ser lo suficientemente alto en el momento del sangrado y el estrés debe limitarse al mínimo antes y durante el sacrificio. En el matadero, es esencial gestionar la duración del transporte, los tiempos y las condiciones de espera (como el acceso al agua o la densidad, por ejemplo).
La gestión preventiva también existe a nivel de granja (densidad, acceso al camión, manejo cuidadoso). Una buena relación humano-animal también facilitará la manipulación en el matadero.
Como explica Addis Fikrie Birhanu en su reciente estudio realizado en 2020, los factores estresantes se integran directamente a nivel cerebral y los animales estresados tenderán a adaptarse mediante cambios fisiológicos y de comportamiento que repercutirán directamente en la calidad de la carne (Figura 1).
Así pues, gestionar la respuesta al estrés desde la raíz es clave para obtener mejores resultados.
Conociendo el mecanismo del estrés, Phodé ha desarrollado un enfoque innovador: VeO, una solución sensorial para mejorar el rendimiento dotando a los animales de la capacidad de adaptarse bien a situaciones de estrés.


Condiciones novedosas / estresantes
Manipulación, transporte, reagrupación
social, privación de alimentos y agua, cambios en el ambiente
Miedo

Activación del SNA y el HPA
Secreción de hormonas y metabolitos del estrés
Animal estresado
Emocional/físico
Reducción/ausencia de beneficios
Adaptado de Addis Fikrie Birhanu; 2020
Cambios fisiológicos
Aumento de la frecuencia respiratoria, ritmo cardíaco y la temperatura corporal
Cambios de comportamiento
Aumento del estado de alerta, agresividad, vocalización, evitación e inmovilización
Calidad de la carne
Aumento del pH, dureza, oscurecimiento del color, reducción de la vida útil, de la calidad organoléptica y de la aceptabilidad de los consumidores.
Figura 1. Efectos del estrés previos al sacrificio sobre los animales y la calidad de la carne (SNA-Sistema Nervioso Autónomo, HPA-Hipotálamo - Pituitaria - Adrenal).

En un estudio reciente realizado en Europa, cerdos de engorde recibieron durante 60 días una dieta que contenía la solución VeO para cubrir el estrés de la densidad y el estrés del transporte. Durante la fase de engorde, los animales estaban menos agitados y también más tranquilos durante la carga y el transporte.
Como resultado, la calidad de la carne mejoró significativamente, con una reducción del 41% de la carne PSE (Figura 2). Además, el porcentaje de carne en un rango óptimo de pH entre 5,6 y 6,2 aumentó significativamente en un 43%.
Figura 2. Mejora de la calidad de la carne con VeO en cerdos de engorde
En cualquier situación de estrés, como la densidad, el transporte o la manipulación, los animales pueden manifestar un comportamiento anormal (animales nerviosos, que se muerden la cola) o simplemente una disminución del rendimiento que no siempre se mide (disminución del consumo de pienso, menor GMD).
Sin embargo, las consecuencias son importantes en la calidad de la carne (menor rendimiento de la canal, mayor pérdida por goteo, pH más bajo, etc.) y ¡pueden costar mucho! Tener una solución adecuada para responder al estrés desde la raíz es clave.


Probado y comprobado en todo el mundo durante más de 20 años, VeO ha demostrado sus beneficios para toda la producción porcina, y la gestión de la respuesta a situaciones de estrés es clave para mejorar el rendimiento de la producción.
Para saber más, visite nuestro nuevo sitio web:






Reducir las lesiones cutáneas

Promover un comportamiento tranquilo durante el transporte

Mejor calidad de la carne




Dr. Luis Tavares Director de Nutrición de Racentro (Portugal)

En las últimas décadas, los programas de mejora genética han sido uno de los principales pilares para el aumento de la productividad y, en consecuencia, para la sostenibilidad de la avicultura. Los pollos actuales y su descendencia son el resultado de programas de selección que se ajustan constantemente a la demanda del mercado.

En términos generales, las aves con las que trabajamos a lo largo del tiempo presentan variaciones significativas en términos de rendimiento, rusticidad y productividad. Es decir, tratamos con animales cuyas características cambian cada cierto tiempo.
En este contexto, las principales empresas de genética publican periódicamente recomendaciones nutricionales para ayudar a los productores a formular raciones que estén a la altura del nuevo potencial genético de las aves.

El crecimiento y la uniformidad de las manadas de reproductoras dependen principalmente de la gestión de la alimentación a lo largo del ciclo de producción.
Por ello, es posible alcanzar el rendimiento deseado con diferentes formulaciones nutricionales.
Este artículo explora la evolución de las recomendaciones nutricionales para reproductoras pesadas en los últimos años.
El objetivo principal en esta etapa es el desarrollo musculoesquelético óptimo para alcanzar los pesos estándar. Dado que la ingesta a esta edad temprana es todavía limitada, se necesitan dietas de alta densidad nutritiva para garantizar pesos estándar durante las primeras cuatro semanas.
Al analizar la dieta de cría, especialmente en las primeras cuatro a seis semanas de vida, podemos observar que, en relación con la energía metabolizable, no existen grandes diferencias en las recomendaciones de las principales empresas de genética de todo el mundo.
Por ejemplo, observando las recomendaciones nutricionales para las pollitas de cría Ross 308 desde 2007 hasta 2021, el valor de referencia para la energía en la dieta de la primera fase se mantuvo en 2800 kcal/kg.

Es importante destacar que es posible alimentar a las pollitas con distintos niveles de energía . En la práctica, los niveles de energía pueden variar entre 2750 y 2950 kcal de energía metabolizable por kg de pienso, lo que significa que es necesario ajustar las cantidades diarias de pienso para ajustar el consumo de energía.

En cuanto al perfil proteico, en los últimos años se ha producido un aumento general de los niveles de aminoácidos. Una mayor concentración de aminoácidos en las primeras semanas de vida ha permitido un mejor desarrollo inicial de las pollitas antes de que comience la restricción alimentaria.
Tomando como ejemplo algunos aminoácidos y comparando las recomendaciones de Aviagen desde 2007 hasta la actualidad, podemos ver que la lisina digestible ha aumentado un 5,26%, pasando del 0,95% al 1%.
La metionina + cisteína aumentó un 13%, del 0,74% al 0,84%, la treonina un 9%, del 0,66% al 0,70%, y la arginina un 11%, del 1,03% al 1,15%.
Cobb siguió la misma tendencia a edades tempranas, aunque los aumentos fueron más modestos
Aunque la genética es diferente, es posible observar un aumento de la densidad proteica en las dietas de las primeras semanas de vida. El desarrollo óptimo de los sistemas muscular, esquelético, gastrointestinal, del plumaje e inmunitario ha sido la principal razón de este aumento de la densidad proteica.
En cuanto al componente mineral, las recomendaciones de Aviagen han mantenido los niveles de calcio y fósforo disponibles desde 2007 hasta 2021, fijados en el 1% y el 0,45% respectivamente. Sólo en 2021 aumentaron las necesidades de calcio al 1,05% y las de fósforo al 0,5%.
La razón principal de este aumento fue la necesidad de favorecer un desarrollo óseo óptimo, especialmente en los machitos.

En el caso del Cobb 500, desde 2008 hasta la actualidad se ha producido una ligera reducción de los niveles de calcio, del 1% al 0,95%, mientras que el fósforo disponible se ha mantenido prácticamente invariable en el 0,45% en las primeras semanas de vida para una dieta de 2.850 kcal/kg.





Optimiza la utilización de nutrientes.
Compatible y sinérgico con programas anticoccidiales.
Sin interacción con antibióticos y aditivos.


En cuanto a los requerimientos de microminerales, destaca un aumento de los niveles de yodo y manganeso, así como una reducción de los niveles de zinc, que pasa de 100 ppm a 90 ppm en las últimas recomendaciones 2021 de Aviagen.
Esta reducción está en línea con la legislación europea, cuyo límite máximo para todas las fuentes de zinc es de 120 mg/kg.
En las recomendaciones globales de Aviagen, el zinc ha pasado de 100 a 120 ppm. Por otro lado, las recomendaciones de Cobb han sido más estables en cuanto a los requerimientos de estos nutrientes y se han mantenido sin cambios desde 2013.
En relación a las vitaminas, hay una tendencia similar entre las recomendaciones de Ross y Cobb para la vitamina D.
Mientras que Ross aumentó los niveles para las primeras semanas de vida de 3500 a 4000 UI/kg entre 2016 y 2021, Cobb aumentó de 3000 a 3500 UI/kg de 2013 a 2019.
Según la normativa europea, el valor establecido en las recomendaciones de la UE se fijó en 3200 UI/kg.
En cuanto a la vitamina E, ambas genéticas siguieron la tendencia al alza de la última década, con un aumento de 60 a 100 mg/kg.
Además, todas las demás vitaminas incluidas en las recomendaciones de Aviagen han aumentado.
A partir de 2021, las recomendaciones, que antes estaban divididas entre la fase de iniciación y la de crecimiento, se consolidan ahora en una única recomendación que cubre las necesidades del periodo comprendido entre el día 0 y el 5% de producción.
Por otro lado, Cobb ha mantenido separadas las recomendaciones de minerales y vitaminas para los periodos de arranque y de crecimiento
Analizamos ahora las recomendaciones para el periodo de crecimiento entre las 6 y las 15 semanas, caracterizado por una alimentación de menor densidad, con el objetivo de controlar los pesos y mantener las manadas lo más uniformes posible hasta llegar al periodo de puesta.
En los últimos 20 años, las recomendaciones de energía metabolizable en los piensos utilizados durante este periodo se han mantenido estables en 2600 kcal/kg.

Sin embargo, la misma estabilidad no se aplica a las necesidades de aminoácidos. Tomando como ejemplo las recomendaciones de Aviagen de los últimos años, se ha producido una reducción de las necesidades de lisina digestible de alrededor del 17%, pasando del 0,58% en 2007 al 0,48% en 2021.

TERMOESTABLE
HASTA LOS 198 OC
ALTAMENTE HIDROSOLUBLE
ESTABLE EN UN RANGO AMPLIO DE PH
NO SE METABOLIZA EN EL ORGANISMO
NO FERMENTA
Aporta un dulzor de mayor intensidad, más estimulante, homogéneo y persistente.
Desencadena un efecto hedónico que aumenta la ingesta de alimento, estimula las secreciones digestivas, favorece la absorción de nutrientes y mejora los índices zootécnicos.
Producto estandarizado mediante rigurosos controles en todos los lotes.
Autorizado en la Unión Europea sin límites legales de dosificación, especies animales ni edades, según la EFSA.
Disponible tanto en versión líquida como sólida.
Edulcorante natural para piensos a base de glicósidos de esteviol, extraídos de la planta stevia rebaudiana APSABOR REPRESENTA UNA SOLUCIÓN EFECTIVA Y NATURAL PARA MEJORAR LA
Esta reducción se justifica por la necesidad de controlar mejor el crecimiento muscular de las aves, evitando el desarrollo excesivo de la pechuga y favoreciendo las reservas de grasa y la uniformidad.
En contraste con la reducción de la lisina, se ha producido un aumento de los niveles de los demás aminoácidos esenciales.
La metionina, por ejemplo, pasó del 0,28% al 0,33%, la metionina+cisteína del 0,50% al 0,58%, la treonina del 0,42% al 0,48%, la valina del 0,49% al 0,56%, y la arginina aumentó un 12%.
Los estudios realizados en los últimos años sobre la importancia de los distintos aminoácidos esenciales han contribuido a estos aumentos con cada nueva publicación de recomendaciones
El aumento de los niveles de los demás aminoácidos, como la metionina, la treonina, la valina y la arginina, coincide con investigaciones recientes.

Estos aminoácidos han demostrado beneficios en términos de mejora de la resistencia (relacionados con la metionina y la cisteína), o crecimiento equilibrado y salud inmunitaria (relacionados con la arginina y la treonina).

Estudios recientes indican que un equilibrio más fino entre estos aminoácidos puede traducirse en un mejor rendimiento reproductivo y una mayor resistencia a las enfermedades, especialmente al optimizar el metabolismo de las proteínas y el desarrollo estructural de las aves.
En cuanto al componente mineral y teniendo en cuenta las recomendaciones de Ross 308, las necesidades de calcio se mantuvieron estables en el 0,9%, mientras que el fósforo disponible aumentó gradualmente del 0,42% al 0,45%. En 2007, la relación Ca/P se situaba en torno a 2,57, y ahora es de 2,00. Este ajuste se basó en la mejora del sistema esquelético.
En cuanto a las necesidades de microminerales y vitaminas, la evolución de los cambios es similar a la observada en la dieta de inicio.
Se administra con el objetivo de preparar a la futura reproductora para una producción de huevos fértiles elevada y persistente en el tiempo.
Debido a la necesidad de depositar reservas de grasa, la energía metabolizable es siempre superior a las referencias de crecimiento. Entre 2007 y 2013, las recomendaciones de Aviagen eran de 2800 kcal/kg. Sin embargo, desde 2016, ha habido una reducción de 100 kcal, que continúa hasta hoy.

En cuanto a la evolución de las necesidades de aminoácidos, en las dos últimas décadas se ha producido una reducción del nivel de lisina digestible.

Tomando como ejemplo las recomendaciones de Aviagen, se ha producido una disminución del 19%, pasando del 0,58% al 0,47%.
Esta disminución puede haber sido dictada por la necesidad de un mayor control sobre el peso y la condición corporal, permitiendo un equilibrio entre las reservas de grasa y el peso corporal sin comprometer el rendimiento productivo.
Dado que las aves son muy reactivas a la concentración de lisina en la dieta, esta reducción se basó en la necesidad de un mayor control sobre el desarrollo de la masa corporal, favoreciendo la deposición de las reservas de grasa y evitando un consumo excesivo de lisina.
El mayor contenido de energía metabolizable permitirá una transición energética más suave hacia la fase de producción, promoviendo pequeños incrementos semanales en la cantidad de pienso, una ganancia de peso adecuada, la correcta conformación de la pechuga y la deposición de reservas de grasa.
Todos los demás aminoácidos registraron aumentos, como la metionina + cisteína (17%), la treonina (14%), la valina y la arginina (12%).
La metionina, la cisteína y la arginina son esenciales para el desarrollo de las plumas.
El componente mineral de la dieta de pre-postura, que se caracteriza por tener unos niveles de calcio más elevados que la dieta de crecimiento para potenciar las reservas óseas, no ha variado en los últimos años en los programas de 4 fases, manteniéndose en el 1,20%.
En 2021, se produjo un aumento del fósforo disponible de 0,35 a 0,45%, lo que condujo a una reducción de la relación Ca/P de 3,42 a 2,66.





Tras alcanzar la madurez sexual e iniciar el ciclo de puesta, las aves tienen elevadas demandas energéticas, proteicas y minerales, lo que requiere el uso de dietas específicas para la reproducción.
Considerando uno de los principales indicadores de rendimiento, el número total de huevos por ave alojada, se ha producido un aumento significativo a lo largo de los años.
En 2008, una reproductora Ross 308 producía una media de 180 huevos al final de 40 semanas de producción. Casi dos décadas después, ese objetivo se ha elevado a 187,5 huevos. Del mismo modo, la estirpe Cobb 500 mostró un aumento en la producción de huevos, de 178,7 a 181,3 huevos a las 65 semanas.
Este aumento de la productividad es el resultado del constante proceso de mejora genética, que requiere ajustes en las fórmulas nutricionales para satisfacer los nuevos requisitos fisiológicos de las aves.
Uno de los primeros puntos a destacar en las publicaciones de recomendaciones nutricionales es el aumento del número de referencias alimentarias a lo largo de las 40 semanas de producción.
En las recomendaciones de Aviagen de 2007, sólo había una ración de puesta, mientras que en 2021 los programas ya incluyen tres referencias alimentarias para esta fase. Cobb, por su parte, mantiene desde 2008 la recomendación de utilizar dos referencias de pienso, ajustadas en función de la edad de las aves.
A la hora de analizar la evolución nutricional de las dietas de producción, partimos de los requerimientos energéticos.
Los niveles energéticos de las dietas de puesta no han variado; Ross 308 ha mantenido 2800 kcal/kg como valor de referencia desde 2007.
Sin embargo, la energía requerida durante el pico de producción ha aumentado ligeramente, pasando de 462 a 468 kcal/ave/día.
En cuanto al componente proteico, podemos destacar una evolución importante en términos de necesidades de aminoácidos.
Si nos fijamos en las necesidades de lisina, en el caso de Ross, se pasó de 950 mg/día a 1036 mg/día por ave en el pico de producción.
En cuanto a los demás aminoácidos, tanto los azufrados como los ramificados han experimentado aumentos desde 2007. La metionina ha aumentado alrededor de un 35% (del 0,28% al 0,38%), la metionina+cisteína un

La dieta del pico de producción de 2007 pasó de 0,58% a 0,62% de lisina digestible en 2021, un aumento del 6,8%
Este aumento se destinó probablemente a apoyar el peso del huevo en el primer periodo de producción. Tras el pico de producción, las necesidades de este aminoácido se han mantenido prácticamente sin cambios, en el 0,56% desde 2013.
La alta eficiencia de estas aves en relación a la lisina digestible hace que no deban superar este nivel para mantener un peso corporal razonable para una producción óptima de huevos. Para ello, y con el fin de controlar mejor los pesos después del pico de postura, la referencia de puesta 2, que se recomendaba administrar a los 245 días, se ha adelantado a los 225 días en las recomendaciones de 2021.
Estos aumentos permiten mantener una producción y una persistencia óptimas, la calidad de los huevos y la tasa de eclosión o el correcto emplume.
La necesidad de garantizar un emplume adecuado es en gran medida responsable del éxito de la cubrición y de la viabilidad de las reproductoras hasta el final del ciclo.
El Cobb 500 para las referencias de pico de puesta de 2008 a 2020 también mostró un aumento de las necesidades de lisina, aunque menor que el de Aviagen, en torno al 2,48%, pasando del 0,64 al 0,66% considerando una dieta de 2800 kcal/kg.
La reactividad superior de esta estirpe a la lisina digestible puede haber conducido a un aumento más gradual de este aminoácido a lo largo de los años.
En cuanto al resto de aminoácidos y analizando su equilibrio ideal con la lisina digestible seguida por Cobb, desde 2008 podemos ver que no todos los aminoácidos han seguido la misma tendencia al alza que Ross 308.
Los aumentos más significativos fueron los de la metionina, que pasó del 47% al 52%, y la arginina, que subió del 90% al 110%. La isoleucina y la valina descendieron del 80% al 75% y del 76% al 70%, respectivamente.
Según algunas referencias bibliográficas, como Ekmay et al. 2013, el aumento de los niveles de lisina e isoleucina tiene un impacto negativo en la fertilidad.
En cuanto a los requerimientos de ácido linoleico, las recomendaciones de Aviagen reflejan un incremento del 60% desde 2007 hasta la actualidad, situándose actualmente en el 2%.
El objetivo de mejorar el tamaño de los huevos y, en consecuencia, el de los pollitos puede haber justificado este cambio.
Por su parte, la Cobb 500 ha mantenido prácticamente sin cambios sus requerimientos de ácido linoleico en los últimos años, en el 1,25 por ciento tanto en la fase de pico de puesta como en la de pospico.
Los niveles de colina también han aumentado en los últimos años en Cobb y Ross.
Mientras que en 2008 Cobb tenía un nivel mínimo de 250 mg/kg de colina suplementada, en 2019 esta cifra se duplicó hasta los 500 mg/kg.
Del mismo modo, Aviagen pasa de una recomendación de 1000 mg/kg de colina total a 1600 mg/kg.
En cuanto al calcio, las recomendaciones de Aviagen muestran una estabilidad en los niveles de calcio en las dietas pico y post pico, 3% y 3,2% respectivamente.
Si observamos el fósforo disponible, se observa un aumento muy gradual desde 2013. Por ejemplo, la referencia de pico pasó de 0,35% a 0,36%, lo que llevó a una reducción de la relación Ca/Pdisp de 8,57 a 8,33.
Si nos fijamos en las recomendaciones de puesta máxima para reproductoras Cobb 500, de 2008 a 2020 la relación Ca/Pdisp mostró la tendencia opuesta, con un aumento de 6,68 a 7,14.
Se produjo un aumento del nivel de calcio de 2,93 a 3% y del fósforo disponible de 0,439 a 0,42% (suponiendo una dieta con una densidad energética de 2800 kcal/kg).
En cuanto a los microminerales, los requisitos de cobre, yodo, manganeso y zinc han aumentado de 2016 a 2021 en Ross 308.
Este aumento permite un mejor apoyo del metabolismo así como una mejora del emplume.
Por otro lado, los niveles de Cobb 500 no cambiaron de 2008 a 2022, permaneciendo prácticamente sin cambios desde entonces.


Los niveles de vitaminas también han cambiado, sobre todo en Ross 308. Los requisitos para esta estirpe se mantuvieron sin cambios entre 2007 y 2021, pero en la última publicación se eliminaron las recomendaciones separadas para piensos a base de maíz o trigo.
Además, se produjo un aumento de todas las vitaminas. Es decir, la vitamina E pasó de 100 a 130 mg, el ácido fólico de 2 a 5 mg, la vitamina k de 5 a 9 mg.
Sólo hubo una reducción de las vitaminas
A y D, pero se debió a los límites impuestos por la normativa europea.
La vitamina A pasó de 11.000 a 10.000 UI/ kg y la vitamina D de 3.500 a 3.200 UI/kg.

Según las recomendaciones mundiales, la vitamina A se sitúa actualmente en 15.000 y la vitamina E en 5.000. Este aumento se debe en parte al apoyo al desarrollo embrionario, la incubabilidad y la calidad de los pollitos.
En Cobb, desde 2008 hasta las últimas recomendaciones de 2019, los cambios no han sido tan marcados y, además, han mantenido niveles diferenciados de vitaminas para las dietas basadas en trigo y maíz.
Los valores de vitamina E aumentaron de 3000 a 3500 UI/kg. En cambio, los valores de ácido fólico descendieron de 4 a 3 mg/kg.

El análisis de la evolución de las recomendaciones nutricionales para las reproductoras pesadas revela un claro avance en las necesidades de las aves a lo largo de los años, lo que refleja el impacto de los programas de mejora genética.
Los cambios en las fórmulas nutricionales, que incluyen ajustes en los niveles de energía, proteínas, aminoácidos y minerales, tienen como objetivo maximizar la productividad, la salud y el bienestar de las aves.
Análisis de la evolución de las recomendaciones nutricionales para reproductoras pesadas DESCÁRGALO EN PDF
INTRODUCCIÓN
Elena Moreno (elena.moreno@basf.com) En representación del equipo técnico de enzimas de BASF Nutrición Animal
Los productores de pienso se han enfrentado a grandes desafíos en los últimos años debido al aumento de los precios de las materias primas y su variabilidad debido a interrupciones y escasez en la cadena de suministro.
Como resultado, el coste de producción ha aumentado significativamente. Para reducir los costes de alimentación, los nutricionistas intentan maximizar el uso de los alimentos.
Natupulse® TS representa un paso adelante en este sentido. La última innovación enzimática de BASF, una β-mananasa que fue recientemente aprobada por EFSA para el engorde de aves, puede mejorar la digestión y así ayudar a los animales a obtener el máximo de nutrientes del pienso.
Muchos productores se enfrentan a dificultades para mejorar la eficiencia alimenticia en dietas a base de maíz-soja, ya que el valor nutritivo de dicha dieta es considerablemente alto.
Sin embargo, hay margen de mejora en las dietas de maíz-soja para pollos de engorde, ya que hasta el 30% de los nutrientes permanecen sin digerir. Una de las razones es la presencia de polisacáridos no amiláceos (PNA), que se sabe que son factores antinutritivos (FANs) que pueden disminuir la utilización de nutrientes y afectar el rendimiento de los animales.
En la harina de soja, uno de los principales PNA es el β-manano galactomanano. La adición de β-mananasa al alimento hidroliza los β-mananos dietéticos y puede reducir sus efectos antinutritivos. Se describe en la literatura que el nivel de β-manano varía significativamente en la harina de soja. Como los β-mananos no se consideran entre los parámetros para juzgar la calidad de la soja, los niveles variables pueden representar un riesgo significativo para el rendimiento en pollos de engorde.
Enriquecer el pienso con β-mananasa puede ser una solución para reducir los costos de producción, mejorando la eficiencia alimenticia. Por lo tanto, la β-mananasa puede ayudar a mejorar la rentabilidad de la producción de proteínas animales.
Sin embargo, no todas las mananasas son iguales. Para ser efectiva en el animal, es importante asegurarse de que la mananasa mantenga su actividad incluso bajo entornos desafiantes durante el almacenado y procesado del pienso.
Al decidir sobre una β-mananasa, también se debe considerar el perfil de pH. Natupulse® TS está óptimamente adaptado al perfil de pH del tracto gastrointestinal (Figura 1). De esta manera, puede estar activo desde el comienzo del tracto gastrointestinal y así descomponer los β-mananos lo más rápido posible
OBJETIVO
Dado que las enzimas son proteínas que se degradan en el intestino delgado, también es esencial que la mananasa tenga suficiente tiempo para interactuar con el sustrato y reducir los efectos antinutritivos, y no solo al comienzo del intestino delgado.
PERFIL DE PH DE LA MANANASA, ACTIVIDAD RELATIVA (%)*
Competidor Naturpulse TS
Figura 1. Natupulse® TS se adapta de forma óptima al perfil de pH del TGI
Asegurar que la enzima tenga suficiente tiempo para trabajar en el sustrato muestra la importancia de otro parámetro crucial para la eficiencia de una β-mananasa: la estabilidad gástrica. Esto indica la actividad de la enzima en las condiciones ácidas del estómago. La Figura 2 muestra que la actividad de Natupulse® TS se mantiene estable con el tiempo, lo que permite una hidrólisis óptima de los mananos.
* En condiciones del ensayo de la enzima Temperatura de reacción: 37 °C
ESTABILIDAD GÁSTRICA
Tiempo (min) Competidor
Naturpulse TS
Las muestras fueron cogidas en los momentos designados y se realizó el ensayo de actividad
Figura 2. Natupulse® TS muestra alta estabilidad gástrica.
La alta eficiencia de Natupulse® TS se demostró en un estudio reciente realizado por BASF y el Instituto de Investigación y Tecnología Agroalimentaria (IRTA) en España, que investigó sus efectos en la digestibilidad de nutrientes y el rendimiento de los pollos de engorde.
TRATAMIENTO
RESULTADOS
En este estudio, los broilers machos Ross-308 fueron alimentados con una dieta a base de maíz-soja sin y con β-mananasa (800TMU/kg de pienso o 100g/mt) desde el día 1 hasta el día 35.
La adición de Natupulse® TS aumentó significativamente la digestibilidad ileal aparente (DIA) de la materia seca, la energía, la grasa y el nitrógeno (Figura 3).
TS
Figura 3. Natupulse® TS mejoró significativamente (*p<0.05; **p<0.01) la digestibilidad ileal aparente de la materia seca, energía, grasa y nitrógeno, comparado con la dieta control sin Natupulse® TS.
La DIA de todos los aminoácidos, excepto la metionina que se agregó como aminoácido sintético y ya tiene una alta digestibilidad, aumentó significativamente hasta +2,4% de media (Figura 4)
DIGESTIBILIDAD DE AMINOÁCIDOS [DÍA35]
TS
Figura 4. Natupulse® TS mejora significativamente (*p<0.05; **p<0.01) la digestibilidad ileal aparente de los aminoácidos, de media, un +2.4% comparado con la dieta control sin Natupulse® TS.
Aunque alimentar una dieta a base de maíz-soja no afecta significativamente la viscosidad de la digesta, Natupulse® TS logró reducir aún más la viscosidad. Mejorando la viscosidad, el mezclado de enzimas endógenas con sus sustratos incrementa, llevando a una mejor digestibilidad de nutrientes en el pienso como se muestra en el presente estudio.
CONCLUSIONES
Además, Natupulse® TS también aumentó la permeabilidad de la pared celular de la soja, permitiendo que las enzimas endógenas accedan mejor a sus sustratos y mejoren aún más la digestibilidad de los nutrientes.
Se sabe que aumentar la digestibilidad de los nutrientes mejora la eficiencia alimentaria. En este estudio, la suplementación con Natupulse® TS resultó en un aumento significativo en la ganancia diaria y el peso vivo final de los pollos que llegó a 2156 g versus 2071 g en el control a día 35.
Consecuentemente, el European Production Efficiency Factor (EPEF), mejoró significativamente de 384 a 411. Otro factor que posiblemente contribuyó al mejor rendimiento fue la liberación de manano-oligosacáridos (MOS) por la hidrólisis de los β-mananos de la dieta. Estos MOS pueden ser utilizados por algunas bacterias de la microflora intestinal para producir ácidos grasos de cadena corta, específicamente butirato.
Estos ácidos grasos de cadena corta son conocidos por tener un efecto beneficioso en la homeostasis intestinal y la literatura describe que el butirato afecta directamente al NF-κB, un regulador clave en la inflamación.
Esto podría significar que la energía y las proteínas no se desperdician en la respuesta inmune, sino que, además de la mayor digestibilidad, promueven un crecimiento óptimo de las aves.
Natupulse® TS tendió a mejorar el índice de conversión en el estudio, de 1,474 a 1,459. Por lo tanto, se necesita menos pienso y se puede reducir el coste por kilogramo de aumento de peso corporal, lo que conduce a una reducción general en los costes de producción.
Utilizando los precios promedio de las materias primas recolectados en España en septiembre de 2024 (harina de soja: 0,402 €/kg; maíz: 0,217 €/kg), el retorno de la inversión para Natupulse® TS en este ensayo fue de 19,63 €, considerando los precios actuales de las materias primas y un precio de pollo vivo de 1,42 €/kg.
En el pasado, se consideraba que la β-mananasa era más adecuada para dietas que contenían altos niveles de materias primas alternativas ricas en β-mananos, como harina de palmiste y harina de guar.
Sin embargo, este estudio demuestra que Natupulse® TS abre la posibilidad de utilizar más nutrientes también a partir de dietas basadas en harina de maíz y soja. También garantiza que los distintos niveles de beta mananos en las diferentes calidades de soja se equilibren y se alcance una alta eficiencia alimentaria en los pollos de engorde.
En la alimentación de broilers, Natupulse® TS mejora la eficiencia alimentaria, incluso en dietas basadas en maíz-soja, y genera un menor coste por tonelada de peso corporal ganado.
Así pues, la suplementación de Natupulse® TS puede ser una solución para hacer frente a las distintas calidades de la soja, reducir los costes de producción y mejorar la rentabilidad de la producción.

Natupulse TS: máxima estabilidad y eficiencia para el éxito
DESCÁRGALO EN PDF
Bibliografía disponible bajo solicitud.
técnico IFF

El mundo de la producción avícola está en constante cambio, adaptándose a las demandas del mercado y, por lo tanto, necesita estrategias de alimentación avanzadas y diseñadas para entornos de producción más actuales.
Investigaciones recientes apuntan a los beneficios significativos de adoptar un enfoque holístico, no sólo en términos de mejor uso de la energía, sino también en la mejora de la digestión de nutrientes, la salud intestinal y el rendimiento final.


La eliminación del uso de los antibióticos como promotores de crecimiento en la Comunidad Europea en los albores del siglo XXI, como consecuencia de un empleo desmedido de éstos, condujo a las empresas a buscar alternativas mediante el uso de otros aditivos, generalmente de forma asociada.
Son ya 18 años por tanto de utilización de muy diversos aditivos. Aún así, desde nuestro punto de vista, la propuesta desarrollada en este trabajo, engloba tres aspectos diferentes que afectan a los resultados cuando son considerados en conjunto.

Sin el uso, por tanto, tradicional de antibióticos en la alimentación como primera línea de defensa contra las enfermedades y como promotor de crecimiento, el animal es más susceptible y utilizará la energía disponible de forma poco eficiente.
De hecho, estudios concienzudos demuestran que, durante una respuesta inmunitaria importante, la energía que deja de ser empleada en el crecimiento puede ser estimada en un 25%. (Ver Fig. 1 ).

a,b P<0,05


Estos factores externos, cada vez más complejos, han redirigido la ciencia de la nutrición y alimentación animal de diferentes maneras; desde nuestro grupo, y considerando el aspecto holístico de una correcta producción animal, hemos decidido denominar “Nutribiosis” a nuestros enfoques actuales de investigación.
El objetivo de este estado de “Nutribiosis” es aportar una comprensión más completa y profunda de las interacciones entre los tres pilares que pensamos son claves: la nutrición, la función intestinal e inmunitaria y el microbioma residente en el animal.
Función intestinal
Microbioma Nutrición
Respuesta inmune

Menor consumo (anorexia) (75%)
Ineficacia digestiva (9%)
Ineficacia metabólica (8%)
Gasto energético (fiebre, 4%)
Inmunidad sistémica (4%)
1. Syncra AVI mejora el estado “nutribiótico”, resultando en una mejor eficacia energética.
Esto supone un cambio innovador en la forma de pensar de forma práctica, diferente a la más tradicional. En lugar de centrarnos en cada uno de los pilares por separado, “Nutribiosis” ofrece nuevas perspectivas. El objetivo es lograr el equilibrio óptimo para conseguir la mejor salud y rendimiento posible en los pollos; donde cada aspecto colabora para crear un “estado nutribiótico favorable”
Entonces, ¿Cómo se ve esto en la práctica? ¿Puede la selección de los aditivos adecuados, crear las condiciones óptimas en el tracto intestinal, para conseguir un mayor rendimiento?
Nuestras investigaciones sobre los efectos sinérgicos del aditivo para piensos, Syncra AVI, proporciona pruebas convincentes de que la forma de abordar la producción animal, “Nutribiosis”, es efectiva para liberar todo el potencial de los animales, incluso cuando los desafíos están presentes.
Combinando dos tecnologías probadas, Syncra AVI es conocido por favorecer el mantenimiento de la salud intestinal y maximizar el rendimiento en la producción avícola.
Su formulación única contiene un complejo enzimático de tres actividades, que mejoran la digestibilidad de los nutrientes y la uniformidad del lote, y un probiótico formulado para proteger contra los desafíos de salud y modular de forma adecuada la respuesta inmunitaria.
Visto a través de la lente de “Nutribiosis”, se puede ver que estos efectos positivos y medibles respaldan las condiciones deseadas en cada una de las tres áreas funcionales clave del tracto intestinal:

Nutrición
Los resultados de los ensayos demuestran que Syncra AVI mejora la digestibilidad y la absorción de nutrientes como el almidón, la grasa y las proteínas.
Estas mismas pruebas muestran un aumento significativo de la energía digestible ileal (EDI) con el uso del Syncra AVI, comparado con el uso de las enzimas y los probióticos de forma individual; son datos que demuestran una respuesta energética sinérgica cuando ambos productos se usan juntos.
Nuestros estudios también demuestran una mayor eficiencia energética de las aves alimentadas con Syncra AVI y mejora de la degradación de las fibras, que produce oligosacáridos procedentes de los arabinoxilanos de la dieta (AXOS), que pueden ser utilizados por la microbiota en el intestino como prebióticos.
1 2
Microbioma
Syncra AVI ha demostrado aumentar los niveles de poblaciones bacterianas beneficiosas, como Lactobacillus, mientras inhibe las bacterias no beneficiosas. Esto da lugar a una caída en los niveles de patógenos oportunistas, como los coliformes, que podrían causar problemas de salud intestinal en las condiciones adecuadas.
Los cambios en las poblaciones microbianas también tienen un efecto positivo sobre los patrones de fermentación, con un aumento de la producción de butirato, reconocido como fuente de energía para los enterocitos intestinales.
Como resultado, el microbioma se vuelve más diverso y equilibrado de manera que, bacterias beneficiosas son más numerosas que las no beneficiosas, y el potencial de patógenos oportunistas disminuye.
Todo ello ayuda a reducir posibles procesos de enfermedades subclínicas, y desafíos que de otro modo reducirían el rendimiento y la rentabilidad de las producciones.


También se observan efectos claros sobre las paredes intestinales donde Syncra AVI ha demostrado que mejora la integridad de éstas y su estructura, fortaleciendo la propia barrera intestinal y optimizando la absorción de nutrientes.
Además, mejorando la función inmune, demostrado en estudios tanto in vitro como en animales, que Syncra AVI ayuda a reducir el riesgo de respuestas inflamatorias exacerbadas, reduciendo el estrés fisiológico en el animal y los costes energéticos de esta situación de “desafío fisiológico”.

Por supuesto, lo que más importa desde una perspectiva empresarial, es cómo estas interacciones en el sistema digestivo impactan sobre el crecimiento y rendimientos del ave.

Además, un gran desafío intestinal, como es la enteritis necrótica (NE), causada por el patógeno oportunista Clostridium perfringens, puede provocar daños intestinales a través de la producción de toxinas. Controlar la respuesta inflamatoria

Considerando los múltiples desafíos a los que están expuestos los pollos en la actualidad, animales muy sensibles que pueden reaccionar de forma negativa, pensamos que Syncra AVI es una herramienta de enorme utilidad.
En un trabajo en el que se evaluó las conversiones calóricas en broilers, demostramos como el empleo de Syncra






En la Figura 2, los pollos sin ningún desafío (pero a los que se les añade Syncra AVI en la dieta) son capaces de transformar la energía ingerida en peso vivo de forma más eficaz.
Además, como cabe esperar, los animales sometidos a un desafío, muestran un gasto energético casi 8% superior a los controles y de nuevo, significativamente y casi en la misma magnitud de calorías, convierten mejor al recibir Syncra AVI.
Esto es probablemente debido a que la energía se desvía hacia la lucha contra el patógeno y lejos del crecimiento, en el caso de los pollos en condiciones extremas.

Es importante tener en cuenta que Syncra AVI es un ejemplo de cómo la tecnología ha avanzado y como los aditivos para piensos pueden influir positivamente en la nutrición, el microbioma y la función intestinal e inmune para crear un estado “Nutribiótico” favorable.
Esta evidencia añade más peso al argumento de que los aditivos para la salud intestinal deberían añadirse a los piensos para asegurar el equilibrio entre la nutrición, el sistema digestivo y el microbioma, por el bien de una salud intestinal y rendimiento óptimo.
Con esta información, los productores y nutricionistas pueden evaluar más plenamente los efectos sinérgicos de la estrategia elegida de alimentación y tomar mejores decisiones.
Mejoras en la sinergia de la eficiencia energética en aves DESCÁRGALO EN PDF

Equipo técnico Marvesa Oils and Fats

Con el aumento vertiginoso de los precios de los materias primas y las nuevas tensiones en el mercado de las grasas, existe una necesidad de nuevas materias primas que nos permitan ahorrar en el coste de formulación en todas las especias.
Un simple cambio del tipo de grasa puede tener un gran impacto en la calidad y el coste del pienso final.
Marvesa LECIFEED® es una mezcla cuidadosamente elaborada entre lecitina de soja, aceite vegetal y oleínas vegetales que permite tener los beneficios de las lecitinas sin los problemas de su manipulación.
Por un lado, las lecitinas comerciales han sido estudiadas durante los últimos años como sustituto de las grasas clásicas (aceite de soja fundamentalmente).

Ya en el 2012, en la revisión que se publicó en el XXVIII curso FEDNA bajo el título “Aceites resultantes de procesos industriales en piensos para monogástricos”, se determinó que no solo resultaban interesantes por su aporte de energía y su menor coste, sino también como aporte de fósforo, colina y otros nutrientes.
“Aceites resultantes de procesos industriales en piensos para monogástricos”

Marvesa ha desarrollado LECIFEED® como una alternativa al aceite de soja, con beneficios nutricionales adicionales. Además de energía

Debido a estos componentes, LECIFEED® también posee propiedades emulsionantes y antioxidantes, y actúa como mejorador de la granulación al contener GOMAS (fosfolípidos) que dotan de flexibilidad al gránulo, aumentando la durabilidad sin incrementar la dureza, que a menudo puede producir rechazos en el consumo.
Mientras que la lecitina cruda es conocida por su elevada viscosidad, que le hace muy difícil en su manipulación en fábrica, LECIFEED®, gracias a su cuidada mezcla de lecitinas, aceites vegetales y oleínas, es una solución líquida sencilla de manipular, disponible en la península ibérica y que permite disminuir el coste de formulación.
Como deriva 100% de productos de la soja, LECIFEED®, por tanto, tiene una composición de ácidos grasos similar a la del aceite de soja (incluido el nivel de linoleico).
LECIFEED® contiene una gran cantidad de lecitina, compuesta por fosfolípidos, que le confiere beneficios adicionales a los aceites comunes.

Fofatidil colina 120.000 mg/kg
Colina 18.500 mg/kg
Vitamina E 1.000 mg/kg
α T. acetate 260 mg/kg Lecitinas
1. Comparativa entre componentes de LECIFEED®, aceite de soja, aceite de palma, y grasa animal.
El grupo de fosfolípidos le da a LECIFEED® su característica especial ya que forma capas de ácidos grasos hidrofóbicos lo que aumenta la capacidad de romper las micelas (emulsificación).
En el tracto intestinal del animal, esto ayuda a descomponer la grasa en partículas más pequeñas, lo que hace que sea más fácil de digerir. De esta manera, el animal puede digerir más energía de la dieta mejorando el rendimiento técnico.
Estudios internos en varias especies animales mostraron una mayor digestibilidad de LECIFEED® que el aceite de soja y también un incremento de la digestibilidad de la grasa al incluir LECIFEED®.
1 : En los grupos de tratamiento, el 3,5% del aceite de soja fue reemplazado por LECIFEED.® En el grupo LECIFEED® 1:1 se trató de una sustitución 1 a 1 con un 3,5% de LECIFEED.® En el grupo LECIFEED® ISO, el aceite de soja se sustituyó isocalóricamente, con un 4% de LECIFEED.®
Tabla 2. Resultados zootécnicos Broilers con sustitución de aceite de soja 1:1 o isoenergética con LECIFEED®.
El efecto emulsionante de la lecitina por lo tanto, está incluido en el valor energético de LECIFEED®, que se calcula en un 92 % del del aceite de soja.
Sin embargo, nuestros ensayos han demostrado que LECIFEED® puede reemplazar por completo al aceite de soja en una proporción de 1:1.
Como sabemos el aceite de soja es una grasa altamente digestible con una alta cantidad de ácidos grasos insaturados, por esto, el efecto de la inclusión de LECIFEED® es incluso mayor frente a una fuente de grasa saturada, como el aceite de palma.
El inositol es otro compuesto que está presente en la fracción fosfolipídica de LECIFEED®
El inositol también juega un papel en las estructuras de la membrana citoplasmática y como transportador de los LDL en la sangre.
Una escasez de inositol puede provocar la acumulación de grasa en el hígado.

Además de energía, LECIFEED® aporta colina de forma natural al pienso. Se ha demostrado que la colina derivada de la lecitina tiene una mejor biodisponibilidad en el animal en comparación con aditivos como el


Por fín, y no por eso menos importante, la lecitina es una extraordinaria fuente de fósforo. El fósforo de la lecitina es altamente digerible (98%) por el animal.
La lecitina es también una fuente natural de vitamina E (tocoferoles) que elimina la necesidad de incorporar antioxidantes artificiales a nuestro LECIFEED®
LECIFEED® permite reducir el coste de la fórmula frente al aceite de soja y se puede incluir en niveles similares en la dieta sin ninguna reducción del rendimiento.
Además, LECIFEED® reduce la inclusión de fosfato (independientemente de la fuente) y de cloruro de colina . Lo que no sólo ahorra dinero si no que también libera espacio en la fórmula para otros compuestos nutricionalmente valiosos.

LECIFEED® es ligeramente más viscoso en comparación con el aceite de soja, con una viscosidad de 500 cP a 50 grados.

Por lo tanto, LECIFEED® requiere un tanque calorifugado para su almacenamiento, a una temperatura de 45-55 grados Celsius. Igualmente, se requieren tuberías completamente calorifugadas, de al menos 2 pulgadas para el transporte desde el tanque a la aplicación en mezcladora.
Si esto no es posible en su instalación, también podemos ofrecer LECIFEED® NC, un producto en polvo sobre un soporte natural (trigo o maíz).
Marvesa Oils and Fats es un empresa cuyo recorrido y profesionalidad es bien conocida en Países Bajos por sus mezclas de grasas de alta calidad durante las últimas décadas.
Marvesa posee años de conocimiento nutricional de las necesidades específicas del cliente para proporcionar aceites y grasas con beneficios adicionales para el rendimiento óptimo de los animales.

Ofrecemos una gama de productos en España y Portugal, entre los que, a partir de este año, se encuentra nuestro producto LECIFEED®
Para más información, le invitamos a ponerse en contacto con nuestro gerente de ventas, Thijs Adolfsen thijs.adolfsen@marvesa.com
LECIFEED®, una fuente de energía para ahorrar costes en fórmula, ya disponible en España y Portugal.

Adaptado de Lotte Stokvis et al., 2024* Departamento Técnico de Quimidroga SA.
La L-Metionina (L-Met) es la única fuente de metionina obtenida mediante procesos de biofermentación, a diferencia del resto de fuentes de metionina, que se obtienen mediante un proceso de síntesis química.
Recientemente, la evaluación del balance ecológico (Life-cycle Assessment, LCA) de la producción de L-Met ha mostrado un menor impacto sobre el calentamiento global que la obtención de DL-Met (Kim et al., 2024).
La L-Met se presenta como una opción más biodisponible en comparación con sus contrapartes químicas dado que el isómero L es directamente utilizable por el animal.
En cambio, otras fuentes de metionina, como la DL-Met o el DL-HMTBA, requieren de procesos enzimáticos que finalizan con la síntesis de L-Met (Fig. 1).
Un metaanálisis reciente de Asasi y coautores (2024) confirma la mayor biodisponibilidad de la L-Met frente a la L-Met en pollos de engorde de 0 a 21 días de edad, mejorando los parámetros productivos.
*Lotte Stokvis, Bart Matton & Behnam Saremi. 2024. Comparing inclusion of a new L-methionine (L-Met-eco 95%) in diluted form (85%) to a regular DL-Met in broilers raised under semi-commercial conditions. 113th PSA Annual Meeting. Book of Abstracts. Page 205.


D-HADH
Codi cado por el gen LDHD

Codi cado por el gen HA01
Con el objetivo de estudiar la mayor biodisponibilidad de la L-Met, se ha llevado a cabo un estudio en pollos de engorde. Para ello se han aplicado dos tratamientos:
Control (DL-Met): SID Met + Cys / SID Lys cumpliendo las recomendaciones de Ross 308 mediante la adición de DL-Met 99%.
Figura 1. Metabolismo de diferentes fuentes de metionina (Met) en la dieta. El isómero D-Met y el precursor de Met, DL-HMTBA, deben convertirse en L-Met para su utilización. Diferentes enzimas y cofactores desempeñan papeles en este proceso (adaptado de Zhang et al., 2018).

El estudio ha sido realizado por Schothorst Feed Research (Lelystad, Países Bajos).
Animales: 13.120 pollos de engorde Ross 308.
16 corrales de 820 pollos, 8 réplicas por tratamiento.
Dietas comerciales a base de maíz, trigo y soja.
Alimento y agua ad libitum.
Tratamiento (L-Met e): 15% menos de Met respecto al grupo Control, mediante la adición de L-Met e (95% L-metionina).
En las dietas (Tabla 1), el grupo Control se ha suplementado la DL-Met para alcanzar el 100% de los requerimientos en las fases de inicio, crecimiento y finalización. En el grupo tratamiento, la nueva L-Met e se ha adicionado considerando una eficacia un 15% superior para L-Met.
Tabla 1. Composición nutricional calculada de las dietas experimentales de iniciación (días 0-10), crecimiento (días 10-22) y acabado (días 22-37).
En la Tabla 2 se muestran los resultados productivos, mientras que en la Tabla 3 se describen las características de la canal.
Aunque en la fase de inicio la L-Met e condujo a un peso corporal (BW) seis gramos inferior que la DL-Met, durante la fase de crecimiento la diferencia entre tratamientos desaparece.
Cabe destacar que durante el crecimiento los pollos con DL-Met en la dieta mostraron una ingesta de agua superior y una ratio agua:pienso más alta que los animales del grupo L-Met e.
En la fase de acabado, los pollos de la dieta L-Met e fueron más pesados, con una diferencia de 33 g por ave de promedio.
De los 0 a los 37 d, los pollos alimentados con la dieta L-Met e alcanzaron un mayor peso vivo, redujeron la ingesta de agua y presentaron una menor ratio agua: pienso.
Asimismo, estos animales también depositaron más porcentaje de pechuga en comparación con las aves alimentadas con DL-Met y, aunque la diferencia no fue significativa, se registró una leve reducción en la grasa abdominal del grupo L-Met e.
Tabla 2. Rendimiento en la fase de inicio, en la fase de crecimiento y en la fase de acabado, y en todo el período del día 0 al 37: peso corporal (BW), ganancia de peso corporal (BWG), consumo de alimento (FI), consumo de agua (WI), ratio agua:pienso (W:F), índice de conversión alimenticia (FCR) y mortalidad.

a-b Las medias dentro de una columna sin un superíndice común son significativamente diferentes. SEM Error estándar de la media.
e
P-valor 0,65 0,63 0,57 0,028

a-b Las medias sin una letra superíndice común en una columna difieren significativamente (P ≤ 0,05).
SEM Error estándar de la media.
Tabla 3. Características de la canal en el día 36: peso de la canal, peso de la pierna (Muslo), peso de la grasa abdominal y peso de la Pechuga expresados como porcentaje del peso corporal (%BW).
Los resultados del estudio sobre la calidad de la cama, mostrados en la Figura 2, indican que la dieta L-Met mejoró la calidad de cama en el día 22, mientras que en el día 27 se iguala.
El estudio de la presencia de pododermatitis se expone en la Figura 3. Únicamente se observaron diferencias en el día 30, con mejores puntuaciones para las aves alimentadas con L-Met e. El impacto de un mayor consumo de agua no se detectó en edades posteriores.
Calidad 3
Calidad 2
Calidad 1
Calidad 0

Figura 2. Calidad de la cama en el día 22 (P = 0,011), presentada como valores predichos en % de corrales con una cierta puntuación dentro de un tratamiento, donde las puntuaciones más bajas indican una peor calidad de la cama.
Figura 3. Puntuaciones de pododermatitis en el día 30 (P < 0,001) y el día 35 (P = 0,871), expresadas como valores previstos en % de corrales con una determinada puntuación dentro de un tratamiento, donde las puntuaciones más bajas indican menos dermatitis.

del 15% para la L-Met en la fase de inicio resulte demasiado optimista, generando un ligero impacto en el crecimiento de los pollitos.
Sin embargo, el mayor rendimiento productivo reflejado al final de este estudio es superior a la bioeficiencia calculada para la L-Met.
El grupo Control (DL-Met) se alimentó cumpliendo las recomendaciones de Ross, así que una mejor absorción en el tracto gastrointestinal junto una a utilización directa de la L-Met, podrían explicar esta bioeficiencia superior a lo esperado.

Hay que considerar que el paso de DL-Met a L-Met no solo requiere el complejo D-aminoácido oxidasa, sino también de otros aminoácidos como la valina y la isoleucina, implicados en el proceso de transaminación (Gordon y Sizer, 1965).
La reducción en el consumo de agua del grupo L-Met e podría estar relacionado con una mayor utilización de nitrógeno o una menor liberación de amoníaco, debido a la desaminación de la D-Met a Keto-metionina y su excreción a través de la orina (Fig. 1).
La mejora en la calidad de la cama del día
Atribuir una biodisponibilidad un 15 % mayor a la L-Met e tiene un impacto positivo en los parámetros productivos y en las características de la canal de las aves. L-Met e es una fuente de metionina altamente eficiente y rentable en pollos de engorde.
Bibliografía disponible bajo petición.

L-metionina: una fuente de metionina altamente bioeficiente en pollos
DESCÁRGALO EN PDF

Aminoácidos de excelente calidad obtenidos mediante fermentación El único proveedor con 8 Aminoácidos para una ganadería e ciente y sostenible






Fernando Bacha Nacoop, S.A.
La primera parte de este contenido fue publicada en la edición septiembre de nutriNews España.

Una gran parte de los nutrientes absorbidos por el intestino de los rumiantes son modificados o utilizados durante la fermentación microbiana en el intestino delgado y también por los tejidos absorbentes del ternero antes de su liberación a la circulación.
Esto da como resultado una disminución en el suministro de energía y precursores de aminoácidos de una fuente de alimento determinada que están disponibles para los tejidos productivos.
Sin embargo, este uso de energía y aminoácidos no puede considerarse como una pérdida total ya que los tejidos intestinales absorbentes realizan un servicio vital para el resto del organismo. Por lo tanto, representa una disminución de la eficiencia productiva por unidad de energía alimenticia suministrada.
Por necesidad funcional, el intestino y el hígado están colocados anatómicamente para tener acceso a los nutrientes absorbidos antes que los tejidos periféricos. Por lo tanto, el metabolismo intestinal y el hepático determinan la disponibilidad de la mayoría de los nutrientes para el apoyo de las funciones productivas, por lo que son cruciales para la salud y el crecimiento.
De hecho, el sistema porta (el SP incluye: el tracto digestivo, el páncreas, el bazo y la grasa omental y la mesentérica) representa sólo del 8 al 10% de los tejidos corporales, pero gasta del 18 al 25% del O2 del animal, con un 25% adicional representado por el hígado.
Si bien una parte de la energía gastada por el epitelio intestinal está directamente asociada con el costo de absorber y transportar activamente nutrientes para su uso posterior, la mayor parte se utiliza para mantener la integridad y la masa de los tejidos. Estas funciones de mantenimiento de los órganos viscerales incluyen principalmente la actividad de Na+-K+-ATPasa, la síntesis y degradación de proteínas, y
Sin embargo, definir el costo real de los tejidos intestinales es complejo por el hecho de que su masa cambia en respuesta al plano de nutrición, la composición química de la dieta y el estado fisiológico del animal.


Si bien la mayor parte de las investigaciones se han centrado en el papel de la leche y los factores de crecimiento del calostro en el desarrollo intestinal neonatal de los rumiantes, hay escasez de datos que describan la respuesta intestinal y ruminal durante el destete.
La masa ruminal responde excepcionalmente al cambio en la forma de la dieta, lo que probablemente refleja el éxito de la derivación del sustituto de la leche más allá del rumen y la interrupción del establecimiento de una fermentación ruminal.
Aunque los cambios en la masa intestinal no son evidentes, la capacidad de asimilación de nutrientes puede verse afectada.
Esto sugiere que el crecimiento ruminal responde al suministro de sustrato energético, pero el crecimiento del tejido intestinal no.

Tomados en conjunto, estos datos muestran que el crecimiento intestinal no es simplemente una función del suministro de sustrato energético o de la composición química de la dieta, sino más bien a un conjunto de aportes nutricionales y fisiológicos.

A pesar de que el hígado neonatal y pre-rumiante representa un mayor porcentaje de peso corporal vacío que el del rumiante adulto, la fracción del uso de oxígeno de todo el cuerpo atribuida al hígado es considerablemente menor.
Esto nos deja claro que existe una menor actividad metabólica.
El aumento en la actividad metabólica hepática en la vida adulta del animal probablemente refleja los cambios en la cantidad y el tipo de sustratos metabolizados por el hígado, por ejemplo, glucosa y ácidos grasos frente a AGV, como consecuencia del desarrollo del rumen.
En los animales en desarrollo, la adaptación digestiva antes del destete de un pre-rumiante a un rumiante funcional coincide con un cambio de la glucosa absorbida principalmente por el intestino, los ácidos grasos de cadena larga y los aminoácidos derivados de la leche a AGV, cetonas, aminoácidos de fuentes microbianas y de piensos, y otros compuestos dietéticos.
En consecuencia, este cambio en el patrón y suministro de nutrientes de la dieta provoca alteraciones sustanciales en la función hepática y el reparto de energía que requieren procesos como la síntesis de glucosa y de proteínas, el mantenimiento de gradientes iónicos, el ciclo del ácido cítrico, de la urea y la desintoxicación de compuestos.
Para aclarar los mecanismos hepáticos implicados en este período de transición, la mayoría de las investigaciones han intentado determinar si el hígado pre-rumiante está totalmente adaptado a la llegada de cualquier producto procedente del intestino delgado o si experimenta un proceso de maduración propio en respuesta al desarrollo ruminal.

El mayor cambio en los principales procesos metabólicos durante el desarrollo ruminal es el cambio de un hígado glucolítico a glucogénico (Tabla 1).

Enzima Especie Pre-rumiante Rumiante adulto
Vía de las pentosas:
Glucosa-6-fosfato deshidrogenasa Bovino + -
6-Fosfoglucanato deshidrogenasa Bovino + -
Glicolisis:
Hexocinasa Ovino + -
Fructosa-1,6-bisfosfato aldolasa Bovino + -
Gliceraldehido 3-fosfato deshidrogenasa Bovino + -
Piruvato cinasa Ovino SC SC
Ciclo del ácido tricarboxílico:
Citrato sintasa Ovino SC SC
Malato deshidrogenasa Ovino SC SC
Gluconeogénesis:
Glucosa 6-fosfatasa Bovino - +
Fructosa-1,6-bisfosfato Ovino - +
Piruvato carboxilasa Ovino + -

Lactato deshidrogenasa Ovino + -
Metabolismo del glucógeno:
Glucógeno sintetasa Ovino + -
Glucógeno fosforilasa Ovino + -
Metabolismo de las cetonas:
β-hidroxibutirato deshidrogenasa Ovino - +
Acetil-CoA acetiltransferasa Ovino - +
Acetil-CoA sintetasa Ovino SC SC
1: (+) = Aumenta la actividad enzimática; (-) = Disminuye la actividad enzimática; (SC) = Sin cambio la actividad enzimática
Modificado de: Baldwin, R.L.; 2004; J. Dairy Sci. 87:(E. Suppl.) E55-E65
Tabla 1. Cambios en la actividad enzimática hepática con el cambio en las prioridades metabólicas asociadas al desarrollo ruminal.
Como ya hemos visto, a medida que aumenta la fermentación microbiana, hay menos carbohidratos disponibles para la digestión post ruminal, y el suministro dietético de glucosa disminuye.
Existe una reducción básica en la capacidad enzimática para la oxidación de la glucosa hepática. El tejido hepático deberá soportar el aumento de las necesidades de glucosa del animal, al mismo tiempo que una disminución en la glucólisis.
Esto da como resultado un rápido aumento de la actividad gluconeogénica hepática al mismo tiempo que el desarrollo ruminal.

Se ha demostrado que la actividad de la glucosa 6-fosfatasa se duplica (o más) durante el período del destete.
Los pre-rumiantes pueden convertir el lactato o el propionato en glucosa. La inhibición de la gluconeogénesis del lactato en los rumiantes adultos es probablemente el resultado de una mayor disponibilidad de propionato.
El cambio, en el metabolismo hepático hasta convertirse en gluconeogénico puede ser una respuesta al desarrollo del rumen funcional que genera un suministro continuo de sustrato glucogénico en forma de propionato.
Las diferencias en el suministro de nutrientes portales de pre-rumiante y rumiantes al hígado, también modifican la regulación hormonal de la función hepática.
A medida que avanza el desarrollo ruminal, hay una disminución de la sensibilidad de la gluconeogénesis hepática en respuesta a altas concentraciones de insulina y glucagón.
En hepatocitos aislados de pre-rumiante, el glucagón aumenta efectivamente la gluconeogénesis a partir de propionato y lactato, pero no tuvo ningún efecto sobre los hepatocitos de rumiantes adultos.
Las reservas hepáticas de glucógeno del pre-rumiante suelen igualar o superar los niveles de los adultos. Sin embargo, un ayuno corto de 16 horas resulta en el consumo de casi todo el glucógeno hepático, mientras que ayunos similares tuvieron poco efecto sobre el glucógeno hepático en adultos.
Una vez más, debido a que el pre-rumiante experimenta cambios muy enérgicos de patrones postprandiales de entrega de nutrientes, es necesario un amplio control hormonal de la gluconeogénesis hepática. El rumiante funcional recibe en el hígado un suministro más continuo de sustratos glucogénicos y es un productor constante de glucosa; por lo tanto, requiere menos control hormonal.

Una de las características principales del intestino delgado funcional en animales no preñados y no lactantes, es la producción ruminal de cetonas.
En un rumiante adulto no preñado y no lactante, es el intestino delgado el principal productor de cetonas, mientras que el intestino delgado del pre-rumiante produce cantidades insignificantes de cetonas.
Esto se debe a la ausencia de fermentación microbiana; en consecuencia, el hígado es el sitio principal de la cetogénesis.
En el caso de ayunos prolongados, el pre-rumiante es capaz de realizar la cetogénesis hepática casi desde el momento del nacimiento, pero no se realiza habitualmente. El desarrollo del rumen tiene un impacto claro e importante y se han realizado varios estudios para dilucidar los mecanismos que controlan la diferenciación ruminal y a pesar del esfuerzo todavía no se comprenden satisfactoriamente.
Procesos fisiológicos alrededor del destete de los rumiantes (Parte II)
DESCÁRGALO EN PDF
No hay suficiente evidencia para decidir cuál de ellos es el más importante: si es el control ontogénico o bien son los factores nutricionales y endocrinos los reguladores de este importante momento. Pareciera ser la combinación de todos ellos.
Aquí muy probablemente esté la respuesta al por qué en la práctica hay algunos aditivos que funcionan en algunas ocasiones, y en otras no.
Más claro está que el desarrollo intestinal ocurre durante el período fetal y perinatal siendo un control ontogénico casi en su totalidad, aunque, la capacidad de transporte de nutrientes cambia, ya que el animal pre-rumiante se convierte en rumiante como resultado de los nutrientes específicos suministrados.
En el rumiante en crecimiento, los efectos dietéticos, es decir la ingesta sobre la masa ruminal e intestinal, alteran claramente las necesidades de proteínas y de energía de mantenimiento. Estos cambios en la masa intestinal afectan a las capacidades digestivas y de absorción.
Los cambios fundamentales en las vías metabólicas ocurren en el hígado como consecuencia del desarrollo del rumen, y pueden ser responsables del aumento de las necesidades energéticas asociados con la función hepática de los rumiantes maduros en comparación con el hígado de los pre-rumiantes.
Equipo técnico AMBiotec
En el competitivo mundo de la ganadería, la calidad del producto final es un factor determinante para el éxito. Esta calidad no solo se mide en términos de rendimiento, sino que abarca un espectro complejo de características que satisfacen tanto a productores como a consumidores, como es la calidad de la carne.
En este contexto, la alimentación juega un papel crucial, y las dietas ricas en almidón han demostrado ser una herramienta fundamental para lograrlo.


El almidón, principal fuente de energía en los piensos concentrados, es esencial en los procesos metabólicos del ganado bovino. Esta molécula influye en la bioquímica muscular, la composición de la carne y los rendimientos productivos, proporcionando un impacto en la producción de carne de alta calidad.
El almidón es un componente fundamental en la alimentación de los rumiantes, proporcionando la energía necesaria para diversos procesos metabólicos. Las dietas ricas en almidón ofrecen múltiples beneficios:
En la industria ganadera moderna, la búsqueda de estrategias para mejorar la calidad de la carne y la eficiencia productiva es constante.
Este artículo examina cómo las dietas ricas en almidón, especialmente aquellas con almidones de degradación lenta, pueden optimizar la producción de proteína microbiana ruminal y, en consecuencia, mejorar la calidad de la carne bovina.
Reserva de glucógeno y pH de la carne: Una de las ventajas más significativas de las dietas ricas en almidón es su capacidad para aumentar las reservas de glucógeno muscular.
Este aspecto es crucial en el proceso post-mortem de transformación del músculo en carne. La evolución post-mortem del pH está caracterizada por la rapidez y la cuantía de su disminución, siendo directamente proporcional a la actividad de hidrólisis del ATP.
El glucógeno muscular se convierte en ácido láctico, lo que provoca una caída controlada del pH. Una disminución gradual del pH resulta en una mejor capacidad de retención de agua y color de la carne, factores esenciales para la calidad del producto final.
Síntesis de proteína microbiana: Las dietas ricas en almidón, especialmente aquellas con almidones de degradación lenta, favorecen la síntesis de proteína microbiana en el rumen Esta proteína es de alta calidad y más asimilable para el animal que las proteínas de origen vegetal presentes en la dieta.
Eficiencia energética: El almidón proporciona una fuente de energía altamente digestible y eficiente. Su utilización post-ruminal puede mejorar significativamente su valor energético en comparación con la fermentación ruminal, traduciéndose en una mejor conversión alimenticia y tasas de crecimiento más rápidas.


La proteína microbiana producida en el rumen es fundamental para la nutrición de los rumiantes. Esta proteína puede constituir entre el 70 y 100% del nitrógeno disponible en las partes bajas del tracto digestivo en animales que consumen dietas fibrosas. Las ventajas de la proteína microbiana incluyen:

SOSTENIBILIDAD:
La maximización de la producción de proteína microbiana en el rumen reduce la dependencia de fuentes de proteína externa, mejorando la sostenibilidad y rentabilidad de la producción ganadera.
CALIDAD NUTRICIONAL
SUPERIOR: La proteína microbiana tiene una composición de aminoácidos más equilibrada y similar a las necesidades del animal que las proteínas vegetales de la dieta.
Por ejemplo, la carne bovina, rica en proteína de alta calidad, contiene entre 20,3 y 29,6 gramos de proteína por 100 gramos, reflejando la eficiencia de la síntesis de proteína microbiana
EFICIENCIA DE UTILIZACIÓN:
La proteína microbiana es más eficientemente utilizada por el animal, reduciendo la necesidad de suplementación con fuentes de proteína no degradable en el rumen.

Para maximizar la síntesis de proteína microbiana, es crucial considerar los siguientes factores:
Almidones de degradación lenta: Los almidones de degradación lenta, como el maíz, proporcionan una fuente de energía más constante para los microorganismos ruminales. Esto favorece un ambiente ruminal más estable y una síntesis de proteína microbiana más eficiente.
Balance energía-proteína: La sincronización entre la disponibilidad de energía y nitrógeno en el rumen es fundamental para maximizar la síntesis de proteína microbiana.
Tamaño de partícula: Al aumentar el tamaño de partícula en dietas de piensos concentrados energéticos, se incrementa la eficiencia de síntesis microbiana.
Esto se debe a que se mejoran las condiciones ruminales al incrementar los procesos de rumiación y salivación
Además, la fermentación en el rumen de las bacterias se lleva a cabo de manera más lenta, por lo que la formación de ácidos grasos es más progresiva y se disminuye el riesgo de acidosis.


La optimización de las dietas con un alto valor energético y la consiguiente mejora en la síntesis de proteína microbiana tienen un impacto directo en la calidad de la carne:
La carne de animales alimentados con este tipo de dietas tiende a tener un mejor perfil nutricional. Por ejemplo, es más rica en vitaminas del complejo B y minerales esenciales, reflejando la eficiencia de la nutrición basada en proteína microbiana.
Las dietas ricas en almidón promueven la deposición de grasa intramuscular o marmoleo, mejorando la terneza y jugosidad de la carne. El contenido de grasa en la carne de vacuno puede variar entre 2,9 y 9,9 gramos por 100 gramos, dependiendo del manejo nutricional y otros factores como la raza, el sexo, edad, etc.
COLOR Y ESTABILIDAD:
El nivel adecuado de glucógeno muscular, derivado del almidón dietético, asegura una caída óptima del pH post-mortem, resultando en un color más atractivo y estable. Esto es crucial para la aceptación del consumidor, ya que el color es uno de los atributos más importantes en la decisión de compra.
Las carnes PSE (Pale, Soft, Exudatives) y DFD (Dark, Firm, Dry) son los principales problemas de calidad en la industria cárnica. Las carne de ganado vacuno con valores de pH último superior a 5,8 cuando se mide a las 24 o 48 h post mortem, tienen características de procesamiento pobres: color más oscuro, grandes variaciones en la terneza, alta capacidad de retención de agua y un alto potencial de crecimiento microbiano a un tiempo de almacenamiento corto, en comparación con la carne de calidad.

Anoxia en tejidos musculares
Glucosis anaerobia
Glucosa 2 ATP
Oxidación Lactato dshidrogenasa 4 ADP 4 ATP NADH NAD+
Ácido pirúvico
Ácido láctido
pH muscular dentro de las primeras 24 horas
Acidi cicación muscular pH normal en músculo de mamíferos 7,0-7,5
Una de las razones de estos valores altos de pH se deben a una escasa reserva de glucógeno muscular provocado por dietas bajas en almidones.
Al diseñar dietas ricas en almidón para optimizar la producción de proteína microbiana y la calidad de la carne, se deben considerar los siguientes aspectos:
Selección de fuentes de almidón: Optar por fuentes de almidón de calidad y usar correctores vitamínico-minerales con núcleos capaces de formular ricas en almidones sin generar riesgos de acidosis en los animales como son los diseñados en AMBiotec.
Las dietas ricas en almidón, especialmente aquellas con almidones, ofrecen una estrategia poderosa para mejorar la calidad de la carne de vacuno a través de la optimización de la síntesis de proteína microbiana ruminal.
Al proporcionar una fuente de energía estable y eficiente, estas dietas no solo mejoran la eficiencia productiva, sino que también influyen positivamente en parámetros clave de calidad cárnica como el pH final, la terneza, el color, el perfil nutricional y la vida útil de las canales.

Nivel de inclusión:
Se recomienda un nivel de almidones superior al 49% en la dieta. Sin embargo, es crucial equilibrar esto con suficiente fibra para mantener la salud ruminal.
Procesamiento del grano: El método de procesamiento de los granos afecta la degradabilidad del almidón. Optando por piensos en harina grasera o piensos granulados de excelente calidad para disminuir el porcentaje de finos.
La implementación cuidadosa de estas estrategias nutricionales, considerando factores como el tipo, procesamiento y calidad de la fuente de almidones, el balance con otros nutrientes y la salud ruminal, permite a los productores mejorar significativamente la calidad de su producto final.
Esto no solo satisface las demandas de un mercado cada vez más exigente en términos de calidad cárnica, sino que también contribuye a la sostenibilidad y rentabilidad de la producción ganadera.
En última instancia, el enfoque en dietas ricas en almidón para maximizar la producción de proteína microbiana representa un paradigma en la nutrición bovina moderna, alineando los objetivos de eficiencia productiva con la producción de carne de alta calidad.
DESCÁRGALO EN PDF

AMBOMBA TERNEROS 0,75% Micox Cocci
Pienso complementario vitamínico-mineral
Los piensos complementarios vitamínicosminerales de AMBiotec nos permiten realizar formulaciones de piensos altos en energía, mejorando así los rendimientos en el ganado y obteniendo calidades de carne premium. En AMBiotec realizamos fórmulas nutricionales sencillas con materias primas de calidad que, junto con nuestros correctores vitamínicosminerales como AMBomba Terneros 0.75% Micox Cocci, cubren todas las necesidades nutricionales de los animales.
Agroalimentaria Manchega de Biotecnología, S.L.
C/ Río Montiña, 5
Pol. Ind. Sta. Mª de Benquerencia
45007 Toledo (España)
Teléfono: 925 672 642
info@ambiotecsolutions.com
www.ambiotecsolutions.com



La vitamina A (retinol) juega un papel crucial en el mantenimiento de la longevidad y el bienestar de los animales de compañía. Este micronutriente esencial tiene un impacto en diversas funciones fisiológicas, desde la visión hasta la regulación del sistema inmunológico.
A medida que los propietarios de mascotas se centran cada vez más en la nutrición óptima para sus compañeros peludos, comprender la importancia de la vitamina A en su bienestar se ha vuelto más crítico que nunca.


El papel multifacético de la vitamina A en el bienestar de las mascotas es amplio. La vitamina A es una vitamina liposoluble que cumple numerosas funciones vitales en perros y gatos. Sus roles principales incluyen el apoyo a la visión, la función inmunológica, el crecimiento, la diferenciación celular y la salud reproductiva (Tabla 1).
Molécula de Vitamina A
Ésteres de retinilo
Retinal
Ácido Retinoico
Función
Transporte y almacenaje

Ciclo visual
Crecimiento y diferenciación celular, regulación de la respuesta inmunológica, protección contra el daño oxidativo, desarrollo reproductivo y fetal, fortaleza ósea y formación del desarrollo (morfogénesis)
Tabla 1. Funciones de las diferentes formas de vitamina A en las mascotas (Shastak et al., 2024).
En la visión, la vitamina A es esencial para el funcionamiento adecuado de los fotorreceptores en la retina. Ayuda a mantener la salud de la córnea y las membranas conjuntivales, previniendo la ceguera nocturna y otros problemas relacionados con la visión.
Para la función inmunológica, la vitamina A mejora la actividad de las células T, B y asesinas naturales (NK), fortaleciendo la defensa del cuerpo contra patógenos. Debido a su papel vital en el apoyo al sistema inmunológico, la vitamina A se la conoce como la “vitamina antiinfecciosa”.
Ya en 1926, la investigación basada en una revisión exhaustiva de 330 autopsias de perros encontró una fuerte correlación entre la deficiencia de vitamina A y la bronconeumonía causada por infecciones bacterianas pulmonares, con una mayor incidencia observada en perros con niveles insuficientes de retinol (Mellanby, 1926).



El crecimiento y desarrollo de las mascotas está significativamente influenciado por la vitamina A. Esta vitamina regula la expresión génica, promoviendo una adecuada diferenciación celular y morfogénesis. Además, la vitamina A apoya la salud reproductiva tanto en animales machos como en hembras, influyendo en la fertilidad y el desarrollo embrionario.
Las propiedades antioxidantes de la vitamina A contribuyen a la salud celular general al neutralizar los radicales libres dañinos. Esta acción ayuda a proteger contra el estrés oxidativo, que está implicado en diversas enfermedades crónicas y procesos de envejecimiento.
En particular, muchos de los genes que ayudan a mantener el equilibrio de los antioxidantes en las células del cuerpo están controlados por la vitamina A y sus formas activas.
La deficiencia de vitamina A puede resultar en problemas como visión deteriorada, función inmunológica debilitada y mala calidad de pelaje. Además, puede causar problemas reproductivos en animales de cría y anomalías en el desarrollo fetal y las etapas tempranas de crecimiento.
A medida que empeora la deficiencia de vitamina A, los síntomas neurológicos comunes en las mascotas pueden incluir:
Confusión
Convulsiones
Movimientos oculares incontrolados (nistagmo)
Mala coordinación (ataxia)
Columna vertebral curva (cifosis)
Mayor sensibilidad al tacto (hiperestesia)

Pérdida de masa muscular y daños nerviosos
Las mascotas tienen una mayor tolerancia a la hipervitaminosis A (exceso de vitamina A) en comparación con otros animales domésticos, debido a varios factores. En primer lugar, transportan principalmente vitamina A en su sangre como ésteres de retinilo, lo cual en la mayoría de los mamíferos indicaría un exceso, pero no representa el mismo riesgo en carnívoros.
Además, ambas especies pueden eliminar eficientemente el exceso de vitamina A a través de la orina, siendo los perros más capaces que los gatos. Este mecanismo de excreción permite que el exceso de vitamina A solo ocurra con niveles de ingesta extremadamente altos durante períodos prolongados.
Esta capacidad de eliminar rápidamente el exceso de vitamina A puede ser una adaptación evolutiva que permite a los carnívoros consumir de manera segura grandes cantidades de alimentos ricos en vitamina A, como el hígado, en estado salvaje.

Palmitato/ oleato de retinilo
Perros
0,44±0,55 µg/mL 0,22±0,04 µg/mL
0,006±0,008 µg/mL 0,21±0,39 µg/mL
Raila et al. (2000)
0,6±0,4 mg/L No indicado No indicado No indicado Kolb (1999)
580 ng/mL No medido No medido No medido Schweigert et al. (2002)
Gatos 22±21,0 ng/mL No detectado 15±13,6 ng/mL 9±7,6 ng/ mL/11±17,5 ng/mL
Raila et al. (2001)
131 µg/dL No indicado No indicado No indicado Kolb (1999)
*La referencias específicas se detallan en la publicación original (Shastak et al., 2024)
Tabla 2. Concentraciones de retinol y ésteres de retinilo en la orina de gatos y perros domésticos (media ± desviación estándar).
Referencia*
NASEM (2006)
Morris et al. (2012)
Perros Gatos
Cachorros y reproductoras: 50,000 UI/kg dieta
Adulto: 210.000 UI/kg dieta
330.000 UI/kg dieta
100.000 UI/1000 kcal de dieta -
UI/kg dieta (DM basis)
UI/kg dieta (DM basis) FEDIAF (2021) 400.000 UI/kg dieta (DM basis)
*La referencias específicas se detallan en la publicación original (Shastak et al., 2024). DM = Materia Seca
Adulto y crecimiento: 400.000 UI/kg dieta (DM basis)
Reproducción: 333.333 UI/kg dieta (DM basis)
Tabla 3. Niveles máximos seguros de Vitamina A en perros y gatos de acuerdo con diferentes fuentes.
La interacción de la vitamina A con otros micronutrientes agrega otra capa de complejidad a su papel en la nutrición de las mascotas.
Por ejemplo, la vitamina A y la vitamina D trabajan juntas para regular las respuestas inmunitarias, mientras que la vitamina A y la vitamina E tienen efectos sinérgicos antioxidantes.
Además, administrar vitamina A y vitamina C a los mamíferos antes o después de que experimenten estrés puede aumentar significativamente la actividad de importantes enzimas antioxidantes.
Por último, el zinc y la vitamina A interactúan sinérgicamente, con el zinc mejorando el metabolismo, la absorción y la utilización de la vitamina A al ayudar en su transporte y conversión, mientras que la vitamina A mejora la absorción y utilización de zinc, lo que demuestra que las deficiencias en uno pueden afectar la efectividad del otro. Comprender estas interacciones es vital para formular dietas y suplementos equilibrados para mascotas.

DE LA VITAMINA

Los factores ambientales pueden afectar significativamente la estabilidad de las vitaminas. La oxidación, la exposición a la luz, la humedad, la temperatura, los minerales (cobre, zinc y hierro) y la peroxidación de lípidos influyen principalmente en la estabilidad de la vitamina A.
Por lo tanto, es crucial comprender las tasas de retención de vitaminas en todo el proceso de fabricación de alimentos hasta la etapa final de consumo.
Esta información es de suma importancia para la industria, ya que les permite compensar cualquier pérdida potencial durante el procesamiento y almacenamiento. En un estudio comercial reciente utilizando Lutavit® A1000 NXT, los niveles de vitamina A medidos en puntos críticos durante la fabricación de alimentos para mascotas se presentan en la Figura 1 (Galli et al., 2024)

Las mayores pérdidas de vitamina A en los procesos de fabricación de alimentos para mascotas ocurren durante la etapa de preacondicionamiento y la etapa de extrusión/ secado, alcanzando el 30% después del paso de secado en este estudio, que logró alcanzar el objetivo de concentración de vitamina A de 12.000 UI/kg en el producto final.
Las pérdidas de vitamina A durante la producción de alimentos para mascotas por parte de los clientes fueron significativamente menores en comparación con un ensayo anterior con otra Vitamina A1000. Además, cabe señalar que no hubo pérdidas significativas de vitamina A durante el almacenamiento de premezclas con Lutavit® A 1000 NXT (Galli et al., 2024).
Figura 1. Los valores corresponden a n=5 análisis por tratamiento. Configuración de la planta: mezclador horizontal con cintas helicoidales, capacidad de 2 t/h; molino de martillos con tamices de 2 mm, capacidad de 4 t/h; molino de martillos previo a la extrusión con tamices de 0.8 mm; acondicionador con dosificación gravimétrica, inyección de vapor y agua, sin presión, 90 ºC, 90 s; extrusora de tornillo simple, temperatura de salida del tornillo 90-100°C; secador de doble paso horizontal, temperatura de secado hasta 120°C, tamices y capacidad de 6 t.
La historia de la vitamina A en la nutrición de mascotas se remonta al principio del siglo XX, cuando los investigadores reconocieron por primera vez su importancia en la salud animal. Desde entonces, nuestra comprensión del papel de la vitamina A ha aumentado significativamente, lo que ha llevado a recomendaciones dietéticas más adaptadas para animales de compañía.

Las pautas nutricionales actuales para perros y gatos, como las proporcionadas por AAFCO (Association of American Feed Control Officials) y FEDIAF (European Pet Food Industry Federation), ofrecen recomendaciones mínimas específicas para la ingesta de vitamina A. Estas pautas tienen en cuenta factores como la etapa de vida, el tamaño de la raza y el estado fisiológico.

Investigaciones recientes se han centrado en las posibles aplicaciones terapéuticas de la vitamina A en la salud de las mascotas.
Por ejemplo, estudios en mamíferos han profundizado en el impacto de la suplementación con vitamina A en el manejo de condiciones de salud específicas, incluyendo problemas dermatológicos, trastornos oculares y enfermedades mediadas por el sistema inmunológico.
A medida que nuestra comprensión del papel de la vitamina A en el bienestar de las mascotas continúa evolucionando, hay varias áreas que merecen una mayor investigación.
Estas incluyen:
Los niveles óptimos de suplementación de vitamina A para diferentes razas y etapas de vida.
Los efectos a largo plazo de diversas fuentes dietéticas de vitamina A.
El potencial de terapias dirigidas con vitamina A para condiciones de salud específicas en mascotas.

monitoreen los niveles de vitamina A en las mascotas y cómo estos niveles se relacionan con diversos resultados de salud.
En conclusión, la vitamina A sigue siendo un pilar fundamental de la nutrición y el bienestar de las mascotas. Sus diversas funciones en el mantenimiento de la visión, el apoyo a la función inmunológica y la promoción del crecimiento y desarrollo destacan su importancia en la salud de los animales de compañía.
A medida que avanza la investigación, una comprensión matizada de las funciones de la vitamina A y los niveles de ingesta óptimos seguirá dando forma a las estrategias de nutrición, contribuyendo a la salud y el bienestar a largo plazo de nuestras queridas mascotas.
Mascotas y Vitamina A: conocimientos esenciales para el bienestar de los animales de compañía
DESCÁRGALO EN PDF
Este artículo se basa en las publicaciones
Shastak Y, Pelletier W. Pet Wellness and Vitamin A: A Narrative Overview. Animals. 2024; 14(7):1000. doi.org/10.3390/ani14071000
Galli GM, Andretta I, Martinez N, Wernick B, Shastak Y, Gordillo A, Gobi J. Stability of vitamin A at critical points in pet-feed manufacturing and during premix storage. Front Vet Sci. 2024; 11:1309754. doi: 10.3389/ fvets.2024.1309754.
Si lo desea, puede solicitar más referencias.


A medida que crece la demanda de animales criados de manera más sostenible, también lo hace el rendimiento de nuestros ingredientes eficientes de máxima calidad.
Vitaminas
Carotenoides
Enzimas
Ácidos orgánicos
Aditivos anti-micotoxinas
Glicinatos
Monoglicéridos



Según los últimos datos del Boletín JRC
MARS sobre el seguimiento de los cultivos en Europa, se constataría un empeoramiento de las condiciones en la parte central y oriental, mientras que habrían mejorado en las regiones occidentales. Las temperaturas muy altas en el centro-sur y el este de Europa habrían afectado negativamente y habrían acortado el período de maduración de los cultivos de verano.
En grandes partes de Rumanía, Bulgaria, Hungría, Eslovaquia y Austria, estos impactos se vieron agravados por un déficit de lluvia persistente. Mientras tanto, también habría continuado y se habría expandido un déficit de lluvia inusual y duradero en el este de Ucrania, el sur de Rusia y Bielorrusia, con impactos negativos en la maduración de los cultivos de verano, en particular el maíz y el girasol.
También se habrían observado condiciones secas que reducirían el potencial de rendimiento del maíz en Polonia, el noreste de Alemania y Lituania. Sin embargo, los últimos impactos de tormentas intensas e inundaciones prolongadas aún no se reflejarían en los resultados de este boletín.


Las previsiones de rendimiento quedarían de la siguiente manera: cebada de primavera con 4,4 t/ha (-1% interanual, +8% media quinquenal), maíz con 6,84 t/ha (-3%, y -7%), girasol con 1,98 t/ha (-3% y -8%) y soja con 2,81 t/ha (+2% y +3%).

Según datos del Ministerio de Política
Agraria, hasta mediados de septiembre se habrían recolectado cereales y leguminosas en Ucrania de una superficie total de 7,22 Mha, cifra que supondría el 65% de la superficie prevista.

En concreto, la cosecha total se estimaría en 30 Mt, mientras que según los datos recopilados del año pasado sólo se habrían obtenido 29,4 Mt de cereales. Por cultivos, en el país se habrían cosechado 1,1 Mt de maíz (255.300 hectáreas), 110.430 toneladas de mijo (56.800 ha), 2,95 Mt de girasol (1,5 Mha), 3,41 Mt de colza (1,26 Mha) y 1,84 Mt de soja (909.500 ha)


La producción de cereales en la cosecha 2023/24 en Brasil se estima en 298,41 Mt, cifra que supondría una reducción de 21,4 Mt en relación al volumen obtenido en el ciclo anterior según datos publicados por la CONAB (Compañía Nacional de Abastecimiento).
Esta disminución se debería principalmente al retraso en la regularización de las lluvias en el inicio de la siembra, combinada con las escasas precipitaciones durante parte del ciclo de cultivo en diversos estados. Así, el área sembrada en el ciclo 2023/24 se estima en 79,82 Mha, un incremento del 1,6% (1,27 Mha) respecto al 2022/23.
Además, la productividad media de los cultivos mostraría una disminución del 8,2% interanual, pasando de los 4.072 kilos por hectárea de la temporada pasada a los 3.739 kilos por hectárea del ciclo actual. Entre los cultivos afectados por el clima adverso destacaría la soja, con un volumen esperado de 147,38 Mt, una reducción de 7,23 Mt respecto al período 2022/23.

Según datos del Departamento de Agricultura de los EEUU (USDA), durante la campaña comercial 2024/25 y a causa de unas condiciones meteorológicas extremadamente secas entre julio y agosto, se estima una reducción de los cultivos de oleaginosas en Bulgaria.
Así, teniendo en cuenta una superficie sembrada de 70.000 hectáreas (-12%), se espera que la producción de colza alcance las 190.000 toneladas (-9% interanual), cifra que estaría un 36% por debajo de la de hace 2 años.
Mientras tanto, la cosecha de girasol podría situarse en 1,7 Mt (-4%) y un 21% menos respecto al ciclo 2022/23, pudiendo ser la menor de los últimos 10 años pese a haber plantado un 7,1% más que en la campaña anterior con 922.000 hectáreas.
Se prevé que estos hechos se traduzcan en este país en un déficit de semillas oleaginosas y una probable disminución de su exportación y trituración.
La caída observada se debería principalmente al retraso en el inicio de las precipitaciones, junto a una escasez de las mismas y altas temperaturas en las zonas sembradas entre los meses de septiembre y noviembre.
Sólo en el Mato Grosso, principal estado productor de semillas oleaginosas, la producción sería de 39,34 Mt, una caída del 11,9% en comparación con la primera encuesta o del 15,7% respecto a la última cosecha.


Se espera que mejoras significativas en las condiciones en las principales regiones de cultivo de las praderas canadienses aumenten la producción de trigo del país un 11% durante la campaña 2024/25.

La previsión de producción mundial de harina de soja de la campaña 2024/25 aumentaría 1,7 Mt hasta un récord de 269 Mt, según datos de Oil World (10,8 Mt más que la temporada anterior).
Según un informe del Servicio de Agricultura
Exterior (FAS) del Departamento de Agricultura de EE.UU., la producción se estima en 35,5 Mt, en comparación con los 31,9 Mt del ciclo 2023/24. Una mejora en la humedad, las condiciones en las zonas de Saskatchewan y Alberta serían mejores que las medias históricas.
El porcentaje de superficie de trigo de primavera que se encontraría en condiciones de buenas a excelentes habría aumentado 39 puntos porcentuales en Saskatchewan y 32 puntos porcentuales en Alberta respecto al ciclo anterior.
De esta forma se espera que las exportaciones totales de trigo puedan alcanzar los 24 Mt durante la campaña 2023/24, equivalente a un 68% del total de la oferta interna.
Con estos datos Canadá se convertiría en el tercer exportador mundial de trigo, después de Rusia y la UE. Además, se espera que las exportaciones puedan incrementarse hasta 25,7 Mt durante el ciclo 2024/25.
Así, a pesar del incremento de la producción de harina de soja del ciclo 2024/25, la producción de otras 7 harinas de semillas oleaginosas disminuiría al menos 1,4 Mt.
Anteriormente, se había previsto que los países de la UE aumentarían la producción de harina de soja en la nueva campaña 2024/25 debido a un crecimiento de la cosecha.
Cabe destacar que para el ciclo 2023/24, las importaciones de la UE de harina de soja habrían sido las más bajas de los últimos 5 años, y casi 1 Mt menos que la temporada anterior.

Materias primas DESCÁRGALO EN PDF




“Tabla de Fitogénicos” PON EN GOOGLE
